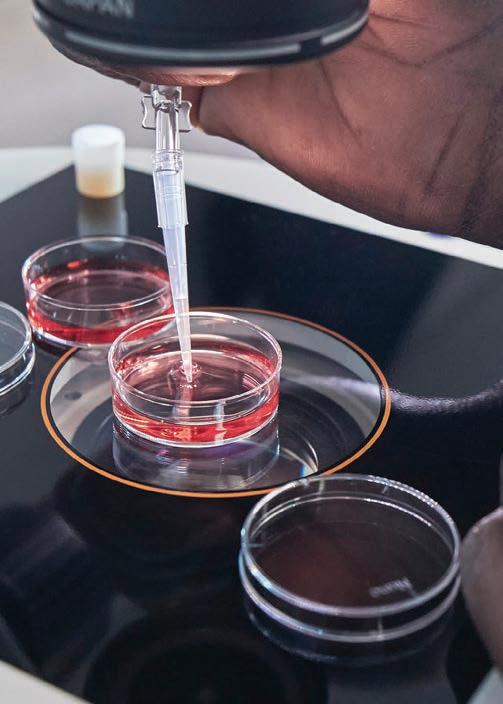

I L S O O TITLE SPONSORS




















![]()



























































































POLLED FEMALE SHOW
edford, Neb.

COW-CALF PAIR SHOW
Bruneau, Idaho


















POLLED FEMALE SHOW
Guernsey, Wy.
























BRED-AND-OWNED BULL SHOW

FUTURE PROFESSIONALS CONTEST
Cedartwon, Ga.




HORNED FEMALE SHOW
Glencoe, Okla.




SHOWMANSHIP & TEAM FITTING CONTEST

PARTNER IN WEBCAST TECHNOLOGY































BRED-AND-OWNED FEMALE SHOW
Desdemona, Texas
SENIOR SHOWMANSHIP
Manhattan, Kan.

HYFA 5K RACE
Ada, Mich.







































































CK Sales & Marketing, Colt & Katy Ke er, Topeka, Kan.
CSC Show Cattle, Easton, Ill.
Day Ridge Cattle, Telford, Tenn.
Fitz Genetics, Perry, Okla.
Hill & Hollow Farms, LLC., Bradford, Ohio



Herdsman of the Year
Retiring NJHA Member Awards






Jimmy Jackson, Jonesborough, Tenn.

Laible Herefords, Howards, S.D.
Maryland Junior Hereford Association
Rustic Oaks Farm, Tiskilwa, Ill.
Travis Drumm, Lancaster, Ky.



















Matheny Herefords, Mays Lick, Ky.
Edenburn Family Farms, Pen eld, Ill., and Illinois Junior Hereford Association Super States Award GKB Cattle, Desdemona, Texas










SPONSORING THE:
GRAND CHAMPION B&O FEMALE
RESERVE GRAND CHAMPION B&O FEMALE

3RD OVERALL B&O FEMALE
4TH OVERALL B&O FEMALE
5TH OVERALL B&O FEMALE
INCLUDING

DIVISION CHAMPIONS, RESERVE DIVISION CHAMPIONS AND CLASS WINNERS







Grand Polled Female
Grand Horned Female






















Ho man Ranch, edford, Neb. & Stellp ug Cattle Co LLC, Glenrock, Wyo.
Reserve Grand Polled Female Bar One Ranch, Eugene, Ore.
Ho man Ranch, edford, Neb. & Stellp ug Cattle Co LLC, Glenrock, Wyo.
Reserve Grand Horned Female Sierra Ranches, Modesto, Calif.
Grand Bull

Reis Herefords, Spring eld, Mo. & Wildcat Cattle Company, Darlington, Wis.
Reserve Grand Bull Copeland & Sons LLC, Nara Visa, N.M.
Grand Champion Steer HRC Feedyards, Scott City, Kan.
Champion Bred-and-Owned Steer
Reserve Champion Steer Texas Hereford Association
Springhill Hereford Farm, Blue Rapids, Kan.



Reserve Champion Bred-and-Owned Steer LiveAg LLC
Grand Cow/Calf Pair Grass Pond Farm, Greendell, N.J.
Champion B/O Cow/Calf Pair
Reserve Champion B/O Cow/Calf Pair

Reserve Grand Cow/Calf Pair Wildcat Cattle Company, Darlington, Wis.

Black Locust Livestock, LLC - e Webert Family, Warrenton, Va.
McGu ee Polled Herefords, Mendenhall, Miss.
Champion Owned Cow/Calf Pair Atkins Herefords, Tea, S.D.
Reserve Champion Owned Cow/Calf Pair
Grand Champion PeeWee Showman



J&L Cattle Services, Jeromesville, Ohio
Ella Weldon Cattle Company, Piedmont, Okla.
Reserve Grand PeeWee Showman Madilyn & Saylor Norvell, Tuttle, Okla.
Grand Champion Junior Showman Kinleigh Jo Guidry, Brenham, Texas
Reserve Grand Junior Showman Tennessee River Music, Fort Payne, Ala.
Grand Champion Intermediate Showman Paxton Hovely, Payette, Idaho
Reserve Grand Intermediate Showman JB Livestock, Canton, Kan.
Grand Champion Senior Showman Grimmel Schaake Cattle Company, Manhattan, Kan.
Reserve Grand Senior Showman Barron Road Herefords - Mike ompson, Park, Ill.


























Division I Champion Bred-and-Owned Steer GLM Herefords, Marysville, Kan.
Division I Reserve Champion Bred-and-Owned Steer Trailers 4 U, Frankfort, Kan.
Division II Champion Bred-and-Owned Steer Deatsman Farms, Leesburg, Ind.

Division II Reserve Champion Bred-and-Owned Steer SmartLic - New Generation Supplements


Division III Champion Bred-and-Owned Steer Weeping Fox Ranch, Hartley, Iowa
Division I Champion Steer Springhill Hereford Farm, Blue Rapids, Kan.



Division I Reserve Champion Steer Minnesota Junior Hereford Association
Division II Champion Steer Butler Polled Herefords, Republic, Mo.



Division II Reserve Champion Steer G&R Herefords, Marysville, Kan.



Division III Champion Steer Reed Stock Farm, Hampton, Minn.






















Division I Champion Bred-and-Owned Bull Mayo Ridge Ranch, Scott City, Kan.
Division I Reserve Champion Bred-and-Owned Bull Sidwell, Herefords, Carr, Colo.
Division II Champion Bred-and-Owned Bull Grand Meadows Farm, Ada, Okla.
Division II Reserve Champion Bred-and-Owned Bull D and Double J Farms, Columbia, Miss.
Division III Champion Bred-and-Owned Bull Reis Herefords, Spring eld, Mo. & Wildcat Cattle Company, Darlington, Wis.
Division III Reserve Champion Bred-and-Owned Bull Herefords Hills Event Venue, Columbia, Miss.
Division IV Champion Bred-and-Owned Bull Reis Herefords, Spring eld, Mo. & Wildcat Cattle Company, Darlington, Wis.
Division IV Reserve Champion Bred-and-Owned Bull MCS Cattle Company, Sparta, Tenn. & Young Brothers, Springville, Tenn.
Division V Champion Bred-and-Owned Bull Reis Herefords, Spring eld, Mo. & Wildcat Cattle Company, Darlington, Wis.



Division V Reserve Champion Bred-and-Owned Bull Next Generation Genetics, Endeavor, Wis.































Division I Champion Horned Female Everhart Herefords, Waldron, Ind.
Division I Reserve Champion Horned Female B&J Cattle Co, Hamilton, Texas
Division II Champion Horned Female VH Cattle Co, Morgantown, Ind.
Division II Reserve Champion Horned Female Grady, Gage & Graham Creamer, Waxahachie, Texas
Division III Champion Horned Female LUK Cattle, Weatherford, Texas
Division III Reserve Champion Horned Female Hansen Sister Show Cattle, Checotah, Okla.
Division IV Champion Horned Female Lemenager Cattle, Hudson, Ill.
Division IV Reserve Champion Horned Female Trailers 4 U, Frankfort, Kan.

Division V Champion Horned Female In Memory of Ralph Dyer, Pleasantville, Iowa
Division V Reserve Champion Horned Female Minnesota Junior Hereford Association


Division VI Champion Horned Female Buck Cattle Company, Madill, Okla.
Division VI Reserve Champion Horned Female Next Level Genetics, West Burlington, NY



Division VII Champion Horned Female Buck Cattle Company, Madill, Okla.
Division VII Reserve Champion Horned Female Weaber Livestock, Wamego, Kan.


Division VIII Champion Horned Female Redwood Cattle Company, Wamego, Kan.



Division VIII Reserve Champion Horned Female Addison & Jaelyn Koontz, omas, Okla.


























Division I Champion Polled Female Grady, Gage & Graham Creamer, Waxahachie, Texas
Division I Reserve Champion Polled Female Kelly & Stacie Bruns, North Platte, Neb.
Division II Champion Polled Female Hawes Cattle Company, Athens, Texas
Division II Reserve Champion Polled Female Ogburn Herefords, Sanders, Ky.
Division III Champion Polled Female Dorrell Cattle Co, Highland, Kan.
Division III Reserve Champion Polled Female Watson Land & Cattle, Flemingsburg, Ky.
Division IV Champion Polled Female Sierra Ranches, Modesto, Calif.
Division IV Reserve Champion Polled Female Mullett Livestock, Stillwater, Okla.
Division V Champion Polled Female KLD Herefords - Mark, Kirbie & Rhett Sims, Elgin, Okla.
Division V Reserve Champion Polled Female Womack Cattle, Pembroke, Ky.

Division VI Champion Polled Female LUK Cattle, Weatherford, Texas
Division VI Reserve Champion Polled Female Bruns Brothers, North Platte, Neb.
Division VII Champion Polled Female Circle F Cattle, Brownstown, Ind.
Division VII Reserve Champion Polled Female River Bend Farms - e Callicott Family, Only, Tenn.



Division VIII Champion Polled Female Paulsen Cattle, Preston, Iowa
Division VIII Reserve Champion Polled Female Werk Herefords, Herman, Minn.
Division IX Champion Polled Female Rock Ridge Herefords, Versailles, Ky.



Division IX Reserve Champion Polled Female Topp Herefords, Grace City, N.D.
Division X Champion Polled Female Cottage Hill Herefords, Petersburg, W.V.
Division X Reserve Champion Polled Female Mitchem’s Farm, Vale, N.C.
Division XI Champion Polled Female Day Ridge Farm, Telford, Tenn.
Division XI Reserve Champion Polled Female Chad Oates, Rising Star, Texas
Division XII Reserve Champion Polled Female
Division XII Champion Polled Female Hicks Herefords - Darrell & Pat Hicks, Cullman, Ala.
MRW Herefords - e Matt Woolfolk Family, Adair, Iowa
Division XIII Champion Polled Female Dave and Marcia Hackett, In Memory of Mike Hackett
Division XIII Reserve Champion Polled Female Biggs Polled Herefords, Dixon, Ill.
Division XIV Champion Polled Female e Green Stu Daily Hair Care Products, Amity, Mo.




Division XIV Reserve Champion Polled Female Jensen Land & Cattle, Courtland, Kan.
Division XV Champion Polled Female Grimmel Girls Cattle Company, Jarrettsville, Md.
Division XV Reserve Champion Polled Female MTM Polled Herefords, Douglasville, Ga.













































Claire Norris, Eudoria, Kan., serves as an American Hereford Association (AHA) youth activities intern this summer. She recently graduated from Kansas State University (K-State) with a bachelor’s degree in animal sciences and industry, with an emphasis in agricultural communications and marketing, and a minor in mass communications.
She was actively involved in several organizations at K-State and pursued numerous opportunities outside the classroom. She was a Kansas State Block and Bridle member and an ASI Mentor. Norris also gained valuable hands-on experience through internships with the American Angus Association and K-State Research and Extension. Additionally, she held leadership roles within the animal sciences and industry event planning and communications class.
Norris’ internship includes helping with the 26th annual VitaFerm® Junior National Hereford Expo (JNHE), the Faces of Leadership conference, the World Hereford Conference (WHC) and the WHC Young Breeders Competition this fall.

Kailyn Stokes, Marion, Ky., joins the AHA as a youth activities intern this summer. Her role includes assisting the National Junior Hereford Association (NJHA) with production of the annual VitaFerm® JNHE. She also will collaborate with association sta on other NJHA projects, such as the Faces of Leadership conference.
Stokes is a junior at Oklahoma State University (OSU), where she is pursuing a bachelor’s degree in animal science and agricultural communications. She is an active member of Class XIV of the McKnight Scholars Leadership Program, OSU Agricultural Communicators of Tomorrow, and the Oklahoma Collegiate Cattlemen’s Association. She also serves as an OSU campus tour guide and Career Liaison for the Ferguson College of Agriculture. Prior to college, Stokes served as the 2023-24 Kentucky 4-H State Reporter.
Denver Drake, Greenville, Texas, is serving an internship with the AHA and Hereford Publications Inc. (HPI) this summer. She served as an AHA youth activities intern last summer, nding her passion and wanting to nd her way back to Kansas City.

She will help with various communications and HPI projects, including social media content creation, email marketing and the 2025 WHC. Additionally, Drake will write stories and provide photography for the Hereford World and Baldy Advantage magazines.
Drake recently graduated from Texas Tech University (TTU) with a bachelor’s degree in agricultural communications and a minor in public relations and strategic communications. She was very involved in and out of the TTU classroom, completing internships for iCEV Marketing, the State Fair of Texas Livestock Show, American Royal Livestock Show and the AHA.








Erynn Allison, Ti on, Ga., serves as a JNHE Ambassador. She is a senior at OSU, pursuing a degree in agricultural education with a certi cate in ethical leadership. While at OSU, Allison has been involved with the McKnight Scholars leadership program, the Oklahoma Agricultural Leadership Encounter and the American Royal Scholars. She completed internships with the Oklahoma Youth Expo, Cattlemen’s Congress, Arkansas Youth Expo, the California Youth Ag Expo and the Payne County Extension O ce. Following her time as a JNHE Ambassador, Allison will begin her nal undergraduate semester as a student teacher at Peach County High School in Fort Valley, Ga. She has always appreciated the opportunity to create positive experiences for youth in agriculture and looks forward to working with exhibitors at the 2025 JNHE.

JNHE Ambassador, Jacey Bordwine, Dibble, Okla., is a junior at OSU, where she is pursuing dual degrees in animal science and agricultural communications. roughout her time at OSU, she has been actively involved in a variety of student organizations. She is a dedicated member of the Ferguson College of Agriculture Ambassador Team, serving as a recruiter and representative for prospective students. Bordwine’s experience includes internships with the Oklahoma Youth Expo, Cattlemen’s Congress and the Oklahoma Bred Swine Association. She will return to the Oklahoma Youth Expo this fall as a full-time intern. Bordwine looks forward to bringing the skills and knowledge she has gained to the JNHE and the NJHA.





















SATURDAY, JULY 12
6 p.m.
July 12-18, 2025Louisville, Ky.
Gates open for tack trailers to arrive and set up in barns
Cattle may arrive into tie-outs through the night
SUNDAY, JULY 13
7 a.m.
8:30 a.m.
9 a.m.
9 a.m.
9:30 a.m. - Noon
10 a.m. Noon Noon
2 p.m.
3:30 p.m.
5:30 p.m.
6 p.m.
6:30 p.m.
NJHA Board & Candidate Orientation Breakfast
Hereford Bowl Check-In & Written Test
All cattle must be in barns at this time
Tattoo checks begin in each barn
Cattle Paper Check-In & Packet Pick-Up
Advanced & Illustrated Speech Contest
Steer weights declared electronically by this time
National Hereford Women’s Queen’s Orientation
NJHA Meet-Up #1 - Powered by SureChamp®
Meet the Candidate Social & Delegate Forum
State Group Photos
Opening Ceremonies
JNHE Tailgate Party
MONDAY, JULY 14
7:30 a.m.
8 a.m.
9 a.m.
11 a.m.
1 p.m.
2:30 p.m.
3 p.m.
5 p.m.
6 p.m.
6-8 p.m.
HYFA’s Live 5K Race Judging Contest Check-In & Orientation Judging Contest
*Oral Reasons Contest to immediately follow
National Hereford Queen’s Tea
NJHA Meet-Up #2 - Powered by SureChamp®
Hereford Bowl Buzzer Round (start with junior division)
Sullivan Supply Stock Show University
Sullivan Supply Fitting Contest
Future Professionals Contest Interviews Bridging the Gap College & Career Fair
TUESDAY, JULY 15
8 a.m.
9 a.m.
State Group of 3 & 5 Classes
Sullivan Supply National Showmanship Contest
Senior, Intermediate & Senior Finals
Junior & Peewee
WEDNESDAY, JULY 16
7 a.m.
9 a.m.
NJHA Membership Update, Breakfast & New Board Election
Bred-and-Owned Show
Cow-Calf Pairs, Bred-and-Owned Females, Produce of Dam Steer Show followed by Bred-and-Owned Bulls
W1 & W2
W5 - W10
W3 & W4
W3 & W4
W1 & W2
THURSDAY, JULY 17
7:30 a.m.
6 p.m. Owned Female Show
HYFA Scholarship, Awards & Maroon Jacket Ceremony
FRIDAY, JULY 18
7:30 a.m. Conclusion of Owned Female Show






Broadbent Arena
Broadbent Arena
West Hall A & B
West Hall A & B
Broadbent Arena
Broadbent Arena
W5 - W7
W1 & W2
W3 & W4
W1 & W2
Broadbent Arena
Broadbent Arena
W16 & W17
W5 - W10
Broadbent Arena
Broadbent Arena
Ring 1
Ring 2
W1 & W2
Broadbent Arena Ring 1 Ring 2
*Buckle and Awards Ceremony honoring CHB Cooking Challenge, Photo & Poster Contests, prior to selection of the Bred-and-Owned Top Five.
Broadbent Arena
Broadbent Arena
*Buckle and Awards Ceremony honoring Future Professionals, Speech and Judging Contests, will follow the selection of the Division 3 Polled Females.
Broadbent Arena
*Buckle and Awards Ceremony recognizing Herdsman of the Year, Walter and Joe Lewis High Point Senior, GKB Super States, Golden Pitchfork and the Bob Norton Excellence Award will be held prior to the champion drives.













•
•
•




— Claude T. Bissell









Jacob Toombs (417)399-0738
Dale & Mary Barber office@barberranch.com
10175 FM3138, Channing, TX 79018 barberranch.com

WEDNESDAY, NOVEMBER 12, 2025
Barber Ranch Annual Bull Sale, San Saba, TX SATURDAY, DECEMBER 13, 2025
GKB & Barber Female Sale, Desdemona, TX
Ranch located 60 miles northwest of Amarillo. Visitors always welcome!







October

























































































































































































































































































Focus Marketing Group (FMG) believes that the best marketing campaigns are created when the marketing agency and customer work together as a team. This is why we focus on creating strong team dynamics with our customers. We want to get to know your operation inside and out, so that we can create marketing efforts that are tailored to your specific needs. We want to be your partner in SUCCESS; when you succeed, we succeed.





www.focusmarketinggroup.net

ClariFly® Larvicide Top-Dress Fly Control
Clari ly ar icide op ress ly Control elps pre ent t e emergence of adult ouse flies stable flies face flies and orn flies from manure of treated beef and dairy cattle breeding stock and s ow animals. is top dress supplement also pre ents t e emergence of ouse flies and stable flies from t e manure of treated s eep goats e uine and swine.



FLY CONTROL THAT SETS THE BAR AT ALL LEVELS


Insects on your operation are a nuisance to you and your employees but t ey also pose a t reat to your animals and property causing signi cant economic losses. at s w y it is so important to set t e bar for insect control using Starbar products. As an industry leader Starbar as a mission to pro ide e ecti e pest control solutions.






































#ALASTINGLEGACY LIVES ON AT THE OG+E COLISEUM.

We’re proud to welcome you to the 6th Annual Cattlemen’s Congress—now hosted in our new home: the OG+E Coliseum. This state-of-the-art livestock facility represents a bold step forward, built to better serve cattlemen and women from


JAN. 4-15, 2026 around the world.
Larger arena floor for elite shows Upgraded power and barn improvements for enhanced convenience support your experience
























































We are more than a membership. We are mothers, daughters, breeders, mentors, and advocates - a with a heart for the Hereford breed and the youth who carry it forward.
who we are:

Advocates for the Hereford breed

leadership

Whether you’ve been involved for decades or are just joining the industry, NHW welcomes YOU.




Providers of scholarships & support A community rooted in tradition, built on join us at the gathering! September 19-21 2025
Hi Point Ranch, Desdemona, TX








dedication. Keep shining is in great hands!





























Nataleigh Belcher, Twin City, Ga., was selected to represent the breed as the 2025 National Hereford Queen, prior to the selection of the grand champion bull at the 2024 American Royal hosted in Kansas City, Mo.
Belcher is 18 years old and a high school senior. e former Georgia Hereford Queen is a member of 4-H, FFA and Future Business Leaders of America, in addition to volunteering in her community. She serves as secretary for the Georgia Junior Hereford Association. She plans to major in agricultural education and minor in animal science at Abraham Baldwin Agricultural College a er high school graduation.







“ e National Hereford Queen is a symbol of grace and honor,” said Belcher. “She is an ambassador who is passionate about the Hereford breed and what it has done for the beef industry. She serves as an inspiration to cultivate the love of agriculture for future generations.







e National Hereford Queen, Nataleigh Belcher, unveils “Courage Kits” as her service project at this year’s JNHE. Inspired by her mother’s battle with leukemia and the physical, emotional and mental toll that cancer takes on patients and their families, Nataleigh will be collecting items to create small care packages tailored to cancer patients. Each Courage Kit will include comfort items, such as fuzzy socks, lotion, tea, etc., and relaxation items, such as books, coloring books, journals, puzzles and more, that cancer patients can take along with them during their treatment journey.




“Cancer is a battle that no one chooses, and for many, it can feel isolating and overwhelming,” Nataleigh says. “ rough this project, I want patients to feel the same love and encouragement that my mother received during her journey. A simple act of kindness can remind them that they are supported, valued and never alone in their ght.”









JNHE participants and their families can help prepare these Courage Kits by donating items for the care packages or volunteering during the designated times to pack the Courage Kits.
Courage Kits Shopping List:
Fuzzy socks
Lotion Chapstick
Tea Books/Small Bibles



“Just like our Hereford family supports one another; Courage Kits are about spreading hope and encouragement to those in need,” Nataleigh notes. “I am profoundly grateful for the opportunity to lead this project and for the unwavering support of the Hereford community. Every small act of kindness adds up, and together, we can make a di erence in the lives of those battling cancer, one kit at a time.

Small Coloring Books/Crosswords

Small Journals
Small Puzzles
Lemon Drops


































































































Logan, 22 years old, recently graduated from Purdue University with a bachelor’s degree in agribusiness. While at Purdue, Logan was involved with the FarmHouse Fraternity and the Purdue livestock judging team. He has been an active member of the Indiana Junior Hereford Association, attending and competing at the VitaFerm® Junior National Hereford Expo (JNHE) since 2010. His JNHE honors include earning rst place in the Hereford Bowl and Sales competitions, as well as placing in the top three of the judging contest. Logan has served four years on the National Junior Hereford Association (NJHA) board of directors, where he has used leadership skills developed in the NJHA and other organizations to help him on his maroon coat journey and to inspire younger members to wear a maroon jacket.
Logan plans to be a part of the Hereford breed and cattle industry for a long time and hopes to give back and support the organization in any way possible. Logan’s future goals include a career in agricultural sales and marketing, as well as taking over the family’s herd of purebred Hereford cattle from parents, Robert and Kristie McFatridge.

Haley is the 21-year-old daughter of Gib and Michelle Mouser. She will be a senior at South Dakota State University (SDSU) this fall, majoring in animal science and plans to pursue a master’s degree in meat science following graduation. Haley graduated from Butler Community College last May, where she was a competitive member of the livestock judging team and earned an associate’s degree in agribusiness. She has continued judging at SDSU and will conclude her season this fall.
Haley’s long-term goal is a career that allows her to support producers through promoting beef, while always continuing to use her passion for public speaking. Since attending her rst JNHE in 2016, her goal was to wear a maroon jacket, which led her to become involved in all facets of the NJHA. Some highlights from her involvement include serving as the Minnesota Junior Hereford Breeders president and being selected NJHA Fed Steer Shootout Senior of the Year. Haley’s focus as an NJHA board member continues to be serving juniors and paying forward all that was given to her during her time as member.


Salem is the 21-year-old daughter of Steve and Rosemary Si ord. She will be a senior at Virginia Tech this fall, majoring in dairy science with minors in agricultural business and animal and poultry sciences. Salem is active in Virginia Tech’s Beef Leadership Council, Dairy Club, Alpha Zeta and Young Farmers. She was a competitive member of the school’s livestock judging and dairy judging teams. Currently, Salem serves as a teaching assistant for the Virginia Tech dairy and livestock judging teams. is summer, she is interning with the Animal Agriculture Alliance, as well as Virginia Cooperative Extension.
Salem is excited to serve as a voice for members of the agricultural community and youth in the agricultural industry. Salem has been a member of the NJHA for 14 years, holding several leadership roles. Some of her fondest memories come from the friends she has made within the Herford industry and the time spent with family along the way. She strives to be someone that youth can look up to and receive encouragement. Her goal within the NJHA is to focus on encouraging juniors to work toward their goals with con dence and dedication.







Lauren is the 22-year-old daughter of Taylor and Jennifer Gatz. She graduated from Kansas State University (K-State) in May, where she majored in agricultural communications and journalism with minors in leadership studies and marketing. At K-State, Lauren was involved in Agricultural Communicators of Tomorrow (ACT), the Agriculturist magazine and the Kappa Kappa Gamma sorority. She has served internships with the Beef Improvement Federation, the American Royal, Cargill and U.S. CattleTrace. Lauren has been an NJHA member for 14 years, holding numerous leadership positions. In addition to her NJHA leadership role, Lauren also serves as the communications director for the Kansas Junior Hereford Board.
Lauren’s goal as an NJHA board member is to help juniors nd their place within the organization and encourage them to take advantage of the association’s many opportunities. She hopes to contribute to the development of the next generation of leaders and ensure the future success of the Hereford breed throughout her time on the board.
Harlee is the 19-year-old daughter of Matt and Melinda Watson. She will be a sophomore at Butler Community College this fall, majoring in agribusiness and competing on the school’s livestock judging team. Harlee is an active member of the Collegiate Farm Bureau and the Ag Ambassadors club. She is involved extensively in the Kentucky Junior Cattlemen’s Association, where she served on the board for several years. Harlee has been a member of the NJHA for 12 years, holding numerous leadership positions, including serving three years as president of the Kentucky Junior Hereford Association.

Harlee’s goal as a junior board member is to motivate juniors of all ages to get involved and have fun. She hopes to shine light on the opportunities available and help members develop their leadership skills to grow the Hereford breed and agricultural industry.




Sam is the 20-year-old son of Dennis and Heather Birdsall. He will be a junior at Kansas State University this fall, double majoring in agricultural economics and accounting. At K-State, Sam is active in the Collegiate Cattlemen’s Club, the College of Agriculture’s Student Council and the Alpha Gamma Rho Fraternity, where has helped plan and run the Alpha Gamma Royal Preview Show. He has been an NJHA member for 14 years.
Sam looked up to NJHA board members since his rst JNHE. He knew he wanted to run for the board for as long as he can remember. Sam’s goal for his time on the board is to inspire NJHA members to dream more, learn more, do more and become more.






























Kaylee, 23 years old, graduated from Tarleton State University, where she was involved in many campus activities. She is currently a member of the Sullivan Farms Cattle Sale team in Dunlap, Iowa. Kaylee hopes to apply knowledge gained in this position to a master’s program in nutrition, with plans to study the impact of nutrition on animal and reproductive health. Kaylee, the daughter of Hoyt and Crystal McInvale, has been raising and showing cattle all her life and has participated in several breed associations. She had been part of the Texas Junior Hereford Association and the Texas Junior Polled Hereford Association for 13 years. Kaylee also served as the 2020-21 National Hereford Queen. She has been inspired by previous owners of the maroon coat. She hopes her time on the NJHA board has inspired those around her to follow their dreams.

Isaac is the 22-year-old son of Je and Susan Rhode. He recently graduated from the University of Missouri (Mizzou) majoring in agriculture with an emphasis in animal science, ag business and ag leadership. He is now an agricultural loan o cer for Goppert Financial Bank in northwest Missouri. While at Mizzou, Isaac was involved in the Alpha Gamma Rho Fraternity, Block and Bridle Club and Collegiate Farm Bureau. He also was involved in leadership roles in the Missouri Junior Cattlemen’s Association and Missouri Junior Angus Association. He has been recognized for his involvement in FFA on the state and national levels.
Isaac served as a director of the Missouri Junior Hereford Association, including terms as president and secretary and has exhibited at the JNHE for 14 years. is involvement inspired his passion for the Hereford breed and the NJHA. Isaac’s goal as an NJHA director is to make an impact on other people’s lives and to help them achieve their goals and dreams. His motto for life is to, “Adapt to change in any situation.”



Emma is the 20-year-old daughter of James and Carrie Ballinger. She recently completed her sophomore year at the University of Kentucky Martin-Gatton College of Agriculture, where she is studying agricultural education and advocacy. Emma plans to use her degree to share her passion for agriculture with others and to teach her students the value of agriculture. At the University of Kentucky, she is involved with Collegiate Farm Bureau, e Ag Ed Society, and the Singletary Scholars Cohort. Emma worked for the Kentucky FFA Foundation during the last two semesters, helping raise funds to impact the lives of future agriculturalists—highlighting her passion for introducing others to the eld of agriculture. As an NJHA member, and during her time in the maroon jacket, Emma hopes that she can help younger members nd the courage to be involved and to step out of their comfort zone. Her goal as an NJHA director is to make others feel at home and welcome within the Hereford breed.





Matt is the 21-year-old son of Kelly and Stacie Bruns. He will be a senior at Kansas State University this fall, majoring in animal science with a focus on livestock production and management. He has a strong passion for the purebred cattle industry and is actively involved in the NJHA, as well as other breed associations. Matt has exhibited at numerous JNHEs and has served in local and national leadership roles. He is interning with Boviteq this summer, where he is gaining hands-on experience in advanced reproductive technologies. Matt plans to combine his interests in genetics and sales to build a career in cattle marketing and reproductive services.
He is excited to give back to the association that has shaped his leadership and personal growth and hopes to inspire younger members to get involved and take full advantage of NJHA opportunities. Matt’s goal as a board member is to help juniors nd their voice and thrive within the Hereford community.

Sarah Beth Callicott, 20 years old, is the daughter of Claude and Lee Ann Callicott. She is a junior at Tennessee Tech University, majoring in agricultural education. Sarah Beth plans to turn her passion for agriculture and the beef industry into a lifelong career, teaching and inspiring future generations of agricultural leaders. On campus, she’s an active member of Sigma Alpha, the professional agricultural sorority, and she participates in the Baptist Collegiate Ministry. Sarah Beth also works at a cow-calf operation, gaining valuable experience in beef production, genetic selection and cattle marketing.

A proud member of the NJHA for the past seven years, she is excited to step into the ring at her h JNHE. Sarah Beth and her family take pride in raising high-quality Hereford heifers in their operation and are honored to represent the Hereford breed. Wearing the maroon jacket with pride, Sarah Beth hopes to inspire fellow Hereford juniors to nd their con dence and strive to become the next leaders of our industry.



Rylie Meinhardt is the 19-year-old daughter of Bryndon and Julie Meinhardt and comes from a proud agricultural family. She recently completed her freshman year at Kansas State University, where she is pursuing a degree in animal sciences and industry. Rylie is actively involved on campus, serving on the Student Alumni Board and participating in Agricultural Communicators of Tomorrow, Block and Bridle, Agriculture Ambassadors and as a mentor in the animal sciences and industry program. Alongside her siblings, Rylie co-owns and operates Redwood Cattle Company, where they raise Hereford and Gelbvieh cattle. With a strong interest in marketing and communications, Rylie combines her academic focus with her hands-on experience in the beef industry. She is especially passionate about developing leadership skills in junior members, just as past mentors and board members did for her. Rylie values learning from others and is deeply committed to building relationships within the Hereford community.

































































Alabama Junior Hereford Assn.
Karleigh Allison
Sara Beth Faust
Laura Landers Franklin
Mary Hannah Gullatt
Silas Gullatt
Peyton Heard

Rose Hodnett
Mary Elliott Martin
Rileigh Mears
Anthony Mezrano
Jessica Mezrano
Michael Mezrano
Brooklyn Price
Harper Rose Starnes
John Owen Starnes
Vivian Lou Thompson
Arkansas Junior Hereford Assn.
Luke DeSalvo

California/Nevada Junior
Hereford Assn.
Gentry Gudel
Hadley Harrison
Hannah Harrison
Paxton Hovley
Joseph Schohr
Madeline Schohr
Canada Junior Hereford Assn.
Jacob Ball
Katie Cox
Garth McIntyre
Connor McNaughton
Cooper McNaughton
Jacob McNaughton
Kaleigh McNaughton
Elizabeth Schaub
Colorado Junior Hereford Assn.
Tessa Booco
Samantha Campbell








Georgia Junior Hereford Assn.
Martina Alley
Hess Fowler
Houston Fowler
Diana Kate Gillooly
Kadie Jo Hurd
Kylie Hurd
Lexa Jukes
Beau Knight
Clay Lawrence
Emma Lawrence
Hoyt Lawrence
Kate Rae Lovin
Kilee Lovin
Tanner Mantooth
Conner McQuaig
Karaleigh Mills
Idaho Junior Hereford Assn.
Cache Billman
Chyloh Billman
Tymber Billman
Cruz Colyer
Cayden Cronquist
Sutter Danekas
Morgan Fuhriman
Illinois Junior Hereford Assn.
Ryne Allen
Allie Anderson
Griffin Anderson
Lilly Anderson
Ty Anderson

Ella Bane
Madison Bauer
Faith Benedict
Kade Boatman
Kendall Boatman
Ella Brooks
Cora Belle Chapman
Crayton Chapman
Taylor Cole
Tyler Cole
Ella Crane
John Crane






Gabe Crutcher
Owen Crutcher


Shawn Crutcher
Trevor Crutcher
Lily DeAth
Addison Duis
Hadley Eubank
Olivia Eubank
Jacob Fiscus
Bryar Fleisher
Elyse Garnhart
Peyton Garnhart
Ryan Garnhart
Ella Gillespie
Kylie Gillespie
Rhett Gillespie
Alexsys Hammond
Chism Harms
Tinley Harvie
Chase Hattan
Cooper Hattan
Colin Huelsmann
Alexander Huisheere
Reagan Kasper
Brogan Keltner
Jace Kenady
Jake Kenady
Montana Kenady
Aidan Knobloch
Weston Lampe
Nolan Lee
Ellie Lehman
Kent Lehman
Rhett Lehman
Paige Lemenager
Paislee Lorenzen
Nash Lowderman
Tuck Lowderman
Drew Melendrez
Mattie Melendrez
Macy Michelini
Reed Naughton
Nolan Orwig
Bailey Pearl
Shelby Pearl





Loyd Perks
Caden Perry
Corbin Perry
Colton Peterson
Ty Pezanoski
Connor Rhoads
Danica Rhoads
Logan Rhoads
Riley Rhodes
Daniel Richardson
Morgan Richardson
Lacie Sellers
Kaylie Shelton
Maggie Shepard
Simon Shepard
Peyton Sidles
Shelby Siemer
Laney Stephens
Addison Stollard
Tenley Stollard
Blakely Storey
Stetson Storey
Kade Swigart
Korbin Swigart
Elaina Walsh
Addison Young
Hattie Young
Olivia Young
Indiana Junior Hereford Assn.
Ashley Alexander
Barrett Carper
Braxton Carper
Collin Deatsman
Landon Deatsman
Ava Doig
Bremley Doig
Ray Duncan
Matthew Elzemeyer
Annie Everhart
Avery Everhart
Cora Everhart
Eliza Everhart
Tessa Everhart
Briley Fix
Landon Fix
Garrett Flohr
Mattie Flohr
Bryce Gilbert
Riggin Goings
Huck Gray
Maddox Gunn
Wyatt Gunn
Luke E Hayse
Aubrey Landrum
Jase Lasby
Sage Lawrence
Brooklyn Leinenbach
Lena May

Carlee Musser
Catie Musser
Clayton Musser
Colyer Schaeffer
JD Seward
Garrison Siedling
Isaac Siedling
Ross Siedling
Jayden Simpson
Naomi Sinnamon
Emma Stephens
Delaney Truebenbach
Paislee Van Horn
Scarlett Ward
Iowa Junior Hereford Assn.
Ryder Cherry
Rylee Cherry
Colton Davisson
Emma Davisson
Ashlee Demolles


Macy Macke
Dax Putz
T.R. Putz
Tommi Rabel
Kennedy Rife
Chloe Rogers
McKenna Rogers
Morgan Rogers
Logan Schroeder
James Sladek
Addyson Sweeney
Avery Sweeney
Anna Wagner
Avery Wagner
Caroline Wagner
Reeve Wagner
Kansas Junior Hereford Assn.
Addison Acheson
Cooper Acheson
Emmett Acheson
Kinsey Acheson
Drew Ballard
Jase Beltz
Josie Beltz
Quinn Breiner
Will Breiner
Kaden Camerlinck
Brinley Davis
Danica Davis
Jalyn Davis
Dustin Denton
Cole Dieball
Kallen Evans
Kinzley Evans
Delaney Figge
Tyree Figge
Canaan Fink
Corbin Fink
Lauren Gatz


McKenna Gatz
Koy Gibbs
Kinsley Gillig
Bradyn Greenwood
Brody Greenwood
Laynee Greenwood
Tava Gustafson
Layton Hopkins
Lute Judy
Bronson Marston
Trigg Marston
Brayson Mayo
Rylie Meinhardt
William Meinhardt
Cally Miller
Cami Miller

Charli Moore
Kinsley Mullinix
Mason Mullinix
Dagan Murray
Cady Pieper
Reese Sandberg
Roland Sandberg
Ryne Sandberg
Callie Schmidt
Lexi Schmidt


Spencer Schmidt
Heidi Schwieterman
Jace Schwieterman
Jace Stithem
Kolter Stithem
Caroline Studer
Jacqueline Studer
Johanna Studer
Julia Studer
Cooper Weaber
Madelyn Weaber
Wyatt Weaber
Nora Werk

Kentucky Junior Hereford Assn.
Emma Ballinger
Hunter Barnes
Will Beckley
Nate Bramer
Madelyn Grannis
Marlee Grannis
Jordan Hall
Rylan Hines
Hallie Hughes
Hannah Keith

Kaitlyn Keith
Luke Keith
Tucker Lawson
Luke Marcum
Abram Meredith
Ada Meredith
Levi Mobley
Brenna Perkins
Andrew Ray
Harper Ray
Quinton Ray
Annagail Sallee
Lucy Kate Sexten

William Sexten
Blaine Smith
Clark Smith
Creighton Smith
Sophia Smith
Warren Smith
Braylen Taylor
Ashlyn Tingle
Bo Todd
Ellen Todd
Harlee Watson
Levi Womack

Louisiana Junior Hereford Assn.
Addie Bourgeois
Willie Boyette
Kyler Cooley
Taluan Hall
Kara Nesom
Shelbi Russell
James Walker
Maryland Junior Hereford Assn.
Adalynn Grace Blankenship
Izzy Bohrer
Riley Bohrer
Lane Cady
Logan Cady
Rianna Chaney
Sheridan Chaney

Dorothy Deford

Ella Deford
Lucy Flynn
Ian Forbes
Addison Fritz
Ella Fritz
Emily Fritz
Chase Harward
Blair Heath
Troy Heath
Austin Justus
Ryleigh Lancaster
Bryliee Miller
Peighton Rhinehart
Trace Rhinehart
Piper Seiss
W. Marshall Stephens
Rylee Stockdale
Sophia Taylor
Emily Troyer
Julie Troyer

Owen McArthur
Paisley Miller
Matthew Nichols
Paige Nichols
Camdyn Nykamp
Lillian Schut
Minnesota Junior Hereford Assn.
Brant Altman
Reese Anderson
Lily Beissel
Maddi Beissel
Will Freking
Anna Gordon
Max McGunegill
Bella Pressnall
Case Pressnall
Adelyn Walsh
Ella Walsh
Emerson Walsh
Mia Walsh
Olivia Walsh
Carly Wheeler
Mississippi Junior Hereford Assn.
Sarah Kate Childs
Jalen Holt
Mattie Holt
Missouri Junior Hereford Assn.
Annabell Crabtree
Lauren Crabtree
Jorja Ebert
Beau Ann Graves
Emma Hancock
Ford Howard
Karsyn Kleeman
Atley Kleinman
Payton Zepp
Michigan Junior Hereford Assn.
Everly Foster
Corbie Green
Easton Harfst
Kaytlyn Harfst
Elayna Hawkins
Charlee Klink
Jase Klink
Fox Loney
Olivia McArthur
Alexis Koelling
Tory Miller
Emmalee Mueller
Phillip Mueller
Griffin Nitsche
Maggie Reed
Gavin Rhode
Isaac Rhode
Gabriela Rojas
Wyatt Russell
Brynlee Ann Thompson
Madelyn Grace Thompson
Addison Ward
Connelly Ward
Davis Ward
Gannon Ward
Mary Warden
Grant Waters
Kristin Waters
Montana Junior Hereford Assn.
Cooper Miller
Nebraska Junior Hereford Assn.
Kiera Bremer
Kinsley Bremer
Blair Buehler
Blake Day
Brooke Day
Emma Hackbart
Hayden Helms
Kylan Helms
Haxton Hoffman
Hayden Hoffman
Kennedy Hoffman
Timber Hula
Carly Kolterman
Maren Kolterman
Mike Kolterman
Kashlyn Krebs
Kynsleigh Krebs
Kian Morris
Chesney Prinz
Khloe Toelle
Trey Toelle
Jackson Wright
New England Junior Hereford Assn.
Luke Bergeron
Macalie Forrest
Agatha Gervais
Matilda Gervais
Scarlet Gervais
Emersyn McBride
Eva McBride
Mackenzie Perkins
Madison Perkins
Marissa Perkins
Molly Perkins
Morgyn Perkins
Dawson Ramsdell
Mackenzie Ramsdell
Madelyn Ramsdell
Harrison Roberts
Alyssa Satkowski
Benjamin Tammaro
Ryan Tammaro
Zoey Violette
Calob White
Elizabeth Wright

Madelynn Wright
Victoria Wright
New Jersey Hereford Assn.
Rhiannon Conover
Gage DeGroat
Isabella Hewitt
Avery Rowlett
Abigail Smith
Grace Smith
Craig Stahoski
Gunner Whitehead
New Mexico Junior Hereford Assn.
Libby Perez
Peyton Perez
New York Junior Hereford Assn.
Joshua Korzenieski
Gianna Marino
Rebecca VanCamp


North Carolina Junior Hereford Assn.
Charleigh Birdsell
Daisy Brown
Mack Bunn
Mazie Bunn
Ansley Gee
Wyatt Hooker
Janie Kay
Ella Knight
Cody Lyon
Laurel Mitchell
Jordan Mitchem
Addison Revis
Kaylee Revis
Amber Shutsky
Erica Shutsky
Blair Smith
North Dakota Junior Hereford Assn.
Clayton Heins
Ohio Junior Hereford Assn.
Natalie Brown
Evlyana Burwell
Delaney Chester
Hailey Cornett
Kurtis Evoniuk
Riley Evoniuk
Sawyer Hake
Grant Helsinger
Lindie Helsinger
Kylie Holman
Sadie Holman
Evelyn Johnson
Jillian Johnson
Gabrielle Keets
Emma Lewis
Natalie Liston
Nathan Liston
Makayla Massey
Geno Milano


Jess Miller
Tanner Ostgaard
Tripp Ostgaard
Tucker Ostgaard
Natalie Pitstick
Avery Stitzlein
Sadie Zaenger
Oklahoma Junior Hereford Assn.
Mckenzie Boyer
Kraiton Carpenter
Grady Carter
Hudson Carter
Cierra Collins
Claire Collins
Cricket Collins

Cara Cummins
Crew Cummins
Hayes Devine
Kendall Devine
Tripp Earls
Teagen Hames
Kristin Hansen
Miranda Hansen
Lyla Harvie
Clayton Hayes


Taos Heck
Parker Irwin
Addison Koontz
Jaelyn Koontz
Bryce Lewis
Koble Lewis
Kovin Lewis
Emma Lynn
Mayze Marshall
Quaid McIntyre
Wyatt McIntyre

Madilyn Norvell
Saylor Norvell
Jake Parker
Marlyn Pecha
Hannah Pembrook
Claiborne Perry
Kya Rhodes
Rae’kyn Rochell
Kylee Sadler
Kyndal Sadler
Baylee Smith
Blayklee Stelzer
Sutton Stelzer
Piper Tucker

Ella Weldon
Sadie Wynne
Oregon Junior Hereford Assn.
Fallon Gohr
Gunnar Gohr
Pennsylvania Junior Hereford Assn.
Serena Anderson
Hudson Fleener
South Carolina Junior Hereford Assn.
Amberlyn Christenbury
Caden Forrest
Gracie Simpson
Jayna Blume
Rett Blume
Makayla Simmermon
Tennessee Junior Hereford Assn.
Edynne Bolte
Ella Callicott
Sarah Callicott
Rhett Day
Luke Fisher

Josie Harville
Tana Harville
Turner Harville
Evan Jackson
Landon Mansfield
Logan Mansfield
Jackson Massey
Benton McClanahan
Braden McClanahan
Ellie Poarch
Maelee Poarch
Morgan Riley
Mary Carter Shirley
Tillman Staley
Anna Towns
Emmie White
Foster Wingler
Lauren Wingler



Reagan Wright
Spencer Wright
Paislee Jane Young
Texas Junior Hereford & Polled
Hereford Assn.
Landry Allan
Caleigh Allison
Kinsley Atchison
Aidyn Barber
Beckett Barber
Henley Barber
Madailein Beard
Madelyn Beaver
Nolan Beaver
Nancy Bing
Carlisle Braman
Madeline Braman
Caitlyn Clapper
Gage Creamer
Grady Creamer
Graham Creamer
Paige Denniston
Caitlyn Edwards
Hunter Faust
William Faust
Megan Gajdica
Kayston Goss
Keaton Goss
Savanah Grimes
Allyson Hamilton
Mallory Hamilton
Luke Hamlin
Cadence Harris
Callie Harris
Rylee Harris
Ryli Hollis
Preslie Ivy
Maddie Jenkins
Adelynn Kuykendall
Keaton Kuykendall
Aubrey Lockhart
Braxton Lockhart
Devon Lockhart
Paisley Miller
Maryann Moore
Jace Murphree
W. Zeb Murphree
Kaegan O’Leary
Jayden O’Neill
Layna Ottmers
Mila Perez
Holden Roeder
Mason Roeder
Whitten Scarpinato
Bella Smith
Brody Smith
Abigail Snoddy
Gabriel Swallow
William Tackett
Keeley Warnken
Ainsley Williams
Jarrett Worrell
Danielle Zilberstein
Virginia Junior Hereford Assn.
Kerrigan Bauserman
Jack Begoon
Suter Clark

Garrett Hickey
Scott Hickey
Megan Mallory
Layton Reames
Savannah Ritenour
Stetson Rogers
Salem Sifford
Sedona Sifford
Ashley Tutwiler
Reid Tutwiler
Benjamin Webert
William Webert
Washington State Junior
Hereford Assn.
Adelina Betes
Sydney Betes
Jarrett Dalia
Cody Knaus
Kaylee Knaus
West Virginia Junior Hereford Assn.
Nick Bernatowicz
Laurel Cornell
Hogueland Wade Goldizen
Samuel Goldizen
Emilea Greathouse
Landon Hall
Kenzie Hawkins
Kora Hawkins
Jebediah Painter
Aaron Shriver
Hannah Taylor
Olivia Ullom
Wisconsin Junior Hereford Assn.
Brooke Aue

Elayna Aue
Bianca Elaine Bevan
Mya Colleen Bevan
Blake Brancel
Bryce Brancel
Amari Edge
Morgan Firlus
Alison George
Brady Jones
Lauren Jones
Nick Jones
Olivia Jones
Alisha Klemme
Danica Klemme
Kenneth Kypke
Jordan Lamb
Brea Musser
Hannah Oleson
Ryan Oleson
Caleb Pronschinske
Jack Rasmussen

Kennady Rasmussen
Madyson Rasmussen
Makenna Smith
Tessa Smith
Wyoming Junior Hereford Assn.
Sam Birdsall

Sarah Birdsall



















































Cody Sankey owns and operates Sankey Angus alongside his wife, Lindsay, and children, Caroline and Cyrus, in Economy, Ind. He holds a bachelor’s degree in animal science and a master’s degree in ruminant nutrition from Oklahoma State University (OSU), where he was also a member of their 2001 national champion livestock judging team. Cody serves as the senior director of beef programs at GENEX Beef and formerly managed the Michigan State University (MSU) Beef Cattle Center for eight years. He also spent two years coaching the MSU livestock judging team.
A h-generation cattleman, he grew up on Sankey’s 6N Ranch in Council Grove, Kan., home to the second oldest Angus herd in the U.S., representing more than 125 years in the Angus breed. O the farm, Cody has held leadership positions with the Indiana Beef Cattle Association and Indiana Angus Association. He enjoys spending time with his wife and children, attending livestock shows and coaching their children’s baseball and so ball teams. Cody has sorted stock at the Cattlemen’s Congress, National Western Stock Show (NWSS), North American International Livestock Exposition (NAILE), American Royal, Dixie National Stock Show, San Antonio Stock Show, Houston Livestock Show and Rodeo and various national junior shows and state fairs. He’s judged in more than 27 states and Mexico and Canada.
Born and raised near Hutchinson, Kan., John McCurry is a h generation Angus breeder and lifetime member of the American Angus Association. He grew up competing at Angus shows on all levels and was on the National Junior Angus Association board. John attended Butler Community College and was a member of the livestock judging team. He completed his education at Kansas State University, where he was a member of the national reserve champion livestock judging team.
He returned home to the McCurry Angus Ranch and has since expanded the operation. Early on, McCurry Angus Ranch utilized junior and open shows from coast to coast to market and promote their herd. Now, John and his wife, Melody, and children, Aubree, Molly and Drew, own and operate McCurry Angus Ranch and have hosted 12 annual bull sales, marketing 200 bulls each year.
McCurry is passionate about evaluating and sorting cattle along with encouraging the next generation of agricultural enthusiasts to nd their home within the livestock industry. He has judged multiple national junior shows as well as the American Royal, NAILE, NWSS, Fort Worth Stock Show and San Antonio Stock Show. He is thankful to the junior board, the American Hereford Association Board and Hereford enthusiasts for the opportunity to help evaluate the owned females during JNHE.











Charlie Boyd Jr. owns and operates Boyd Beef Cattle, Mays Lick, Ky., with his wife, Paula, and their two sons, Blake and Logan. e Boyd family has raised Hereford cattle for more than 120 years; Blake and Logan represent the h generation on their Kentucky ranch. Charlie attended the University of Kentucky and received his degree in agricultural economics.
He has held leadership roles in many organizations. Charlie has judged almost every national show and state fair in the country, along with shows in three foreign countries. Charlie has spent a lifetime immersed in the Hereford breed and is a past president of the National Junior Polled Hereford Council.

Blake Boyd resides in Mays Lick, Ky., with his wife, Grace. ey, along with Blake’s family, operate a Hereford and Angus seedstock operation that has been in business for more than 120 years. Boyd Beef Cattle annually hosts three production sales, selling more than 200 head of bulls and females to progressive commercial cattlemen and seedstock producers across the country.
Blake attended Butler Community College and OSU, where he was a member of both nationally competitive livestock judging teams. As a h-generation Hereford breeder, Blake is excited about the progress the breed has made in recent years and believes the future of the breed is bright. He says the Hereford breed’s greatest asset is its outstanding people.
Chan Phillips was born and raised in Maysville, Ky., on a commercial cattle operation. Chan and his brother, Keith, currently operate a Simmental-in uenced cow-calf herd where they utilize AI and embryo transfer extensively. Chan got his start in the Simmental breed at the ripe age of 6 years old in 1972, when he bought his rst Simmental heifer. Chan previously owned and operated Phillips Cattle Co. for 16 years — their crew exhibited multiple national champions at all major expositions. e Phillips family founded Rocking P Livestock in Kentucky, and Chan remains a partner in Rocking P today. Currently, he works as the manager of Circle M Farms in Rockwall, Texas, and Mt. Vernon, Mo.




Chan has judged numerous national breed shows, national junior shows and showmanship competitions across the U.S. and Canada. Chan and his wife, Tonya, have two children, Morgan (Wallace) and A.K., who both remain actively involved in the Simmental, SimAngus and Angus breeds.



































Father-daughter duo, Bob and Lauren May, work together on the family’s show cattle operation May Cattle Co., in Mineral Point, Wis. ey raise and market high-caliber show steers and breeding cattle of all breeds, which compete across the nation at all levels. e family has o en exhibited cattle on the national stage, and Lauren has shown Hereford heifers at the JNHE many times during her junior career.


Today, Lauren resides in Stillwater, Okla., where she works as the event coordinator for the Tulsa State Fair. Her passion for cattle exhibition and the showring led her to this position a er participating in several junior nationals, interning with JG Cattle and Coaching and participating in countless showmanship contests.
Bob lives on the family’s Mineral Point property, where he oversees the day-to-day operations of May Cattle Co., while also serving as a Purina Honor Show Chow and Weaver Leather Show Product ambassador.


Bob and Lauren are honored to stand alongside one another in the showring to evaluate young people who have the same opportunities to develop the skills, con dence and love for the Hereford breed that they have.

Brother and sister, Ty Bayer, Ringle, Wis., and Calli Spengler, Cascade, Iowa, operate TC Reds, an Angus and Red Angus program in central Wisconsin alongside their family. Together, they focus on producing elite show heifers and host an annual bull sale every February. With a 150-head herd, TC Reds has bred and exhibited champions at a local, state and national level.
Ty returned to the family farm a er earning a degree in animal science from Colorado State University, where he was a member of the nationally competitive livestock judging team. His judging career has taken him across the U.S. and Canada, with highlights including the American Royal, Charolais Junior Nationals and the West Texas State Fair.
Calli graduated from Iowa State University with a degree in agricultural communications. She currently serves as the director of business development for Prime Ag. With her husband, Kale, and daughter, Paislee, they own and operate Spengler Cattle in Cascade, where they raise and market high-quality show cattle. Calli remains involved with TC Reds and has judged numerous showmanship competitions at state and national levels, including the National Junior Angus Show.


Kari Brumley, Orovada, Nev., owns and operates Brumley Farms, a registered Hereford and hay operation, alongside her family. ey run approximately 100 registered Hereford females and an aggressive ET and in-vitro fertilization program. She has a passion for good livestock and is involved in all day-to-day operations around the ranch, from breeding decisions to preparing heifer calves for their annual spring and fall sales, to spending long hours in the barn working on show and sale cattle.

Kari is a second-generation Hereford breeder, but her passion for the breed really started when she showed her rst Hereford at 7 years old. Kari exhibited Hereford cattle at state, regional and national shows throughout her time as a National Junior Hereford Association member. One of her fondest memories is being the rst person to win all four age divisions of showmanship at the JNHE.
Kari has a strong passion for education and the cattle industry, teaching elementary school near her hometown. As the 2025 Hereford Herdsman of the Year, Kari and is honored to be a part of the Hereford family.






















































Junior Top Written Score
1st Place Junior Team
2nd Place Junior Team
Senior Top Written Score
1st Place Senior Team


























Junior Division






Senior Division
2nd Place Senior Team , MONDAY, JULY 14









*Awards Ceremony honoring the Hereford Bowl High Individuals and teams will follow the Hereford Bowl Buzzer Round.















































WED SD , JU WEDNESDAY, JULY 16























*Awards Ceremony honoring CHB Cooking Challenge, Photo & Poster, prior to selection of the Bred-and-Owned Top 5
Sponsored by Certified Hereford Beef




Division













Sponsored
Category: Hereford Cattle


Category: Hereford People
























1st












































*Awards Ceremony honoring Future Professionals, Sales, Speech and Judging Contests will follow the selection of the Division 3 Polled Females
Sponsored by Barnes Herefords, Cedartown, Ga.


Intermediate Division
1st Senior Division

Sponsored by National Hereford Women Peewee Division
1st 2nd 3rd Junior Division
1st 2nd 3rd




Sponsored by National Hereford Women
Intermediate


Sponsored by Jensen Livestock Agency Senior Division 1st 2nd 3rd


1st
2nd 3rd

1st 2nd


Sponsored by Central Life Sciences
Peewee Division
Junior Division

3rd Intermediate Division
1st 2nd 3rd Senior Division
1st 2nd 3rd
1st Place Team
2nd Place Team
3rd Place Team
1st Place Team
2nd Place Team
3rd Place Team
1st Place Team
2nd Place Team
3rd Place Team
1st Place Team
2nd Place Team
3rd Place Team
Sponsored by Central Life Sciences
Peewee Division




Junior Division

Intermediate Division


Senior Division




























































































T D , THURSDAY, JULY 17
Y C O A S , R A OO CK CERE O. .


















6 P.M. -

*Awards Ceremony honoring Retiring NJHA Board of Directors, newly elected directors and o cers, HYFA scholarship and NJHA awards recipients.
Welcome: Logan McFatridge, Chairman NJHA
Introduction of Special Guests
NJHA Awards Presentations
NJHA Retiring Addresses
Announcement of NJHA Directors and O cers
Closing Remarks
Chairman - Logan McFatridge
Vice Chairman - Haley Mouser
Communications Chair - Salem Si ord
Membership Chair - Lauren Gatz
Leadership Chair - Harlee Watson
Fundraising Chair - Sam Birdsall



Brooke Aue
Jacob Ball
Kaden Camerlinck
Samantha Campbell
Rianna Chaney
Sheridan Chaney
Jarrett Dalia
Ashlee Demolles
Ray Duncan

Isaac Rhode
Kaylee McInvale
Emma Ballinger
Matt Bruns
Sarah Beth Callicott
Rylie Meinhardt





Sponsored by the Illinois Junior Hereford Association and Edenburn Family Farms
Ian Forbes
Will Freking
Megan Gajdica
Lauren Gatz
Emilea Greathouse
Mary Hannah Gullatt
Sawyer Hake
Allyson Hamilton
Colin Huelsmann

Lauren Jones
Hannah Keith
Alisha Klemme
Megan Mallory
Phillip Mueller
Paige Nichols
Logan Rhoads
Isaac Rhode
Kya Rhodes
Logan Schroeder
JD Seward
Amber Shutsky
Garrison Siedling
Shelby Siemer
Jayden Simpson
Laney Stephens


3rd Grade
4th Grade
5th Grade
6th Grade
7th Grade
8th Grade
9th Grade
10th Grade
11th Grade
Sponsored by National Junior Hereford Association

12th Grade

Sponsored by National Hereford Women



Sponsored by National Hereford Women

$5,000 NATIONAL JUNIOR MERIT SCHOLARSHIP
$5,000 BOB CALL FOUNDERS SCHOLARSHIPS
$2,500 B.C. “BUD” SNIDOW AWARD
$2,500 HEREFORD HERDSMAN SCHOLARSHIPS




$2,500 GOLDEN BULL ACHIEVEMENT AWARDS


$2,500 DONNA CURRY MEMORIAL SCHOLARSHIPS

Chairman

$2,000 NOP FOUNDERS SCHOLARSHIP

$2,000 JOHN WAYNE MEMORIAL SCHOLARSHIP
$2,000 MEAD MEMORIAL SCHOLARSHIP
$2,000 BUCKEYE/BLUEGRASS SCHOLARSHIP
$2,000 CHARLES E. BOYD MEMORIAL SCHOLARSHIP



2025-2026 NATIONAL JUNIOR HEREFORD ASSOCIATION
Communications Chair
Fundraising Chair

OFFICERS AND DIRECTORS
O cers:
Vice Chairman
Leadership Chair
Membership Chair

Directors:


























































Less than 25 Head









*Awards Ceremony recognizing Herdsman of the Year, Walter and Joe Lewis High Point Senior, GKB Super States, Golden Pitchfork and the Bob Norton Excellence Award will be held prior to the champion drives
Sponsored by Sullivan Supply, Matheny Herefords and Hereford Youth Foundation of America (HYFA)




Group of 3 Champion Group of 3 Reserve Champion
Group of 5 Champion
Group of 5 Reserve Champion


















Heat 1

□ 3000 Jessica Mezrano ............ . Columbiana, AL
□ 3002 Griffin Nitsche ............. . Holt, MO
□ 3003 Victoria Wright ............. . Clinton, ME
□ 3004 Pa isley Miller Hopkins, MI
□ 3005 Houston Fowler Carnesville, GA
□ 3006 Emmett Acheson Wichita, KS
□ 3007 Samuel Goldizen ............ . Petersburg, WV
□ 3008 Caroline Studer ............. . Frankfort, KS
□ 3027 Ada Meredith .............. . Hodgenville, KY
Heat 2
□

3009 Ellie Poarch Lewisburg, TN
□ 3010 Will Breiner ................ . Pratt, KS
□ 3011 Elyse Garnhart ............. . German Valley, IL
□ 3012 Emersyn McBride ........... . Shapleigh, ME
□ 3013 Fox Loney Ada, MI
□ 3014 A nnie Everhart Morristown, IN

□ 3015 Ryne Sandberg Agenda, KS
□ 3047 Olivia Young ............... . Lexington, IL
□ 3017 Brooklyn Leinenbach ........ . Holland, IN
Heat 3
□ 3018 Ha nnah Taylor Petersburg, WV
□ 3019 K insley Mullinix Ma nhattan, KS
□ 3020 Macy Michelini ............. . Peru, IL

□ 3021 Reagan Wright ............. . Lebanon, TN
□ 3022 Nolan Beaver ............... . Grandview, TX
□ 3023 K ilee Lovin Lexington, GA
□ 3024 Calob White Gardiner, ME
□ 3025 Graham Creamer Wa xahachie, TX
□ 3026 W hitten Scarpinato Mason, TX
Peewee Semi Finals #1
Exhibitors advancing to Peewee Finals
Heat 4
□ 3028 Stetson Rogers Patrick Springs, VA
□ 3029 Easton Harfst Battle Creek, MI

□ 3037 Jack Rasmussen ............ . Spring Valley, WI
□ 3038 Levi Mobley ................ . Campbellsburg, KY
□ 3039 Bronson Marston ........... . Agenda, KS
□ 3040 Ella Gillespie Toulon, IL
□ 3041 A nna Wagner Hu ll, IA
□ 3042 Olivia Ullom Prosperity, PA
□ 3043 Trace Rhinehart ............ . Thurmont, MD
□ 3044 Adelynn Kuykendall ........ . Graham, TX
□ 3045 Tucker Lawson ............. . Munfordville, KY
□ 3046 Mila Perez Canyon, TX
Heat 6
□ 3016 Reese Sandberg ............. . Agenda, KS
□ 3048 John Owen Starnes .......... . Fort Payne, AL
□ 3049 Sutton Stelzer .............. . Oologah, OK
□ 3050 Jace Murphree Ha milton, TX
□ 3051 Everly Foster Ni les, MI

□ 3030 Sadie Zaenger McCutchenville, OH
□ 3031 Maryann Moore Ha mlin, TX
□ 3032 Nathan Liston .............. . Seville, OH
□ 3033 Bremley Doig ............... . St. Paul, IN
□ 3034 Dorothy Deford ............. . Jarrettsville, MD
□ 3035 Roland Sandberg Agenda, KS
□ 3036 Brooke Day Loup City, NE

□ 3052 Cooper Acheson Wichita, KS
□ 3053 Madelyn Grannis ........... . Flemingsburg, KY
□ 3054 Barrett Carper .............. . Vevay, IN
□ 3055 A lexander Huisheere ........ . Janesville, WI
□ 3056 Conner McQuaig Danielsville, GA
Exhibitors advancing to Peewee Finals
□ 3057 Case Pressnall .............. . Randolph, MN
□ 3058 Piper Seiss ................. . Thurmont, MD
□ 3059 Laynee Greenwood .......... . Ha milton, KS
□ 3060 Kayston Goss Vinton, CA
□ 3061 Nash Lowderman Macomb, IL
□ 3062 Nora Werk Ma nhattan, KS
□ 3064 Cricket Collins Frederick, OK
□ 3065 Jase Lasby .................. . Shelburne, ON, CAN
□ 3066 Madeline Schohr ............ . Oroville, CA
Heat 8

□ 3067 Jake Kenady Plainville, IL
□ 3068 Brant Altman Worthington, MN
□ 3069 Colyer Schaeffer ............ . Hagerstown, IN
□ 3070 Kolter Stithem .............. . Fredonia, KS
□ 3071 Keaton Goss ................ . Vinton, CA
□ 3072 Emerson Walsh Degraff, MN
□ 3073 Hogueland Wade Goldizen Petersburg, WV
□ 3074 Olivia Jones Blue Mounds, WI
□ 3075 Ha rper Ray ................ . Brooksville, KY
□ 3076 Tuck Lowderman ........... . Macomb, IL
Heat 9
□ 3077 Adalynn Grace Blankenship West Burlington, NY
□ 3078 Weston Lampe Petersburg, IL
□ 3079 Ryder Cherry ............... . Jesup, IA
□ 3080 Lucy Kate Sexten ........... . Nicholasville, KY
□ 3081 Trey Toelle ................. . Burwell, NE
□ 3082 Nancy Bing Bonham, TX
□ 3083 Abram Meredith Hodgenville, KY
□ 3084 Kenneth Kypke Loganville, WI
□ 3085 Maren Kolterman ........... . Garland, NE
□ 3086 Adelina Betes .............. . Moses Lake, WA

Heat 10
□ 3087 Avery Wagner Hu ll, IA
□ 3088 Taos Heck Fit zhugh, OK
□ 3089 Mattie Melendrez ........... . Dixon, IL
□ 3090 Chism Harms .............. . Chrisman, IL
□ 3091 Sutter Danekas ............. . Woodland, CA
□ 3092 Brynlee Ann Thompson A mity, MO
□ 3093 Paislee Jane Young Springville, TN
□ 3094 Benjamin Webert Warrenton, VA
□ 3095 Canaan Fink ............... . Wa mego, KS
□ 3096 Koy Gibbs .................. . Junction City, KS

Champion Showman
Reserve Champion Showman
3rd Place
4th Place
5th Place
Heat 1
Peewee Semi Finals #3
Exhibitors advancing to Peewee Finals
6th Place
7th Place
8th Place
9th Place
10th Place

□ 4 000 Benjamin Tammaro Cape Elizabeth, ME
□ 4 001 Blair Buehler Fairbury, NE
□ 4 002 Connelly Ward Oak Grove, MO
□ 4 003 Kendall Devine ............. . Chickasha, OK
□ 4 004 Montana Kenady ........... . Plainville, IL

□ 4 005 Gabriela Rojas .............. . New Boston, MO
□ 4 006 Kaytlyn Harfst Battle Creek, MI
□ 4 007 Caitlyn Edwards Santa Fe, TX
□ 4 008 Mattie Holt Mantachie, MS
□ 4 009 Austin Justus Frederick, MD
Heat 2
□ 4 010 Holden Roeder ............. . Seguin, TX
□ 4 011 Wyatt Weaber Wa mego, KS
□ 4 012 Landon Mansfield Liberty, TN
□ 4 013 Braden McClanahan Waverly, TN
□ 4 014 Evelyn Johnson ............. . Navarre, OH
□ 4 015 R iley Evoniuk .............. . Xenia, OH
□ 4 016 K hloe Toelle ................ . Burwell, NE
□ 4 017 Quinn Breiner Pratt, KS
□ 4 018 Peyton Sidles Buffalo, IL
□ 4 019 Paige Denniston West, TX
Heat 3
□ 4 020 William Webert Warrenton, VA
□ 4 021 Kashlyn Krebs Gordon, NE
□ 4 022 Kaegan O’Leary Brock, TX

□ 4 023 Hunter Barnes .............. . Taylorsville, KY
□ 4 024 Beckett Barber ............. . Channing, TX
□ 4 025 Kora Hawkins .............. . Jane Lew, WV
□ 4 026 Janie Kay Limestone, TN
□ 4 027 A nsley Gee Va le, NC
□ 4 028 Chase Harward Forest Hill, MD
□ 4 029 Marlee Grannis Flemingsburg, KY
Heat 4

□ 4 030 Hayes Devine ............... . Chickasha, OK
□ 4 031 Libby Perez Nara Visa, NM
□ 4 032 Blakely Storey Stockton, IL
□ 4 033 Addison Fritz Westminster, MD
□ 4 034 K insley Bremer ............. . Fullerton, NE
□ 4 035 Lily Beissel ................. . Ha mpton, MN
□ 4 036 Cora Everhart .............. . Morristown, IN
□ 4 037 Davis Ward Oak Grove, MO
□ 4 038 Tinley Harvie Mountain View County, AB, CAN
□ 4 039 Garrett Flohr Danville, IN

Junior Semi Finals #1
Exhibitors advancing to Junior Finals

Heat 5
□ 4 040 Maddi Beissel Ha mpton, MN
□ 4 041 Ella Walsh Degraff, MN
□ 4 042 Vivian Lou Thompson Troy, AL
□ 4 043 Bradyn Greenwood ......... . Ha milton, KS
□ 4 044 Kate Rae Lovin ............. . Lexington, GA

□ 4 045 Maelee Poarch .............. . Lewisburg, TN
□ 4 046 Keaton Kuykendall Graham, TX
□ 4 047 K insey Acheson Hope, KS
□ 4 048 Warren Smith Georgetown, KY
□ 4 049 Maggie Shepard ............ . A ltamont, IL
Heat 6
□ 4 050 Saylor Norvell Tuttle, OK
□ 4 051 Tana Harville Lebanon, TN
□ 4 052 Kadie Jo Hurd Ranger, GA
□ 4 053 Sedona Sifford .............. . Goldvein, VA
□ 4 054 Troy Heath ................. . Cooksville, MD
□ 4 055 Crayton Chapman .......... . Seneca, IL
□ 4 056 Savannah Ritenour Fort Valley, VA
□ 4 057 Reid Tutwiler Mount Sidney, VA
□ 4 058 Clayton Musser Otterbein, IN


Junior Semi Finals #2
Exhibitors advancing to Junior Finals
□ 4 059 Sophia Taylor .............. . Parkton, MD
Heat 7
□ 4 060 Scarlett Ward Corydon, IN
□ 4 062 Hadley Eubank Oblong, IL
□ 4 063 Luke E Hayse Mauckport, IN
□ 4 064 Kallen Evans ............... . Fredonia, KS
□ 4 065 Tessa Everhart .............. . Morristown, IN
□ 4 066 Rylan Hines ................ . Magnolia, KY
□ 4 067 Hoyt Lawrence K ite, GA
□ 4 068 Lauren Crabtree Liberal, MO
□ 4 069 Blake Day Loup City, NE
Heat 8
□ 4 070 Olivia Eubank .............. . Oblong, IL
□ 4 071 Joshua Korzenieski .......... . Hamlin, NY

Heat 9
□ 4 080 Kyler Cooley Dry Creek, LA
□ 4 081 Braxton Carper Vevay, IN
□ 4 082 Ty Anderson Morton, IL
□ 4 083 Ford Howard ............... . Dora, MO
□ 4 084 Huck Gray ................. . K nightstown, IN
□ 4 085Br yce Brancel .............. . Endeavor, WI
□ 4 086 Korbin Swigart Farmer City, IL
□ 4 087 Gentry Gudel Wilton, CA
□ 4 088 Gabe Crutcher Montrose, IL
□ 4 089 Tanner Ostgaard ............ . Newark, OH
□ 4 090 Brayson Mayo Scott City, KS
□ 4 091 Hudson Fleener Gettysburg, PA
□ 4 092 Edynne Bolte Pi keville, TN
□ 4 093 Max McGunegill ............ . Jasper, MN
□ 4 094 Henley Barber .............. . Channing, TX
□ 4 095 Sydney Betes ............... . Moses Lake, WA
□ 4 096 Ava Doig St. Paul, IN
□ 4 097 Levi Womack Pembroke, KY
□ 4 098 Spencer Wright Lebanon, TN
□ 4 099 Trigg Marston .............. . Agenda, KS
□ 4100 Elizabeth Wright Clinton, ME
□ 4101 Hunter Faust Waskom, TX
□ 4102 Beau Knight Comer, GA
□ 4103 Hayden Hoffman ........... . Thedford, NE
□ 4104 Kenzie Hawkins ............ . Jane Lew, WV
□ 4105 Quaid McIntyre ............ . Leedey, OK
□ 4106 Ryan Garnhart German Valley, IL
□ 4107 Madelyn Grace Thompson A mity, MO
□ 4108 Jace Stithem Fredonia, KS
□ 4109 Tripp Earls Hollis, OK

□ 4 072 Caroline Wagner Hu ll, IA
□ 4 073 Griffin Anderson Morton, IL
□ 4 074 Addison Revis Leicester, NC
□ 4 075 Aubrey Lockhart ........... . Somerville, TX
□ 4 076 Jace Schwieterman .......... . Sy racuse, KS
□ 4 077 K inzley Evans .............. . Fredonia, KS
□ 4 078 Bo Todd Mount Vernon, KY
□ 4 079 Peyton Garnhart German Valley, IL

□ 4110 Diana Kate Gillooly Wadley, GA

□ 4111 Delaney Truebenbach K nightstown, IN
□ 4112 Hattie Young Lexington, IL
□ 4113 Josie Harville Lebanon, TN
□ 4114 Shelbi Russell .............. . Franklinton, LA
□ 4115 Emmie White .............. . Springfield, TN
□ 4116 Gage Creamer .............. . Wa xahachie, TX
□ 4117 Ella Deford Jarrettsville, MD
□ 4118 Rylee Cherry Jesup, IA
□ 4119 Wyatt Gunn Greenfield, IN
Exhibitors advancing to Junior Finals
□ 4120 Ella Weldon Piedmont, OK
□ 4121 Kurtis Evoniuk Xenia, OH
□ 4122 Corbin Perry ............... . Tower Hill, IL
□ 4123 R hett Gillespie ............. . Toulon, IL
□ 4124 Madelyn Beaver ............ . Grandview, TX
□ 4125 Brody Greenwood Ha milton, KS
□ 4126 William Sexten Nicholasville, KY
□ 4127 Claire Collins Frederick, OK
□ 4128 Kade Swigart ............... . Farmer City, IL
□ 4129 Jack Begoon ................ . Grottoes, VA
Heat 14
□ 4130 Makenna Smith Hubertus, WI
□ 4131 Josie Beltz Canton, KS
□ 4132 Gage Degroat ............... . Wa ntage, NJ
□ 4133 Addie Bourgeois ............ . Opelousas, LA

□ 4163 Mike Kolterman Garland, NE
□ 4164 Drew Melendrez Dixon, IL
□ 4165 Grant Waters ............... . Norborne, MO
□ 4166 Landry Allan ............... . Nocona, TX
□ 4167 Lena May ................... Greenfield, IN
□ 4168 Tillman Staley Petersburg, TN
□ 4169 Kennady Rasmussen Spring Valley, WI
Heat 18
□ 4170 Landon Deatsman .......... . Leesburg, IN
□ 4171 R hett Day .................. . Telford, TN

□ 4134 Jacob McNaughton .......... . Gravenhurst, ON, CAN
□ 4135 Evlyana Burwell Zanesville, OH
□ 4136 Michael Mezrano Columbiana, AL
□ 4137 Chase Hattan Va rna, IL
□ 4138 Craig Stahoski .............. . Newton, NJ
□ 4139 Eliza Everhart .............. . Morristown, IN
□ 4140 Julie Troyer Pylesville, MD
□ 4141 Lilly Anderson Morton, IL
□ 4142 Briley Fix .................. . Shelbyville, IN
□ 4143 Adelyn Walsh .............. . Degraff, MN
□ 4144 Layton Reames ............. . Culpeper, VA
□ 4145 Bianca Elaine Bevan ......... . Platteville, WI
□ 4146 Lillian Schut Belding, MI
□ 4147 Gabrielle Keets Berlin Heights, OH
□ 4148 Kylan Helms Holbrook, NE
□ 4149 Lyla Harvie ........ Mountain View County, AB, CAN
□ 4150 Gracie Simpson Starr, SC
□ 4151 Rett Blume Pierre, SD
□ 4152 A ndrew Ray Brooksville, KY
□ 4153 Kylee Sadler ................ . Perkins, OK
□ 4154 Madelynn Wright ........... . Clinton, ME
□ 4155 Hayden Helms .............. . Holbrook, NE
□ 4156 Chesney Prinz West Point, NE
□ 4157 Jacqueline Studer Frankfort, KS
□ 4158 Jace Kenady Plainville, IL

□ 4172 Peighton Rhinehart ......... . Thurmont, MD
□ 4173 Natalie Liston Seville, OH
□ 4174 Logan Cady New Windsor, MD
□ 4175 Clark Smith Georgetown, KY
□ 4176 Brooklyn Price ............. . Opelika, AL
□ 4177 Timber Hula ............... . Creston, NE
□ 4178 Corbin Fink ................ . Wa mego, KS
□ 4179 Lexi Schmidt Blue Rapids, KS
Heat 19
□ 4180 Colton Davisson ............ . Calamus, IA
□ 4181 Emma Stephens ............ . Morristown, IN
□ 4182 Madison Bauer ............. . Bonfield, IL
□ 4183 Cache Billman R igby, ID
□ 4184 Owen Crutcher Montrose, IL
□ 4185 Spencer Schmidt Blue Rapids, KS
□ 4186 Ha rper Rose Starnes ........ . Fort Payne, AL

□ 4187 Owen McArthur ............ . Pittsford, MI
□ 4188 Brody Smith ................ Bonham, TX
□ 4189 Garrett Hickey Staunton, VA
□ 4190 Kennedy Hoffman .......... . Thedford, NE
□ 4191 Abigail Snoddy ............. . Grandview, TX
□ 4192 Blair Smith ................ . Godwin, NC
□ 4193 A nthony Mezrano Columbiana, AL
□ 4159 Luke Keith ................. . Campbellsville, KY
Exhibitors advancing to Junior Finals
Heat 17
□ 4160 Lane Cady
New Windsor, MD
□ 4161 Gannon Ward Oak Grove, MO
□ 4162 Jase Klink Garden, MI

□ 4194 Luke Hamlin Weatherford, TX
□ 4195 Braxton Lockhart Caldwell, TX
□ 4196 Hudson Carter Stratford, OK
□ 4197 Mason Mullinix ............ . Ma nhattan, KS
□ 4198 Paislee Van Horn ........... . Morgantown, IN
□ 4199 Geno Milano ............... . East Canton, OH
Heat 21
□ 4200 Parker Irwin Hartshorne, OK

□ 4201 Scott Hickey ............... . Staunton, VA
□ 4202 Avery Stitzlein .............. . Glenmont, OH
□ 4203 Agatha Gervais .............. Sutton, MA
□ 4204 Mack Bunn Z ebulon, NC
□ 4205 Kovin Lewis Ryan, OK
□ 4206 Logan Mansfield Liberty, TN
□ 4207 Tripp Ostgaard ............. . Newark, OH
□ 4208 Charli Moore ............... . Zurich, KS
□ 4209 James Sladek ............... . Iowa City, IA
□ 4210 Peyton Perez Nara Visa, NM

Junior Semi Finals #5
Exhibitors advancing to Junior Finals

Champion Showman
Reserve Champion Showman
3rd Place
4th Place
5th Place
Heat 1

6th Place 7th Place 8th Place
9th Place 10th Place

□ 5000 Clay Lawrence .............. . K ite, GA
□ 5001 Danica Davis Maple Hill, KS
□ 5002 Maggie Reed Green Ridge, MO
□ 5003 Wyatt McIntyre Leedey, OK
□ 5004 A idan Knobloch ............ . Buckingham, IL
□ 5005 Ella Knight ................. . Newton Grove, NC
□ 5006 Ha nnah Harrison ........... . Montague, CA

□ 5007 A nna Towns Dixon Springs, TN
□ 5008 R iley Rhodes Carlinville, IL
□ 5009 Olivia Walsh Degraff, MN
Heat 2
□
5010 Joseph Schohr .............. . Oroville, CA
□ 5011 Keeley Warnken Schulenburg, TX
□ 5012 Pa isley Miller Bellville, TX
□ 5013 Braylen Taylor A lexandria, KY
□ 5014 Kynsleigh Krebs Gordon, NE
□ 5015 Brady Jones ................ . Darlington, WI
□ 5016 Will Beckley ............... . Irvine, KY
□ 5017 Jalen Holt .................. . Mantachie, MS
□ 5018 Ryli Hollis Clyde, TX
□ 5019 Emily Troyer Pylesville, MD
Heat 3


□ 5020 Ella Bane .................. . Towanda, IL
□ 5021 Ha iley Cornett .............. . Hillsboro, OH
□ 5022 Jackson Wright Ewing, NE
□ 5023 Mason Roeder Seguin, TX
□ 5024 Grace Smith Stroudsburg, PA
□ 5025 Cole Dieball ................ . Little River, KS
□ 5026 Blake Brancel .............. . Endeavor, WI
□ 5027 Laurel Mitchell ............. . Taylorsville, NC
□ 5028 Ha llie Hughes Knob Lick, KY
□ 5029 Carly Kolterman Garland, NE

Intermediate Semi Finals #1 Exhibitors advancing to Intermediate Finals
□ 5030 Willie Boyette Angie, LA
□ 5031 Maddox Gunn Greenfield, IN
□ 5032 Danica Rhoads Chrisman, IL
□ 5033 Madyson Rasmussen ........ . Spring Valley, WI
□ 5034 Avery Sweeney ............. . Vinton, IA
□ 5035 Matilda Gervais ............ . Sutton, MA
□ 5036 Laura Landers Franklin A lbertville, AL
□ 5037 Jase Beltz Canton, KS
□ 5038 R iley Bohrer Da mascus, MD
□ 5039 Carlisle Braman ............ . Refugio, TX
□ 5040 Savanah Grimes ............ . Murchison, TX
Heat 5
□ 5041 Caden Perry Tower Hill, IL
□ 5042 Reagan Kasper Poplar Grove, IL
□ 5043 William Meinhardt ......... . Onaga, KS

□ 5044 Marlyn Pecha .............. . Meno, OK
□ 5045 Benton McClanahan ........ . Waverly, TN
□ 5046 R hiannon Conover Wa ntage, NJ
□ 5047 Cooper Miller Newcastle, WY
□ 5048 Wyatt Russell Jackson, MO
□ 5049 Gunnar Gohr Madras, OR
□ 5050 Ryan Oleson ............... . A rkdale, WI
□ 5051 Emma Hancock ............ . Bolivar, MO
Heat 6
□ 5052 Aaron Shriver Grafton, WV
□ 5053 Ashley Alexander Kokomo, IN
□ 5054 Addison Stollard ............ . Sullivan, IL
□ 5055 Gabriel Swallow ............ . Garland, TX
□ 5056 Caleb Pronschinske ......... . Cochrane, WI
□ 5057 Taluan Hall Angie, LA
□ 5058 Martina Alley Danielsville, GA
□ 5059 William Faust Waskom, TX
□ 5060 Avery Rowlett .............. . Cypress Inn, TN
□ 5061 Addison Acheson ........... . Hope, KS
□ 5062 Bryce Gilbert ............... . Markle, IN
Heat 7
□ 5063 Nick Jones Darlington, WI
□ 5064 Delaney Chester ............ . Oregonia, OH
□ 5065 Evan Jackson ............... . Holladay, TN
□ 5066 Landon Fix ................. . Shelbyville, IN

Heat 10
□ 5096 Jackson Massey Pi keville, TN
□ 5097 Kent Lehman Sullivan, IL
□ 5098 Ella Callicott ............... . Only, TN
□ 5099 Addison Young .............. Lexington, IL
□ 5100 Emma Hackbart ............ . Milford, NE
□ 5101 Rae’kyn Rochell Duncan, OK
□ 5102 Nolan Lee Wellington, IL
□ 5103 Jaelyn Koontz T homas, OK
□ 5104 Cruz Colyer ................ . Bruneau, ID
□ 5105 Layton Hopkins ............ . Tribune, KS

□ 5067 Lindie Helsinger Germantown, OH
□ 5068 Elayna Aue Auburndale, WI
□ 5069 Tyler Cole Roberts, IL
□ 5070 Cooper Hattan ............. . Va rna, IL
□ 5071 Gianna Marino ............. . Clarence Center, NY
□ 5072 McKenzie Boyer ............ . Vinita, OK
□ 5073 Charlee Klink Garden, MI
Exhibitors advancing to Intermediate Finals
Heat 8
□ 5074 Abigail Smith .............. . Stroudsburg, PA
□ 5075 Laurel Cornell .............. . Berlin, PA
□ 5076 Trevor Crutcher ............ . Montrose, IL
□ 5077 Lexa Jukes Swainsboro, GA
□ 5078 Grady Carter Stratford, OK
□ 5079 Emma Lynn Purcell, OK
□ 5080 Callie Schmidt Blue Rapids, KS
□ 5081 Elayna Hawkins ............ . Freeport, MI
□ 5082 Emmalee Mueller ........... . Perryville, MO

□ 5106 Grady Creamer ............. . Wa xahachie, TX
Heat 11
□ 5107 Heidi Schwieterman Sy racuse, KS
□ 5108 Sarah Kate Childs ........... . R ipley, MS
□ 5109 Taylor Cole ................. . Roberts, IL
□ 5110 Morgyn Perkins ............ . North Stonington, CT
□ 5111 W. Zeb Murphree Ha milton, TX
□ 5112 Ellen Todd Mount Vernon, KY
□ 5113 Dax Putz Otley, IA
□ 5114 Cierra Collins .............. . Frederick, OK
□ 5115 Mazie Bunn ................ . Z ebulon, NC
□ 5116 Emma Davisson ............ . Calamus, IA
□ 5117 Drew Ballard Inman, KS
Exhibitors advancing to Intermediate Finals

Heat 12
□ 5118 Natalie Brown .............. . Groveport, OH
□ 5119 Mia Walsh ................. . Degraff, MN
□ 5120 A insley Williams ........... . Van Alstyne, TX
□ 5121 Chyloh Billman R igby, ID
□ 5083 A nna Gordon .............. . Worthington, MN
□ 5084 Tessa Smith Hubertus, WI
Heat 9
□ 5085 Hadley Harrison ............ . Montague, CA
□ 5086 Tucker Ostgaard ............ . Newark, OH
□ 5087 Ella Crane ................. . Lasalle, IL
□ 5088 Catie Musser Otterbein, IN
□ 5089 Nick Bernatowicz Tu nnelton, WV
□ 5090 Natalie Pitstick South Solon, OH
□ 5091 Aubrey Landrum ........... . Huntington, IN
□ 5092 Ry ne Allen ................. . Quincy, IL
□ 5093 Addison Duis .............. . Petersburg, IL
□ 5094 Madilyn Norvell Tuttle, OK
□ 5095 Kennedy Rife Columbus Junction, IA

□ 5122 A lyssa Satkowski Columbia, CT
□ 5123 K ian Morris Wilber, NE
□ 5124 Faith Benedict Dewey, IL
□ 5125 Cora Belle Chapman ........ . Seneca, IL
□ 5126 Cody Knaus ................ . Acme, WA
□ 5127 Kyndal Sadler .............. . Perkins, OK
□ 5128 Ryan Tammaro Cape Elizabeth, ME
Heat 13

□ 5129 Jordan Hall ................ . Hustonville, KY
□ 5130 Silas Gullatt ................ . Salem, AL
□ 5131 Shelby Pearl ................ . Duquoin, IL
□ 5132 Rebecca VanCamp Marion, NY
□ 5133 Zoey Violette Sutton, MA
□ 5134 Ryleigh Lancaster Fawn Grove, PA
□ 5135 Jarrett Worrell .............. . Mason, TX
□ 5136 Sadie Wynne ............... . Tuttle, OK
□ 5137 Tymber Billman ............ . R igby, ID
□ 5138 Collin Deatsman Leesburg, IN
□ 5139 Cayden Cronquist Emmett, ID


□ 5140 K insley Atchison Mason, TX
□ 5141 Cooper Weaber Wa mego, KS
□ 5142 Avery Everhart ............. . Morristown, IN
□ 5143 K iera Bremer ............... . Fullerton, NE
□ 5144 Cami Miller ................ . El Dorado, KS
□ 5145 Luke DeSalvo Morrilton, AR
□ 5146 Mary Carter Shirley Sparta, TN
□ 5147 Jordan Mitchem Va le, NC
□ 5148 Miranda Hansen ............ . Checotah, OK
□ 5149 Jorja Ebert ................. . Polo, MO
□ 5150 Scarlet Gervais ............. . Sutton, MA
Heat 15

□ 5151 Ella Fritz Westminster, MD
□ 5152 Jake Parker ................ . Hollis, OK
□ 5153 Callie Harris ............... . Canton, TX
□ 5154 Stetson Storey .............. . Stockton, IL
□ 5155 James Walker Angie, LA
□ 5156 Mattie Flohr Danville, IN
□ 5157 Lily Death Indianola, IL
□ 5158 Peyton Heard .............. . Opelika, AL
□ 5159 Molly Perkins .............. . North Stonington, CT
□ 5160 Tommi Rabel ............... . Lake Park, IA
□ 5161 Sarah Birdsall Torrington, WY
Intermediate Semi Finals #4
Exhibitors advancing to Intermediate Finals

Heat 16
□ 5163 William Tackett ............ . Iola, TX
□ 5164 Blayklee Stelzer ............. . Oologah, OK
□ 5165 Kaylee Revis ............... . Leicester, NC
□ 5166 Luke Fisher Bon Aqua, TN
□ 5167 Luke Marcum Campbellsville, KY
□ 5168 Reese Anderson Jackson, MN
□ 5169 Daniel Richardson Capron, IL
□ 5170 Bella Smith ................ . Bonham, TX
□ 5171 Sara Beth Faust ............. . Oneonta, AL
□ 5172 Mya Colleen Bevan .......... . Platteville, WI

Champion Showman
Reserve Champion Showman
3rd Place
4th Place
5th Place

□ 5173 Emma Lewis Litchfield, OH
□ 5174 Brogan Keltner Pearl City, IL
□ 5176 A lison George .............. . Mondovi, WI
□ 5177 Paislee Lorenzen ............ . Chrisman, IL
□ 5178 A llie Anderson ............. . Morton, IL
□ 5179 Ashley Tutwiler Mount Sidney, VA
□ 5180 Tava Gustafson Junction City, KS
□ 5181 Cadence Harris Salado, TX
□ 5182 Blaine Smith ............... . Russell County, KY
□ 5183 Cooper McNaughton ........ . Gravenhurst, ON, CAN

□ 5184 Lauren Wingler Christiana, TN
□ 5185 W. Marshall Stephens New Windsor, MD
□ 5186 Tenley Stollard ............. . Sullivan, IL
□ 5187 Ha xton Hoffman ........... . Thedford, NE
□ 5188 Preslie Ivy ................. . Seguin, TX
□ 5189 Jayna Blume Pierre, SD
□ 5190 Mallory Hamilton Atlanta, TX

□ 5191 Kylie Holman Hebron, OH
□ 5192 Eva McBride ............... . Shapleigh, ME
□ 5193 Ellie Lehman ............... . Sullivan, IL
□ 5194 Sophia Smith ............... . Georgetown, KY
□ 5195 Emily Fritz Westminster, MD
□ 5196 Wyatt Hooker .............. . Mt. Airy, NC
□ 5197 Rose Hodnett ............... . Wadley, AL
□ 5198 Brinley Davis ............... . Maple Hill, KS
□ 5199 Olivia McArthur ............ . Pittsford, MI
□ 5200 K insley Gillig Blue Rapids, KS
□ 5201 K raiton Carpenter Leedey, OK
□ 5202 Addyson Sweeney Vinton, IA
□ 5203 Quinton Ray ............... . Brooksville, KY
□ 5204 Jillian Johnson ............. . Navarre, OH
□ 5205 Caitlyn Clapper ............. . Magnolia, TX
Intermediate Semi Finals #5
Exhibitors advancing to Intermediate Finals
6th Place
7th Place
8th Place
9th Place

10th Place
Heat 1
□ 6000 Kendall Boatman ........... . Rockford, IL
□ 6001 Phillip Mueller ............. . Perryville, MO
□ 6002 Jarrett Dalia ................ . Vancouver, WA
□ 6003 Ha rlee Watson Flemingsburg, KY
□ 6004 Kaitlyn Keith Campbellsville, KY
□ 6005 Ashlee DeMolles A mes, IA
□ 6006 Sage Lawrence .............. . Avilla, IN
□ 6007 Kaylie Shelton .............. . Le Roy, IL
□ 6008 Baylee Smith ............... . Checotah, OK
Heat 2

□ 6009 Sam Birdsall Torrington, WY
□ 6010 Maddie Jenkins ............. . At hens, TX
□ 6011 Jordan Lamb ............... . Wilson, WI
□ 6012 Mary Warden .............. . Ha lfway, MO
□ 6013 Tessa Booco Hayden, CO
□ 6014 Charleigh Birdsell Ennice, NC
□ 6015 Megan Gajdica Emory, TX
□ 6016 Suter Clark ................. . Gretna, VA
□ 6017 Logan Rhoads .............. . Chrisman, IL
□ 6018 Macalie Forrest ............. . Foster, RI
□ 6019 Ha nnah Pembrook Beggs, OK
Heat 3
□ 6020 Reed Naughton ............. . Atlanta, IL
□ 6021 Jacob Fiscus ................ . Oblong, IL
□ 6022 McKenna Gatz .............. . Fairview, KS
□ 6023 Sadie Holman Hebron, OH
□ 6024 Morgan Richardson Capron, IL
□ 6025 A llyson Hamilton Atlanta, TX
□ 6026 Tanner Mantooth Danielsville, GA
□ 6027 Sawyer Hake ............... . Edgerton, OH
□ 6028 Sarah Callicott ............. . Only, TN
□ 6029 Macy Macke ............... . Lake City, IA
Heat 4
□ 6030 R ianna Chaney Keymar, MD
□ 6031 Si mon Shepard ............. . A ltamont, IL
□ 6041 Addison Koontz ............ . T homas, OK
□ 6042 T.R. Putz .................. . Otley, IA
□ 6043 Carlee Musser .............. . Otterbein, IN
□ 6044 Cady Pieper Zurich, KS
□ 6045 Kya Rhodes Ada, OK
□ 6046 Ashlyn Tingle Eminence, KY
□ 6047 Logan Schroeder ............ . Pella, IA
□ 6048 Brea Musser ................ . Pearl City, IL


□ 6049 Ha nnah Oleson ............. . A rkdale, WI
□ 6050 Kaleigh McNaughton Gravenhurst, ON, CAN
□ 6051 Elizabeth Schaub Thosby, AB, CAN
Heat 6
□ 6052 A idyn Barber ............... . Channing, TX
□ 6053 Ella Brooks ................ . Prophetstown, IL
□ 6054 Kaden Camerlinck Leonardville, KS
□ 6055 Bella Pressnall Randolph, MN
□ 6056 Dawson Ramsdell Limington, ME
□ 6057 Connor McNaughton ........ . Gravenhurst, ON, CAN
□ 6058 Addison Ward .............. . Oak Grove, MO
□ 6059 Luke Bergeron .............. . Belchertown, MA
□ 6060 Lauren Gatz Fairview, KS
□ 6061 Atley Kleinman Wentworth, MO
□ 6062 Ha rrison Roberts Wi lliamsburg, MA
Heat 7

□ 6063 A lexsys Hammond .......... . K inmundy, IL
□ 6064 Serena Anderson Dunbar, PA
□ 6065 A mber Shutsky Pinnacle, NC
□ 6066 Madison Perkins North Stonington, CT
□ 6067 Connor Rhoads Chrisman, IL
□ 6068 Sheridan Chaney ........... . Keymar, MD
□ 6069 Marissa Perkins ............ . North Stonington, CT
□ 6071 Salem Sifford ............... . Goldvein, VA
□ 6032 Morgan Riley ............... . College Grove, TN
□ 6033 Ian Forbes ................. . Churchville, MD
□ 6034 Tory Miller Lebanon, MO
□ 6035 Brenna Perkins Sulphur, KY
□ 6036 Colton Peterson Roanoke, IL
□ 6037 Matthew Elzemeyer ......... . R ichmond, IN
□ 6038 Makayla Massey ............ . London, KY
□ 6039 Landon Hall ................ . Bolt, WV
□ 6040 Naomi Sinnamon Kokomo, IN
Exhibitors advancing to Senior Finals

□ 6072 Ha nnah Keith Campbellsville, KY
□ 6073 Madailein Beard Albany, TX
Heat 8
□ 6074 Rylie Meinhardt ............ . Onaga, KS
□ 6075 Dagan Murray .............. . Auburn, KS
□ 6076 Koble Lewis Ryan, OK
□ 6077 Dustin Denton Blue Rapids, KS
□ 6078 Katie Cox McNab Braeside, ON, CAN

□ 6079 Morgan Firlus .............. . Wonewoc, WI
□ 6080 Mary Elliott Martin ......... . Opelika, AL
□ 6081 Garrison Siedling ........... . Cedar Grove, IN
□ 6082 Emma Ballinger Mckee, KY
□ 6083 Mackenzie Perkins North Stonington, CT
□ 6084 Mackenzie Ramsdell Limington, ME
Exhibitors advancing to Senior Finals


Heat 9
□ 6085 Isabella Hewitt Branchville, NJ
□ 6086 Elaina Walsh Godfrey, IL
□ 6087 Kaylee Knaus ............... . Ferndale, WA
□ 6088 Paxton Hovley .............. . Payette, ID
□ 6089 Samantha Campbell ......... . Eaton, CO
□ 6090 Kylie Hurd Ranger, GA
□ 6091 Foster Wingler Christiana, TN
□ 6092 Daisy Brown Smithfield, NC
□ 6093 Ty Pezanoski ............... . Peru, IL
□ 6094 Garth McIntyre ............. . Gravenhurst, ON, CAN
□ 6095 Rylee Stockdale ............. . Dayton, PA
Heat 10

□ 6096 Megan Mallory Madison, VA
□ 6097 Julia Studer ................ . Frankfort, KS
□ 6098 Emma Lawrence ............ . K ite, GA
□ 6099 Madelyn Weaber ............ . Wa mego, KS
□ 6100 Jess Miller Lakeville, OH
□ 6101 Gunner Whitehead Townsend, DE
□ 6102 Mary Hannah Gullatt Salem, AL
□ 6103 John Crane ................. . Lasalle, IL
□ 6104 Jalyn Davis ................. . Maple Hill, KS
□ 6105 Ray Duncan ................ . Wingate, IN
□ 6106 Lauren Jones Darlington, WI
Heat 11
□ 6107 Bryliee Miller .............. . Grantsville, MD

□ 6108 Brooke Aue ................ . Auburndale, WI
□ 6109 Lute Judy .................. . Ottumwa, IN
□ 6110 Paige Nichols ............... . O vid, MI
□ 6111 Madelyn Ramsdell Limington, ME
□ 6112 Carly Wheeler Templeton, CA
□ 6113 Shawn Crutcher Montrose, IL
□ 6114 Morgan Fuhriman .......... . Pa rma, ID
□ 6115 Jebediah Painter ............ . Gandeeville, WV
□ 6116 Makayla Simmermon ....... . Colman, SD
□ 6119 Isaac Rhode Stewartsville, MO
Champion Showman
Reserve Champion Showman
3rd Place
4th Place
5th Place


□ 6117 Erica Shutsky Pinnacle, NC
□ 6118 Cally Miller El Dorado, KS
□ 6120 Tyree Figge ................. . Onaga, KS
□ 6121 Beau Ann Graves ........... . Chillicothe, MO
□ 6122 Kerrigan Bauserman ........ . Strasburg, VA
□ 6123 Gavin Rhode Stewartsville, MO
□ 6124 Isaac Siedling Cedar Grove, IN
□ 6125 Devon Lockhart Caldwell, TX
□ 6126 Paige Lemenager ............ . Hudson, IL
□ 6127 R ileigh Mears .............. . Cleveland, AL
□ 6128 Blair Heath ................ . Mt. Airy, MD

□ 6129 Reeve Wagner Ha mpton, IA
□ 6130 Kade Boatman ............. . Rockford, IL
□ 6131 A lisha Klemme ............. . Plymouth, WI
□ 6132 Grant Helsinger ............ . Germantown, OH
□ 6133 Payton Zepp Westminster, MD
□ 6134 Clayton Hayes Ada, OK
□ 6135 Jayden Simpson Roachdale, IN
□ 6136 Jacob Ball .................. . Oro-Medonte, ON, CAN
□ 6137 Izzy Bohrer ................ . Da mascus, MD
□ 6138 Karsyn Kleeman ............ . Braymer, MO
□ 6139 Delaney Figge Onaga, KS
Senior Semi Finals #3 Exhibitors advancing to Senior Finals
6th Place
7th Place

8th Place
9th Place

10th Place















3 4/28/2023
OWNED BY: BEAU ANN GRAVES, CHILLICOTHE, MO
5 4/5/2023
MARKSMAN APRIL 301 44457704 KLD RW MARKSMAN D87 ET 5.7 58
OWNED BY: WILLIAM
BY: ALISON GEORGE, MONDOVI, WI
KINSLEY BREMER, FULLERTON, NE
CARLISLE BRAMAN- REFUGIO, TX BRED BY:
DIAMONDS FLO 6626 OWNED BY: CARLISLE BRAMAN, REFUGIO, TX
11
12
OWNED BY: KINSLEY BREMER, FULLERTON, NE
13 3/3/2023 SC R125 COLLIE GIRL Z128 ET 44632273
OWNED BY: BROOKLYN LEINENBACH, HOLLAND, IN
OWNED BY: MORGAN RILEY, COLLEGE GROVE, TN
15 2/25/2023 BLME ANGEL 503L ET
OWNED BY: RETT BLUME, PIERRE, SD JAYNA BLUME, PIERRE, SD
OWNED BY: BRONSON MARSTON, AGENDA, KS
TRIGG MARSTON, AGENDA, KS
PCC 7009 173D
BIRDWELL
KINSLEY JEAN GILLIG- BLUE RAPIDS, KS BRED
OWNED BY: KINSLEY JEAN GILLIG, BLUE RAPIDS, KS
18 2/20/2023 GILLY 94L 44466456 FTZS
BY: KYLIE GILLESPIE, TOULON, IL
OWNED BY: WILL BREINER, PRATT, KS QUINN BREINER, PRATT, KS
OWNED BY: LEVI WOMACK, PEMBROKE, KY
21
22
OWNED BY: KINZLEY EVANS, FREDONIA, KS
KALLEN EVANS, FREDONIA, KS
OWNED BY: KYA RHODES, ADA, OK
23
OWNED BY: TRAVIS MALLORY, MADISON, VA MEGAN MALLORY, MADISON, VA
24
OWNED BY: MORGAN FIRLUS, WONEWOC, WI
25
OWNED BY: BRAXTON LOCKHART, CALDWELL, TX
26
OWNED BY: ADDISON DUIS, PETERSBURG, IL
HOTTIE'S LITTLE
27 5/9/2022
OWNED BY: MAZIE BUNN, ZEBULON, NC MACK BUNN, ZEBULON, NC
28 2/15/2022 EF LADY QUEEN
BY: KIERA BREMER, FULLERTON, NE
KINSLEY BREMER, FULLERTON, NE
31
32
BY: TYMBER BILLMAN, BLACKFOOT, ID
OWNED BY: KHLOE TOELLE, BURWELL, NE
33 4/3/2021 EML SNOWY'S EASTERLILY
EMMA LAWRENCE- KITE, GA
BY: EMMA LAWRENCE, KITE, GA
OWNED BY: LIBBY PEREZ, TEXLINE, TX PEYTON PEREZ, TEXLINE, TX
35
OWNED BY: SHAWN CRUTCHER, MONTROSE, IL
OWNED BY: JASE BELTZ, CANTON, KS
JOSIE BELTZ, CANTON,
OWNED BY: KIERA BREMER, FULLERTON, NE KINSLEY BREMER, FULLERTON, NE
OWNED BY: EMMA LEWIS, LITCHFIELD, OH
Class 002 — Owned Cow-Calf Pairs (Calved 3/22/2015 through 7/5/2023)
OWNED BY: PEYTON GARNHART, GERMAN VALLEY, IL
ELYSE GARNHART, GERMAN VALLEY, IL
RYAN GARNHART, GERMAN VALLEY, IL
OWNED BY: ADALYNN GRACE BLANKENSHIP, WEST BURLINGTON, NY
42 5/26/2023
OWNED BY: JACOB FISCUS, OBLONG, IL
43 5/12/2023 H BL
OWNED BY: HAYDEN MARIE HOFFMAN, THEDFORD, NE
44 5/2/2023
OWNED BY: KYLIE GILLESPIE, TOULON, IL
45 4/25/2023 MAV BLESSED
OWNED BY: COLTON DAVISSON, CALAMUS, IA EMMA DAVISSON, CALAMUS, IA
46
OWNED BY: KAYLEE REVIS, LEICESTER, NC ADDISON REVIS, LEICESTER, NC
47 4/15/2023 SCHAF 11L LITTLE BIRD 304L
BY: TIMBER HULA, CRESTON, NE
48 4/12/2023
OWNED BY: SUTER CLARK, GRETNA, VA
OWNED BY: LAUREN JONES, DARLINGTON, WI
BRADY JONES, DARLINGTON, WI NICHOLAS JONES, DARLINGTON, WI
OWNED BY: EASTON HARFST, BATTLE CREEK, MI
KAYTLYN HARFST, BATTLE CREEK, MI
OWNED BY: ELAYNA AUE, AUBURNDALE, WI
BROOKE AUE, AUBURNDALE, WI
OWNED BY: ADALYNN GRACE BLANKENSHIP, WEST BURLINGTON, NY
WI
OWNED BY: RHETT DAY, TELFORD, TN
OWNED BY: JARRETT SHANE WORRELL, MASON, TX
MACKENZIE RAMSDELL, LIMINGTON, ME
OWNED BY: OLIVIA WALSH, DEGRAFF, MN
OWNED BY: TESSA BOOCO, HAYDEN, CO
62
OWNED BY: MARTINA ALLEY, DANIELSVILLE, GA
OWNED BY: PEYTON GARNHART, GERMAN VALLEY, IL
ELYSE GARNHART, GERMAN VALLEY, IL
RYAN GARNHART, GERMAN VALLEY, IL
OWNED BY: KYLA ANDERSON, DUNBAR, PA
SERENA ANDERSON, DUNBAR, PA
OWNED BY: MASON ROEDER, SEGUIN, TX
PA
OWNED BY: FAITH BENEDICT, DEWEY, IL
OWNED BY: COLTON DAVISSON, CALAMUS, IA EMMA DAVISSON, CALAMUS, IA
OWNED BY: FOX LONEY, ADA, MI
67 2/9/2023
OWNED BY: TAYLOR KENDALL BOATMAN, ROCKFORD, IL THOMAS KADE BOATMAN, ROCKFORD, IL
OWNED BY: KAYSTON GOSS, VINTON, CA KEATON GOSS, VINTON, CA
70
BRED BY:
JORDAN JOHNSON- FORT DODGE, IA
OWNED BY: RAYNE WAGNER, HAMPTON, IA
REEVE WAGNER, HAMPTON, IA
OWNED BY: JOHANNA STUDER, FRANKFORT, KS
JULIA STUDER, FRANKFORT, KS
JACQUELINE STUDER, FRANKFORT, KS CAROLINE STUDER, FRANKFORT, KS
71 2/6/2023
OWNED BY: STETSON STOREY, STOCKTON, IL BLAKELY STOREY, STOCKTON, IL
72
OWNED BY: DUSTIN D DENTON, BLUE RAPIDS, KS
OWNED BY: ELIZA EVERHART, MORRISTOWN, IN
74 1/31/2023
OWNED BY: PEYTON PEREZ, TEXLINE, TX LIBBY PEREZ, TEXLINE, TX
OWNED BY: GUNNER WHITEHEAD, TOWNSEND, DE
OWNED BY: TAYLOR KENDALL BOATMAN, ROCKFORD, IL THOMAS KADE BOATMAN, ROCKFORD, IL
1/27/2023
OWNED BY: LUKE FISHER, BON AQUA, TN
BRED BY:
GREEN DORR FARMS- ELSIE, MI
OWNED BY: CORBIE GREEN, ELSIE, MI
79
OWNED BY: QUINTON RAY, BROOKSVILLE, KY
HARPER RAY, BROOKSVILLE, KY
ANDREW RAY, BROOKSVILLE, KY
OWNED BY: SARAH CHILDS, RIPLEY, MS
BY:
OWNED BY: FORD HOWARD, DORA, MO
MOUNTAIN GROVE, MO
OH
OWNED BY: PIPER SEISS, THURMONT,
OWNED BY: KHLOE TOELLE, BURWELL, NE
OWNED BY: HOLDEN ROEDER, SEGUIN, TX
OWNED BY: KEELEY WARNKEN, SCHULENBURG, TX
1/7/2023
WICHITA, KS
OWNED BY: JORDAN MITCHEM, VALE, NC
OWNED BY: CHARLEIGH BIRDSELL, ENNICE, NC 89
RYAN JENSEN- COURTLAND, KS
OWNED BY: CORBIE GREEN, ELSIE, MI
90
OWNED BY: ADDIE BOURGEOIS, OPELOUSAS, LA
OWNED BY: KHLOE TOELLE, BURWELL, NE TREY TOELLE, BURWELL, NE
OWNED BY: MICHAEL MEZRANO, COLUMBIANA, AL
OWNED BY: LANDON HALL, BOLT, WV
94
OWNED BY: LUKE BERGERON, BELCHERTOWN, MA
95 10/1/2022 BLL WW BW
OWNED BY: WILLIAM WEBERT, WARRENTON, VA
BENJAMIN WEBERT, WARRENTON, VA
9/22/2022
OWNED BY: NATALIE LISTON, SEVILLE, OH
NATHAN LISTON, SEVILLE, OH
832F 41E KAILEE 23K ET
9/1/2022
DEAN- ARODA, VA
OWNED BY: SEDONA SIFFORD, GOLDVEIN, VA
SALEM EMALINE SIFFORD, GOLDVEIN, VA
OWNED BY: MAZIE BUNN, ZEBULON, NC MACK BUNN, ZEBULON, NC
99
OWNED BY: COOPER HATTAN, VARNA, IL CHASE HATTAN, VARNA, IL
100
HAWES- ATHENS, TX BRED BY:
OWNED BY: CHESNEY PRINZ, WEST POINT, NE
101
OWNED BY: LEVI WOMACK, PEMBROKE, KY
102 4/1/2022
WSCC VH
OWNED BY: QUINTON RAY, BROOKSVILLE, KY
HARPER RAY, BROOKSVILLE, KY
ANDREW RAY, BROOKSVILLE, KY
OWNED BY: OWEN MCARTHUR, PITTSFORD, MI
OWNED BY: PAIGE NICHOLS, OVID, MI
OWNED BY: HUCK GRAY, KNIGHTSTOWN, IN
106 1/30/2022
BY: KIAN MORRIS, WILBER, NE
OWNED BY: LANDON FIX, SHELBYVILLE, IN
OWNED BY: TIMBER HULA, CRESTON, NE
109
OWNED BY: ASHLYN TINGLE, EMINENCE, KY
110 1/3/2022 WILDCAT CLEMENTINE 2117 ET
OWNED BY: BROOKE AUE, AUBURNDALE, WI
ELAYNA AUE, AUBURNDALE, WI
111 1/3/2022
OWNED BY: ANNA WAGNER, HULL, IA
CAROLINE JEAN WAGNER, HULL, IA
AVERY WAGNER, HULL, IA
112
OWNED BY: FAITH BENEDICT, DEWEY, IL
113
114
OWNED BY: EMMA HACKBART, MILFORD, NE
5/5/2021 HAWK LUCIA 34J
OWNED BY: DELANEY CHESTER, OREGONIA, OH
115 5/2/2021 HARKERS BELLE J147 44287757 UPS
OWNED BY: HUCK GRAY, KNIGHTSTOWN, IN
OWNED BY: MATTHEW NICHOLS, OVID, MI
OWNED BY: AUBREY LOCKHART, SOMERVILLE, TX
OWNED BY: EASTON HARFST, BATTLE CREEK, MI
KAYTLYN HARFST, BATTLE CREEK, MI
OWNED BY: ALISHA KLEMME, PLYMOUTH, WI 120
PAIGE LEMENAGER- HUDSON, IL BRED BY:
OWNED BY: NOLAN F LEE, WELLINGTON, IL
121
OWNED BY: KIAN MORRIS, WILBER, NE
OWNED BY: KIERA BREMER, FULLERTON, NE
BY: CORBIE GREEN, ELSIE, MI
KIAN MORRIS, WILBER, NE
JR 2296 SKITTLES 921 ET
128 2/8/2019
BY:
TREVOR STOCK LOCKHART- CALDWELL, TX
OWNED BY: BRAXTON LOCKHART, CALDWELL, TX
TREVOR STOCK LOCKHART, CALDWELL, TX
AUBREY LOCKHART, SOMERVILLE, TX
DEVON ELIZABETH LOCKHART, CALDWELL, TX
129 1/12/2019 KJ BJ 719Z VELVET G65
OWNED BY: CALLY MILLER, EL DORADO, KS
CAMI MILLER, EL DORADO, KS
130 11/8/2018 BROOKWOOD
OWNED BY: MARY CARTER SHIRLEY, SPARTA, TN
131 10/15/2018 GDF HOMETOWN QUEEN
BY: CORBIE GREEN, ELSIE, MI
132 10/6/2018 FCC AUTUMN BOW 43986179 DL MILO
FLOHR FAMILY FARM- DANVILLE, IN
BY: CHARLES GARRETT FLOHR, DANVILLE, IN
OWNED BY: MARY CARTER SHIRLEY, SPARTA, TN
134 3/17/2018 L TM SEDONA 184 44017803 CHURCHILL SENSATION 028X
OWNED BY: ELLA BANE, TOWANDA, IL
135 2/11/2018
OWNED BY: JAMES KYPKE, LOGANVILLE, WI KENNETH KYPKE, LOGANVILLE, WI
OWNED BY: TAVA GUSTAFSON, JUNCTION CITY, KS
OWNED BY: RETT BLUME, PIERRE, SD JAYNA BLUME, PIERRE, SD
OWNED BY: NOLAN F LEE, WELLINGTON, IL
OWNED BY: LAUREN JONES, DARLINGTON, WI
BRADY JONES, DARLINGTON, WI
NICHOLAS JONES, DARLINGTON, WI
OWNED BY: SEDONA SIFFORD, GOLDVEIN, VA SALEM EMALINE SIFFORD, GOLDVEIN, VA
OWNED BY: JORJA EBERT, POLO, MO
142 5/29/2024 3-HAWK
OWNED BY: KORA HAWKINS, JANE LEW, WV
BY: LAYTON HOPKINS, TRIBUNE, KS
OWNED BY: KINSEY ACHESON, HOPE, KS
145
OWNED BY: EASTON HARFST, BATTLE CREEK, MI
146
OWNED BY: SCARLET GERVAIS, SUTTON, MA
147 5/5/2024 ECR RELIANCE
OWNED BY: MAKAYLA SIMMERMON, COLTON, SD
148 5/4/2024
OWNED BY: CALLIE F SCHMIDT, BLUE RAPIDS, KS
149 5/3/2024
OWNED BY: PRESLIE IVY, SEGUIN, TX
150 5/2/2024 SEL
OWNED BY: RIGGIN ROSE GOINGS, ROYAL CENTER, IN SHAYLEE ANN GOINGS, ROYAL CENTER, IN
151 5/1/2024
OWNED BY: TYLER COLE, ROBERTS, IL
TAYLOR COLE, ROBERTS, IL
152
OWNED BY: DUSTIN D DENTON, BLUE RAPIDS, KS
153
BY: KINSLEY JEAN GILLIG, BLUE RAPIDS, KS
154
BY: ISABELLA HEWITT, BRANCHVILLE, NJ
155
156
OWNED BY: KYLIE GILLESPIE, TOULON, IL ELLA GILLESPIE, TOULON, IL
157
OWNED BY: LANDON FIX, SHELBYVILLE, IN
158
OWNED BY: TAVA GUSTAFSON, JUNCTION CITY, KS
159 4/20/2024
OWNED BY: GENO MILANO, EAST CANTON, OH
160 4/17/2024 MF3C
OWNED BY: ERICA SHUTSKY, PINNACLE, NC AMBER SHUTSKY, PINNACLE, NC
161
OWNED BY: BRONSON MARSTON, AGENDA, KS
TRIGG MARSTON, AGENDA, KS
162 4/12/2024
OWNED BY: LILLY ANDERSON, MORTON, IL
163 4/11/2024
164
BY: CALLIE F SCHMIDT, BLUE RAPIDS, KS
165
166
OWNED BY: COOPER MILLER, NEWCASTLE, WY
167 4/10/2024 GMC
OWNED BY: KAYLIE NICOLE SHELTON, LEROY, IL
168 4/9/2024 MCS YB
OWNED BY: MARY CARTER SHIRLEY, SPARTA, TN
169 4/3/2024 JRR 014H MR CATAPULT
OWNED BY: LILY BEISSEL, HAMPTON, MN MADDISON BEISSEL, HAMPTON, MN
170
OWNED BY: BLAKE DAY, LOUP CITY, NE BROOKE DAY, LOUP CITY, NE
OWNED BY: DELANEY FIGGE, ONAGA, KS TYREE E FIGGE, ONAGA, KS
OWNED BY: GABRIELA ROJAS, NEW BOSTON, MO
173
OWNED BY: SOPHIA STITZLEIN, GLENMONT, OH AVERY STITZLEIN, GLENMONT, OH
174 3/28/2024
OWNED BY: BRAYSON MAYO, SCOTT CITY, KS
OWNED BY: RYAN GARNHART, GERMAN VALLEY, IL
OWNED BY: TAVA GUSTAFSON, JUNCTION CITY, KS
177 3/24/2024
OWNED BY: TREY TOELLE, BURWELL, NE KHLOE TOELLE, BURWELL, NE
178
OWNED BY: KIAN MORRIS, WILBER, NE
179 3/21/2024 ALA 108 BLAZER
OWNED BY: COOPER GENE ACHESON, WICHITA, KS EMMETT ACHESON, WICHITA, KS
180
OWNED BY: EMMA DAVISSON, CALAMUS, IA
181 3/20/2024
OWNED BY: ELIZABETH WRIGHT, CLINTON, ME
182 3/18/2024 CJH GEORGE 453 44616802
BY: CLAYTON HEINS, NEW SALEM, ND
183
OWNED BY: LACIE SELLERS, FULTS, IL
184
OWNED BY: EMILY TROYER, PYLESVILLE, MD
185
186
OWNED BY: COOPER BISHOP WEABER, WAMEGO, KS MADELYN WEABER, WAMEGO, KS WYATT WEABER, WAMEGO, KS
KS
OWNED BY: WILL BREINER, PRATT, KS
187 3/16/2024
62 29 95 GE_EPDs CORA BELLE CHAPMAN- SENECA, IL BRED BY:
OWNED BY: CORA BELLE CHAPMAN, SENECA, IL
188 3/16/2024
OWNED BY: KYLIE GILLESPIE, TOULON, IL
189 3/16/2024
OWNED BY: FOX LONEY, ADA, MI
190 3/15/2024 JB MICKEY 26M 44615043
OWNED BY: JASE BELTZ, CANTON, KS JOSIE BELTZ, CANTON, KS
191 3/15/2024 RGR SHAKA 15M ET 44603597
BY: RIGGIN ROSE GOINGS, ROYAL CENTER, IN
192
193
194
OWNED BY: COLTON PETERSON, ROANOKE, IL
3/13/2024
BY: AUSTIN JUSTUS, FREDERICK, MD
OWNED BY: W. MARSHALL STEPHENS, NEW WINDSOR, MD
195
OWNED BY: AMBER SHUTSKY, PINNACLE, NC ERICA SHUTSKY, PINNACLE, NC
196
OWNED BY: COLTON DAVISSON, CALAMUS, IA
197 3/9/2024 SILO H18 BEEFCAKE 2417 ET
64 29 108
LOGAN CADY- NEW WINDSOR, MD BRED BY:
OWNED BY: LOGAN CADY, NEW WINDSOR, MD
198
199
OWNED BY: ADELYN WALSH, DEGRAFF, MN
3/7/2024 BANE LIGHTNING
OWNED BY: ELLA BANE, TOWANDA, IL
GGSC SLIM SHADY 12M ET
200 3/7/2024
OWNED BY: ELLA ELIZABETH DEFORD, JARRETTSVILLE, MD
201 3/7/2024 MWT 561C COSMO
OWNED BY: COOPER HATTAN, VARNA, IL CHASE HATTAN, VARNA, IL
202 3/6/2024
OWNED BY: EMILY FRITZ, WESTMINSTER, MD
204 3/5/2024 FCCH
OWNED BY: LAUREN JONES, DARLINGTON, WI BRADY JONES, DARLINGTON, WI NICHOLAS JONES, DARLINGTON, WI
OWNED BY: ADDISON REVIS, LEICESTER, NC
206
207
OWNED BY: LAUREN JONES, DARLINGTON, WI
BRADY JONES, DARLINGTON, WI
NICHOLAS JONES, DARLINGTON, WI
COOKSVILLE, MD BRED BY:
OWNED BY: TROY HEATH, COOKSVILLE, MD
208
OWNED BY: AIDAN KNOBLOCH, BUCKINGHAM, IL
209
OWNED
OWNED BY:
OWNED BY: MATTIE FLOHR,
OWNED BY: MATILDA GERVAIS, SUTTON, MA
213
OWNED BY: MIA WALSH, MURDOCK, MN
214 2/23/2024 HFJ TITAN 44594962 HFR JCG AUGUSTUS 286W 1818 ET 3.8 52 15 86
GE_EPDs JACOB WIECHART- FT. JENNINGS, OH BRED BY:
OWNED BY: AVERY STITZLEIN, GLENMONT, OH
216 2/22/2024 KESL GUMBY 81M 44597114 FTZS DIGNIFIED 104J KESLER COLLINS- FLANAGAN, IL BRED BY:
PURPLE VERONICA 27G ET OWNED BY: EVA MCBRIDE, GARDINER, ME
217
OWNED BY: SOPHIA TAYLOR, PARKTON, MD
218
219
220
OWNED BY: LILY BEISSEL, HAMPTON, MN MADDISON BEISSEL, HAMPTON, MN
GABE DEWITT- BLAKESBURG, IA BRED BY:
OWNED BY: AUSTIN JUSTUS, FREDERICK, MD
2/18/2024 GSF OLIVIA
OWNED BY: PEIGHTON RHINEHART, THURMONT, MD
4LEAF BRUSSEL SPROUT
221 2/17/2024
OWNED BY: MAKENNA SMITH, HUBERTUS, WI
222 2/16/2024 MCS YB ACE 224 44601091
OWNED BY: BRAYSON MAYO, SCOTT CITY, KS
223 2/14/2024 BROOKWOOD WILDCAT 417 44595692 BROOKWOOD WAM HISTORIC
OWNED BY: BRINLEY DAVIS, MAPLE HILL, KS
DANICA DAVIS, MAPLE HILL, KS
JALYN DAVIS, MAPLE HILL, KS
224
2/14/2024 DUNK
BY: HUDSON FLEENER, GETTYSBURG, PA
BY: RHETT GILLESPIE, TOULON, IL
BY: JULIE TROYER, PYLESVILLE, MD
227
OWNED BY: LANE CADY, NEW WINDSOR, MD
228
229
OWNED BY: WYATT MCINTYRE, LEEDEY, OK QUAID MCINTYRE, LEEDEY, OK
KINSLEY JEAN GILLIG- BLUE RAPIDS, KS BRED BY:
OWNED BY: LEXI SCHMIDT, BLUE RAPIDS, KS
230
OWNED BY: LUKE E HAYSE, MAUCKPORT, IN
232 1/26/2024 TKCC
OWNED BY: KHLOE TOELLE, BURWELL, NE TREY TOELLE, BURWELL, NE
233 1/21/2024
OWNED BY: MADELYN GRACE THOMPSON, AMITY, MO BRYNLEE ANN THOMPSON, AMITY, MO
234
OWNED BY: LILLIAN SCHUT, BELDING, MI
235 1/11/2024
OWNED BY: QUINN BREINER, PRATT, KS WILL BREINER, PRATT, KS
236 1/10/2024
OWNED BY: KENZIE HAWKINS, JANE LEW, WV
238
OWNED BY: LANDON HALL, BOLT, WV
239
BRYLIEE MILLER- GRANTSVILLE, MD
OWNED BY: BRYLIEE MILLER, GRANTSVILLE, MD
240
OWNED BY: BRAYLEN TAYLOR, ALEXANDRIA, KY
242 1/2/2024
OWNED BY: EVELYN JOHNSON, NAVARRE, OH JILLIAN JOHNSON, NAVARRE, OH
OWNED BY: JILLIAN JOHNSON, NAVARRE, OH EVELYN JOHNSON, NAVARRE, OH
OWNED BY: CAYDEN CRONQUIST, EMMETT, ID
BY: CADY W PIEPER, ZURICH, KS
Grand Champion Steer
Reserve Grand Champion Steer From classes: 003
Grand Champion Bred-and-Owned Steer
Reserve Grand Grand Champion Bred-and-Owned Steer
248
SERENA ANDERSON- DUNBAR, PA
OWNED BY: SERENA ANDERSON, DUNBAR, PA
AUE- AUBURNDALE, WI
OWNED BY: ELAYNA AUE, AUBURNDALE, WI
249
OWNED BY: TIMBER HULA, CRESTON,
OWNED BY: TENLEY STOLLARD, SULLIVAN, IL
OWNED BY: TAYLOR KENDALL BOATMAN, ROCKFORD, IL
BY: BREMLEY DOIG, ST PAUL, IN AVA DOIG, ST PAUL, IN
OWNED BY: TAVA GUSTAFSON, JUNCTION CITY, KS
258 2/20/2025 HRR FROZONE
OWNED BY: HOLDEN ROEDER, SEGUIN, TX
259 2/16/2025 MURPH C109 HENRY 2507 44667376
OWNED BY: WESTYN ZEB MURPHREE, HAMILTON, TX
260 2/15/2025 SKC NEVADA 18N
SARAH CHILDS- RIPLEY, MS
BY: SARAH CHILDS, RIPLEY, MS
OWNED BY: SOPHIA TAYLOR, PARKTON, MD
262
BY: GUNNER
OWNED BY: HADLEY EUBANK, OBLONG, IL
OWNED BY: MORGAN RICHARDSON, CAPRON, IL DANIEL RICHARDSON, CAPRON, IL
OWNED BY: OLIVIA WALSH, DEGRAFF, MN
269 1/15/2025 GRAND ECLIPSE
OWNED BY: FOX LONEY, ADA, MI
270 1/14/2025 DBLL 7437 CHICAGO 513 44660340
OWNED BY: BRAXTON LOCKHART, CALDWELL, TX
271
OWNED BY: MARY CARTER SHIRLEY, SPARTA, TN
OWNED BY: CRAYTON
OWNED BY: ALISHA KLEMME,
OWNED BY: SAWYER HAKE, EDGERTON, OH
275 1/6/2025
BRED BY:
KURTIS EVONIUVK- XENIA, OH
OWNED BY: KURTIS EVONIUVK, XENIA, OH
RILEY EVONIUK, XENIA, OH
278 12/28/2024 AFB BLINGED OUT BENTLEY 2402
ADDIE BOURGEOIS- OPELOUSAS, LA
OWNED BY: ADDIE BOURGEOIS, OPELOUSAS, LA
279
BY:
ALLIE ANDERSON- MORTON, IL
OWNED BY: ALLIE ANDERSON, MORTON, IL
280
OWNED BY: BRAXTON LOCKHART, CALDWELL, TX
OWNED BY: MORGAN RICHARDSON, CAPRON, IL
DANIEL RICHARDSON, CAPRON, IL
OWNED BY: FAITH BENEDICT, DEWEY, IL
OWNED BY: ADDISON N STOLLARD, SULLIVAN, IL
OWNED BY: JALYN DAVIS, MAPLE HILL, KS
285 11/25/2024 PCC 1107 153
287
OWNED BY: MARY GRACE WARDEN, HALFWAY, MO
288
OWNED BY: HANNAH PEMBROOK, BEGGS, OK
290
OWNED BY: THOMAS KADE BOATMAN, ROCKFORD, IL
291 11/9/2024 SCC 265 ICEMAN 101M 44620751
OWNED BY: SIMON SHEPARD, ALTAMONT, IL
292
OWNED BY: JACE STITHEM, FREDONIA, KS
OWNED BY: LOWDERMAN CATTLE COMPANY, MACOMB, IL
BY: TUCKER OSTGAARD, DAYTON, OH
BY: NORA LEIGH WERK, MANHATTAN, KS
OWNED BY: COLE DIEBALL, LITTLE RIVER, KS
298
OWNED BY: KYLIE HURD, RANGER, GA
OWNED BY: JORDAN MITCHEM, VALE, NC
300 10/26/2024 CHF BP
OWNED BY: BROOKLYN PRICE, OPELIKA, AL
301 10/23/2024 SCG DAY NEW SENSATION 120M ET 44649644
OWNED BY: RHETT DAY, TELFORD, TN
302 10/22/2024 2M SANCHO 2406 ET 44655453 ECR 628 IVYS ADVANCE
OWNED BY: MARLEE GRANNIS, FLEMINGSBURG, KY
303
CADY W PIEPER- ZURICH, KS
OWNED BY: CADY W PIEPER, ZURICH, KS
304
OWNED BY: ADALYNN GRACE BLANKENSHIP, WEST BURLINGTON, NY
305 10/19/2024 2M HIGH ROLLER 2405 ET 44655455
OWNED BY: MARLEE GRANNIS, FLEMINGSBURG, KY
306 10/16/2024
OWNED BY: AIDYN BARBER, CHANNING, TX
309
OWNED BY: GENTRY GUDEL, WILTON, CA
310
OWNED BY: NASH LOWDERMAN, MACOMB, IL TUCK LOWDERMAN, MACOMB, IL
311 10/7/2024
OWNED BY: RHETT LEHMAN, SULLIVAN, IL
312 10/5/2024 BR MALCOM 4297
OWNED BY: AIDYN BARBER, CHANNING, TX
313
OWNED BY: SHAWN
314
OWNED BY: LEVI WOMACK, PEMBROKE, KY
OWNED BY:
OWNED BY: HARRISON ROBERTS, WILLIAMSBURG, MA
318 9/25/2024
OWNED BY: LIBBY PEREZ, TEXLINE, TX
PEYTON PEREZ, TEXLINE, TX
319
OWNED BY: BIANCA BEVAN, PLATTEVILLE, WI
320
OWNED BY: SAGE E LAWRENCE, AVILLA, IN
321 9/22/2024
OWNED BY: JARRETT LANE DALIA, VANCOVER, WA
322
OWNED BY: EMMA HANCOCK, BOLIVAR, MO
OWNED BY: SAMANTHA LYNN CAMPBELL, EATON, CO
324
OWNED BY: SAMANTHA LYNN
EATON, CO
325
OWNED BY:
OWNED BY: EMMA HANCOCK, BOLIVAR, MO
328
BY: LOGAN MANSFIELD, LIBERTY, TN
329
OWNED BY: LOGAN MANSFIELD,
330
OWNED BY: KENNEDY JEAN HOFFMAN, THEDFORD, NE
331
OWNED BY: BO TODD, MOUNT VERNON, KY
332 9/10/2024
OWNED BY: BRAYSON MAYO, SCOTT CITY, KS
333 9/10/2024 NCC ALL IN 4092 ET 44654825
BY: MADILYN NORVELL, TUTTLE, OK
334 9/7/2024
OWNED BY:
OWNED BY: JAYNA BLUME, PIERRE, SD
337
338
BY: PEYTON PEREZ, TEXLINE, TX LIBBY PEREZ, TEXLINE, TX
341
OWNED BY: KINZLEY EVANS, FREDONIA, KS
342
OWNED BY: HAXTON HAROLD HOFFMAN, THEDFORD, NE
OWNED BY: RYLAN HINES, MAGNOLIA, KY
344
349
OWNED BY: MIRANDA HANSEN,
OWNED BY:
OWNED BY: DELANEY CHESTER, OREGONIA,
OWNED BY: MARY GRACE WARDEN, HALFWAY, MO
351
352
OWNED BY: MORGAN ROGERS, SOLON, IA
MCKENNA ROGERS, SOLON, IA
OWNED BY: BRAXTON LOCKHART, CALDWELL, TX
353
OWNED BY: KRAITON CARPENTER, LEEDEY, OK
354 5/20/2024 MPF SPECKLED ENDURANCE 124 44597526
BY:
ANTHONY JORDAN HALL- HUSTONVILLE, KY
BY: ANTHONY JORDAN HALL, HUSTONVILLE, KY
355 5/17/2024
OWNED BY: ADALYNN GRACE BLANKENSHIP, WEST BURLINGTON, NY
356 5/17/2024
OWNED BY: HADLEY HARRISON, MONTAGUE, CA
HANNAH HARRISON, MONTAGUE, CA
OWNED BY: TURKEY FEATHER RANCH, ADA, OK KYA RHODES, ADA, OK
OWNED BY: MORGAN RILEY, COLLEGE GROVE,
BY: COOPER MILLER, NEWCASTLE, WY JORIE MILLER, NEWCASTLE, WY
361
OWNED BY: TURKEY FEATHER RANCH, ADA, OK KYA RHODES, ADA, OK
362
OWNED BY: SAMANTHA LYNN CAMPBELL, EATON, CO
363 4/25/2024
OWNED BY: AMBERLYN CHRISTENBURY, STARR, SC
364 4/25/2024 KELT 561C
OWNED BY: BROGAN KELTNER, PEARL CITY, IL
365
OWNED BY: TEAGEN HAMES, TUTTLE, OK
366
OWNED BY: LAUREN JONES, DARLINGTON, WI
368
OWNED BY: COPELAND & SONS LLC, NARA VISA, NM
373
374
BY: AIDAN KNOBLOCH, BUCKINGHAM, IL
OWNED BY: WILLIAM MEINHARDT, ONAGA, KS
OWNED BY: HUDSON CARTER, STRATFORD, OK BUCK CATTLE COMPANY, MADILL, OK GRADY CARTER, STRATFORD, OK
OWNED
OWNED BY: HANNAH
OWNED BY: AIDAN KNOBLOCH, BUCKINGHAM, IL
OWNED BY: HADLEY HARRISON, MONTAGUE, CA HANNAH HARRISON, MONTAGUE, CA
OWNED BY: JORDAN MITCHEM, VALE, NC
384 3/11/2024
OWNED BY: ELLA WELDON, PIEDMONT, OK
OWNED BY: MADELYN GRACE THOMPSON, AMITY, MO
386 3/9/2024 HL STIMULUS
OWNED BY: HADLEY HARRISON, MONTAGUE, CA HANNAH HARRISON, MONTAGUE, CA
387 3/5/2024 LF PMH
OWNED BY: LOGAN BRYANT RHOADS, CHRISMAN, IL
388 3/4/2024
OWNED BY: TORY J MILLER, LEBANON, MO
389 3/3/2024 AH CONVOY 0624 44667464 BK BH FAST BALL F102 ET ALLIE ANDERSON- MORTON, IL BRED BY:
1115 EMMA 2202 OWNED BY: ALLIE ANDERSON, MORTON, IL
390
OWNED BY: TAYLOR COLE, ROBERTS, IL
391
392
393
OWNED BY: PEYTON PEREZ, TEXLINE, TX LIBBY PEREZ, TEXLINE, TX
BY:
OWNED BY: MADELINE BRAMAN, REFUGIO, TX
BY:
COLTON, SD
OWNED BY: MAKAYLA SIMMERMON, COLTON, SD
OWNED BY: ELLA WELDON, PIEDMONT, OK
OWNED BY: CACHE BILLMAN, BLACKFOOT, ID
397
OWNED BY: MARY CARTER SHIRLEY, SPARTA, TN
2/20/2024 KB
OWNED BY: KIERA BREMER, FULLERTON, NE KINSLEY BREMER, FULLERTON, NE
398 2/13/2024 CKW WAR ZONE
OWNED BY: CAROLINE JEAN WAGNER, HULL, IA
399 2/12/2024 HOFFMAN GERALD 4000 44543397
402
OWNED BY: SOPHIA TAYLOR, PARKTON, MD
403
OWNED BY: LAUREN JONES, DARLINGTON, WI
BRADY JONES, DARLINGTON, WI THE GUNSMOKE 222, LIBERTY, MO
NICHOLAS JONES, DARLINGTON, WI
OWNED BY: TORY J MILLER, LEBANON, MO
OWNED BY: ATLEY KLEINMAN,
OWNED BY: KENNEDY JEAN
OWNED BY: HUNTER BARNES, TAYLORSVILLE, KY
407 2/1/2024
OWNED BY: TINLEY HARVIE, OLDS, AB HARVIE RANCHING, MOUNTAIN VIEW COUNTY, AB LYLA HARVIE, OLDS, AB
409
411
412
OWNED BY: VANDERWORK HEREFORDS, TALOGA, OK
HAXTON HAROLD HOFFMAN, THEDFORD, NE
LILLY ANDERSON- MORTON, IL BRED BY:
OWNED BY: LILLY ANDERSON, MORTON, IL
413
OWNED BY: BLAIR BUEHLER, FAIRBURY, NE
OWNED BY: HARPER ROSE
OWNED BY: ELLA CRANE, LASALLE, IL
OWNED BY: GRANT HELSINGER, GERMANTOWN, OH
LINDIE HELSINGER, GERMANTOWN, OH
OWNED BY: KYNSLEIGH KREBS, GORDON, NE
OWNED BY: MUELLERS POLLED HEREFORDS, PERRYVILLE, MO
PHILLIP
OWNED BY: HAYES DEVINE, CHICKASHA, OK
OWNED BY: DAISY BROWN, SMITHFIELD, NC
423
BY: COLTON PETERSON, ROANOKE, IL
OWNED BY: CRUZ COLYER, BRUNEAU, ID
424
BY: MACY MACKE, LAKE CITY, IA
426
BY: RHETT LEHMAN, SULLIVAN, IL
OWNED BY: CRUZ COLYER, BRUNEAU, ID GKB CATTLE, DESDEMONA, TX
428
OWNED BY: SILAS GULLATT, SALEM, AL
OWNED BY: JORDAN MITCHEM, VALE, NC
OWNED BY: LAUREN JONES, DARLINGTON, WI
BRADY JONES, DARLINGTON, WI
NICHOLAS JONES, DARLINGTON, WI
431
OWNED BY: JOSEPH SCHOHR, OROVILLE, CA
OWNED BY: LANDRY ALLAN, NOCONA, TX
433 10/31/2023
OWNED BY: HAYES DEVINE, CHICKASHA, OK
434 10/30/2023 GB BP CB BOLD
OWNED BY: MADDOX GUNN, GREENFIELD, IN WYATT GUNN, GREENFIELD, IN
435 10/20/2023 CORKS CHIP
OWNED BY: ATLEY KLEINMAN, WENTWORTH, MO
436
OWNED BY: CADENCE HARRIS, SALADO, TX
437
OWNED BY: COLTON PETERSON, ROANOKE, IL
OWNED BY: AIDYN BARBER, CHANNING, TX
OWNED BY: EMMA LEWIS, LITCHFIELD, OH
Grand Champion Bred-and-Owned Bull
Reserve Grand Champion Bred-and-Owned Bull Class 005 — Bred-and-Owned Females
From Division Champions
OWNED BY: OWEN MCARTHUR, PITTSFORD, MI
OWNED BY: ELAYNA AUE, AUBURNDALE, WI
450 2/27/2025 SCC 32K LADY
OWNED BY: SIMON SHEPARD, ALTAMONT, IL
451 2/27/2025 CKW ELVIRA 227N 44659574 H EISENHOWER
OWNED BY: CAROLINE JEAN WAGNER, HULL, IA
452
OWNED BY: KIERA BREMER, FULLERTON, NE
OWNED BY: NICHOLAS JONES, DARLINGTON, WI
LAUREN JONES, DARLINGTON, WI
BRADY JONES, DARLINGTON, WI
OWNED BY: JAELYN KOONTZ, THOMAS, OK
ADDISON KOONTZ, THOMAS, OK
OWNED BY: SARAH BETH CALLICOTT, ONLY,
OWNED BY: MASON ROEDER, SEGUIN, TX
460
OWNED BY: KENNETH KYPKE, LOGANVILLE, WI
OWNED BY: JAYDEN SIMPSON, ROACHDALE, IN
462 2/5/2025 TVF THEA
OWNED BY: SOPHIA TAYLOR, PARKTON, MD
463 2/4/2025 EML HAPPY NORA N124
OWNED BY: EMMA LEWIS, LITCHFIELD, OH
464
OWNED BY: MAGGIE REED, GREEN RIDGE, MO
OWNED BY: CAROLINE JEAN WAGNER, HULL, IA
469
OWNED BY: SOPHIA TAYLOR, PARKTON, MD
471
OWNED BY: NASH LOWDERMAN, MACOMB, IL TUCK LOWDERMAN, MACOMB, IL
BIRDSELL- ENNICE, NC
OWNED BY: CHARLEIGH BIRDSELL, ENNICE, NC
472 1/22/2025
OWNED BY: HUCK GRAY, KNIGHTSTOWN, IN
473 1/20/2025 SB 12G RUBY
BY: ROSS SIEDLING, BROOKVILLE, IN
OWNED BY: LANDON L DEATSMAN, LEESBURG, IN COLLIN DEATSMAN, LEESBURG, IN
BY: JESSILYN MILLER, LAKEVILLE, OH
476 1/14/2025
OWNED BY: CORBIN PERRY, TOWER HILL, IL
CADEN PERRY, TOWER HILL, IL
479
OWNED BY: REBECCA VANCAMP, MARION, NY
480
OWNED BY: MARY CARTER SHIRLEY, SPARTA, TN
481 1/8/2025 OCC PRINCESS PEACH 44652722 OCC SENSATION A757 ET
KURTIS EVONIUVK- XENIA, OH BRED BY:
OWNED BY: KURTIS EVONIUVK, XENIA, OH
OWNED BY: NICHOLAS JONES, DARLINGTON, WI
LAUREN JONES, DARLINGTON, WI
BRADY JONES, DARLINGTON, WI
483 1/3/2025
OWNED BY: DELANEY CHESTER, OREGONIA, OH
484 1/3/2025
OWNED BY: JARRETT SHANE WORRELL, MASON, TX
485 12/26/2024
OWNED BY: OLIVIA EUBANK, OBLONG, IL HADLEY EUBANK, OBLONG, IL
486 12/26/2024 CEP 113 LIL' B
OWNED BY: CORBIN PERRY, TOWER HILL, IL CADEN PERRY, TOWER HILL, IL
487 12/26/2024
489
OWNED BY: HANNAH PEMBROOK, BEGGS, OK
491
492
BY: MORGYN PERKINS, NORTH STONINGTON, CT
493 12/17/2024 CREEK STEADFST 246 OLIVIA 453M 44654480 NJW
OWNED BY: JILLIAN JOHNSON, NAVARRE, OH EVELYN JOHNSON, NAVARRE, OH
494 12/16/2024 MCS RITA
OWNED BY: MARY CARTER SHIRLEY, SPARTA, TN
495 12/15/2024 RCF 8135 018G MEADOW M215
OWNED BY: SALEM EMALINE SIFFORD, GOLDVEIN, VA
496 12/10/2024
OWNED BY: NICHOLAS JONES, DARLINGTON, WI
OWNED BY: ADALYNN GRACE BLANKENSHIP, WEST BURLINGTON, NY
OWNED BY: NICHOLAS JONES, DARLINGTON, WI
LAUREN JONES, DARLINGTON, WI
BRADY JONES, DARLINGTON, WI
OWNED BY: JACE MURPHREE, HAMILTON, TX
OWNED BY: ELLA CALLICOTT, ONLY, TN
501 12/3/2024 DCC MG 927K MISS TINA 95M 44619112 DCC MG 1221
OWNED BY: MCKENNA GATZ, FAIRVIEW, KS LAUREN GATZ, FAIRVIEW, KS
SWIGART CARAMEL 412 ET
502 12/3/2024
OWNED BY: KADE SWIGART, FARMER CITY, IL
KORBIN SWIGART, FARMER CITY, IL
503 12/2/2024 BEACON HILL MISS LIBERTY
OWNED BY: MCKENZIE SLOAN BOYER, VINITA, OK
504 12/1/2024 BH FANCY
OWNED BY: JALEN NICHOLE HOLT, MANTACHIE, MS
505 11/23/2024 MG 510G MARLIE 453M
OWNED BY: CALLY MILLER, EL DORADO, KS CAMI MILLER, EL DORADO, KS
506 11/22/2024 BR GKB SALEM
BY: BECKETT BARBER, AMARILLO, TX HENLEY BARBER, AMARILLO, TX
507 11/19/2024
512
OWNED BY: ELLA BANE, TOWANDA, IL
513
OWNED BY: HUNTER BARNES, TAYLORSVILLE, KY
56
OWNED BY: PAIGE LEMENAGER, HUDSON, IL
CADY W PIEPER- ZURICH, KS
BY: CADY W PIEPER, ZURICH, KS
514 11/12/2024
OWNED BY: OLIVIA JONES, BLUE MOUNDS, WI
515 11/12/2024 WORR 40K1 GIGGLE SNAPS 50M
OWNED BY: JARRETT SHANE WORRELL, MASON, TX
516 11/11/2024 RCF 7 J218 MADISON M111 44647324
520
521
OWNED BY: DANIEL RICHARDSON, CAPRON, IL
MORGAN RICHARDSON, CAPRON, IL
OWNED BY: RHETT DAY, TELFORD, TN
522 11/4/2024
OWNED BY: TENLEY STOLLARD, SULLIVAN, IL
523 11/2/2024 RL
OWNED BY: RHETT LEHMAN, SULLIVAN, IL
524 11/2/2024 PCC NEW MEXICO LADY 4431
OWNED BY: PEYTON PEREZ, TEXLINE, TX LIBBY PEREZ, TEXLINE, TX
525 11/2/2024
OWNED BY: MARY GRACE WARDEN, HALFWAY, MO
526
OWNED BY: BIANCA BEVAN, PLATTEVILLE, WI
OWNED BY: SARAH BETH CALLICOTT, ONLY, TN
OWNED BY: BEAU PHILLIP KNIGHT, COMER, GA
530
531
OWNED BY: ADALYNN GRACE BLANKENSHIP, WEST BURLINGTON, NY
532
OWNED BY: JOSIE BELLE HARVILLE, LEBANON, TN
533 10/25/2024
OWNED BY: BEAU PHILLIP KNIGHT, COMER, GA
534 10/24/2024 RB ABC
OWNED BY: AVA DOIG, ST PAUL, IN BREMLEY DOIG, ST PAUL, IN
535 10/23/2024
OWNED BY: HANNAH PEMBROOK, BEGGS, OK
536
OWNED BY: LEVI WOMACK, PEMBROKE, KY
BY: SARAH BETH CALLICOTT, ONLY, TN
541
542
OWNED BY: HARPER RAY, BROOKSVILLE, KY
543 10/17/2024 YCC MS HOT SAUCE 2413 ET 44659967 KLD
OWNED BY: OLIVIA YOUNG, LEXINGTON, IL
ADDISON ROSE YOUNG, LEXINGTON, IL
HATTIE YOUNG, LEXINGTON, IL
544 10/16/2024
OWNED BY: WILL BECKLEY, IRVINE, KY
545
OWNED BY: COOPER HATTAN, VARNA, IL
OWNED
BY: ATLEY KLEINMAN, WENTWORTH, MO
OWNED BY: CORBIN PERRY, TOWER HILL, IL
CADEN PERRY, TOWER HILL, IL
551
OWNED BY: GRANT WATERS, NORBORNE, MO
552
OWNED BY: GRADY CARTER, STRATFORD, OK HUDSON CARTER, STRATFORD, OK
553
OWNED BY: EMMA HANCOCK, BOLIVAR, MO
554 10/8/2024 SHADI OAK 8923 COLETTE 108M 44646778 ECR 628 IVYS ADVANCE 8923
ASHLEE DEMOLLES- WEST BRIDGEWATER, MA BRED BY:
OWNED BY: ASHLEE DEMOLLES, WEST BRIDGEWATER, MA
OWNED BY: DAGAN MURRAY, AUBURN, KS
OWNED BY: KYLAN HELMS, HOLBROOK, NE
557
OWNED BY: MILA PEREZ, CANYON, TX
558
BY: CORA EVERHART, MORRISTOWN, IN
561
OWNED BY: GABE CRUTCHER, MONTROSE, IL
TREVOR CRUTCHER, MONTROSE, IL
SHAWN CRUTCHER, MONTROSE, IL
OWEN CRUTCHER, MONTROSE, IL
562
OWNED BY: LAYTON REAMES, CULPEPER, VA
563
OWNED BY: PEYTON PEREZ, TEXLINE, TX LIBBY PEREZ, TEXLINE, TX
564 9/28/2024 PCC NEW MEXICO LADY 4405 ET 44660255
OWNED BY: PEYTON PEREZ, TEXLINE, TX LIBBY PEREZ, TEXLINE, TX
565 9/27/2024 BH 01F TAMMIE
OWNED BY: FAITH BENEDICT, DEWEY, IL
566 9/27/2024 LPF PDF CLASSY MOLLY 31M
OWNED BY: CHARLEIGH BIRDSELL, ENNICE, NC
567 9/27/2024 SLEW 213 MERLE 415M ET 44617532 KJ TWJ
OWNED BY: MARY HANNAH GULLATT, SALEM, AL SILAS GULLATT, SALEM, AL
568 9/25/2024 BOFAT HILL SWEET CAROLINE 92M
OWNED BY: EMMA DAVISSON, CALAMUS, IA COLTON DAVISSON, CALAMUS, IA
570
OWNED BY: NORA LEIGH WERK, MANHATTAN, KS
571
572
573
OWNED BY: SAYLOR NORVELL, TUTTLE, OK
MADILYN NORVELL, TUTTLE, OK
9/19/2024
OWNED BY: NATALIE PITSTICK, SOUTH SOLON, OH
9/18/2024
OWNED BY: JARRETT LANE DALIA, VANCOVER, WA
OWNED BY: TORY J MILLER, LEBANON, MO
575
OWNED BY: LEVI WOMACK, PEMBROKE, KY
576
OWNED BY: CLAYTON HAYES, ADA, OK
BY: LIBBY PEREZ, TEXLINE, TX
PEREZ, TEXLINE, TX
578
BY: JARRETT LANE DALIA, VANCOVER, WA 579
BRED BY:
BELLA E5 ET OWNED BY: CLAY LAWRENCE, KITE, GA
CLAY LAWRENCE- KITE, GA
581
OWNED BY: NASH LOWDERMAN, MACOMB, IL TUCK LOWDERMAN, MACOMB, IL
582
OWNED BY: WILLIAM WEBERT, WARRENTON, VA
BENJAMIN WEBERT, WARRENTON, VA
OWNED BY: LOGAN MANSFIELD, LIBERTY, TN
583
OWNED BY: NATALIE LISTON, SEVILLE,
OWNED BY: LOGAN MANSFIELD, LIBERTY, TN LANDON
OWNED BY: TORY J MILLER, LEBANON, MO
OWNED BY: WILLIAM WEBERT, WARRENTON,
OWNED BY: DAGAN
590
OWNED BY: WILL BECKLEY, IRVINE, KY
591
OWNED BY: SARAH GRACE BIRDSALL, TORRINGTON, WY
SAMUEL C BIRDSALL, TORRINGTON, WY
EMMA LAWRENCE- KITE, GA BRED BY:
OWNED BY: EMMA LAWRENCE, KITE, GA
593
594
OWNED BY: ELIZABETH WRIGHT, CLINTON, ME
LAYNA OTTMERS- FREDERICKSBURG, TX BRED BY:
OWNED BY: LAYNA OTTMERS, FREDERICKSBURG, TX
OWNED BY: MARLYN PECHA, MENO, OK
600
601
OWNED BY: ALEXANDER HUISHEERE, JANESVILLE, WI
602 9/2/2024
OWNED BY: NICHOLAS JONES, DARLINGTON, WI
603 8/31/2024 EHF 308 573
OWNED BY: KALLEN EVANS, FREDONIA, KS
604 8/30/2024 EHF 8130 1909 RAEGAN
OWNED BY: KALLEN EVANS, FREDONIA, KS
605 8/21/2024 NCC QUEEN 4081 ET 44654824 CH
OWNED BY: SAYLOR NORVELL, TUTTLE, OK
MADILYN NORVELL, TUTTLE, OK
606 8/17/2024 C 2157K BAILEE 4361
BY: CRUZ COLYER, BRUNEAU, ID
OWNED BY: MADELYNN WRIGHT, CLINTON, ME
OWNED BY: JILLIAN JOHNSON, NAVARRE, OH EVELYN JOHNSON, NAVARRE, OH
611
OWNED BY: HAXTON HAROLD HOFFMAN, THEDFORD, NE
612 8/6/2024 OTTM
LAYNA OTTMERS- FREDERICKSBURG, TX
OWNED BY: LAYNA OTTMERS, FREDERICKSBURG, TX
OWNED BY: RYLIE
HANNAH OLESON- ARKDALE, WI BRED BY:
OWNED BY: HANNAH OLESON, ARKDALE, WI
RYAN OLESON, ARKDALE, WI 615
HANNAH OLESON- ARKDALE, WI
HANNAH OLESON, ARKDALE, WI
RYAN OLESON, ARKDALE, WI
HANNAH OLESON- ARKDALE, WI BRED BY:
OWNED BY: HANNAH OLESON, ARKDALE, WI RYAN
HANNAH OLESON- ARKDALE, WI BRED BY:
BY: NANCY GAIL BING, SAVOY, TX
BY: VIVIAN LOU THOMPSON, TROY, AL
2066
620
621
OWNED BY: AVA DOIG, ST PAUL, IN
622 7/18/2024 7H SENSATIONS
OWNED BY: RYLI HOLLIS, CLYDE, TX
623 7/15/2024 LBK GSK 3F VIVIAN 32M 44580644 LBK
OWNED BY: GABRIELLE KEETS, BERLIN HEIGHTS, OH
624 7/14/2024 STOL 7029 J47 POBLANO 0224 44585087
BY: TENLEY STOLLARD, SULLIVAN, IL
BY: GRACE SMITH, STROUDSBURG, PA
OWNED BY: ANNA
OWNED BY: JOSEPH
OWNED BY: PAIGE LEMENAGER,
BY: MARY GRACE WARDEN, HALFWAY, MO
631
OWNED BY: BELLA SMITH, BONHAM, TX
632
BY: BRODY SMITH, BONHAM, TX
BY: SUTER CLARK, GRETNA, VA
OWNED BY: AIDYN BARBER, CHANNING,
OWNED BY: KOVIN LEWIS, RYAN, OK KOBLE LEWIS, RYAN, OK
CADY W PIEPER- ZURICH, KS BRED BY:
OWNED BY: CADY W PIEPER, ZURICH, KS
BY: NANCY GAIL BING, SAVOY, TX
BY: AIDYN BARBER, CHANNING, TX
641
642
OWNED BY: LANDON L DEATSMAN, LEESBURG, IN COLLIN DEATSMAN, LEESBURG, IN
MACOMB, IL BRED BY:
OWNED BY: TUCK LOWDERMAN, MACOMB, IL NASH LOWDERMAN, MACOMB, IL
643
OWNED BY: COLTON PETERSON, ROANOKE, IL
644
OWNED BY:
645
OWNED BY: DAGAN MURRAY, AUBURN,
OWNED BY: SOPHIA TAYLOR, PARKTON, MD
647 6/16/2024
BY: REID TUTWILER, MT SIDNEY, VA
648 6/16/2024 ELLA JUNGLE CAT'S
OWNED BY: ELLA WELDON, PIEDMONT, OK
649 6/15/2024 RPH MAZZY 6M
OWNED BY: NICHOLAS JONES, DARLINGTON, WI
LAUREN JONES, DARLINGTON, WI
BRADY JONES, DARLINGTON, WI
BRED BY:
HANNAH OLESON- ARKDALE, WI
OWNED BY: HANNAH OLESON, ARKDALE, WI
RYAN OLESON, ARKDALE, WI
652 6/11/2024
OWNED BY: EMMALEE MUELLER, PERRYVILLE, MO
PHILLIP MUELLER, PERRYVILLE, MO
653
OWNED BY: BRODY SMITH, BONHAM, TX
654 6/9/2024
OWNED BY: CLAYTON MUSSER, OTTERBEIN, IN CARLEE A MUSSER, OTTERBEIN, IN CATIE MUSSER, OTTERBEIN, IN
BY:
OWNED BY: DANIEL RICHARDSON, CAPRON, IL MORGAN RICHARDSON, CAPRON, IL
IL
OWNED BY: PAIGE LEMENAGER, HUDSON, IL
OWNED BY: TYLER COLE, ROBERTS, IL
TAYLOR COLE, ROBERTS, IL
660
OWNED BY: AVERY WAGNER, HULL, IA
CAROLINE JEAN WAGNER, HULL, IA
ANNA WAGNER, HULL, IA
661
BY:
662
663
SCOTT CITY, KS
OWNED BY: BRAYSON MAYO, SCOTT CITY, KS
MUSSER- OTTERBEIN, IN BRED BY:
OWNED BY: CLAYTON MUSSER, OTTERBEIN, IN
CARLEE A MUSSER, OTTERBEIN, IN CATIE MUSSER, OTTERBEIN, IN
OWNED BY: ADDISON WARD, OAK GROVE, MO
OWNED BY: BRAXTON CARPER, VEVAY, IN BARRETT CARPER, VEVAY, IN
665
OWNED BY: CACHE BILLMAN, BLACKFOOT, ID
OWNED BY: JD SEWARD, ROCKVILLE, IN
667 5/20/2024 DNTN CLASSIC MARGO 409M
BY: DUSTIN D DENTON, BLUE RAPIDS, KS
BECKETT BARBER, AMARILLO, TX
672
OWNED BY: CLAYTON MUSSER, OTTERBEIN, IN
CARLEE A MUSSER, OTTERBEIN, IN
CATIE MUSSER, OTTERBEIN, IN
BY:
673
KY
OWNED BY: BRENNA PERKINS, SULPHUR, KY
OWNED BY: EMMA HACKBART, MILFORD, NE
674
OWNED BY: PEYTON GARNHART, GERMAN VALLEY, IL
675 5/11/2024 ELLA
OWNED BY: ELLA WELDON, PIEDMONT, OK
676
677
OWNED BY: CLAYTON HEINS, NEW SALEM, ND
SP EF REESE 22M ET
5/10/2024
PURPLE SLEEPY JOE 80H ET 3.9
OWNED BY: BAILEY PEARL, DUQUOIN, IL SHELBY PEARL, DUQUOIN, IL
OWNED BY: KYA RHODES, ADA, OK
SAMUEL
OWNED BY: SAMUEL C BIRDSALL, TORRINGTON, WY
SARAH GRACE BIRDSALL, TORRINGTON, WY
OWNED BY: KRAITON CARPENTER, LEEDEY, OK
682 5/8/2024 RS KYLO 222 REY 401
44562055
OWNED BY: SHERIDAN ELIZABETH CHANEY, KEYMAR, MD
RIANNA KATHRYN CHANEY, KEYMAR, MD
683
684
GOHR
685
MURPH 651
686
5/8/2024
OWNED BY: EMMA DAVISSON, CALAMUS, IA
COLTON DAVISSON, CALAMUS, IA
5/8/2024
OWNED BY: FALLON GOHR, MADRAS, OR GUNNAR GOHR, MADRAS, OR
5/8/2024
OWNED BY: WESTYN ZEB MURPHREE, HAMILTON, TX
VALLEY OAKS RUTHIE 4040
5/8/2024
OWNED BY: DAVIS WARD, OAK GROVE, MO
CONNELLY WARD, OAK GROVE, MO
ADDISON WARD, OAK GROVE, MO
687
OWNED BY: LUKE HAMLIN, WEATHERFORD, TX
688 5/6/2024
OWNED BY: DREW MELENDREZ, DIXON, IL
OWNED BY: KYA RHODES,
690
OWNED BY: SAMANTHA LYNN CAMPBELL, EATON, CO
691
692
OWNED BY: BECKETT BARBER, AMARILLO, TX
HENLEY BARBER, AMARILLO, TX
LASALLE,
OWNED BY: ELLA CRANE, LASALLE, IL
JOHN WILFRED CRANE, LA SALLE, IL
693
OWNED BY: ATLEY KLEINMAN, WENTWORTH, MO
694
OWNED BY: COOPER MILLER, NEWCASTLE, WY
695 5/3/2024
OWNED BY: DANIEL RICHARDSON, CAPRON, IL
MORGAN RICHARDSON, CAPRON, IL
696 5/3/2024
OWNED BY: PAISLEE VAN HORN, MORGANTOWN, IN
OWNED BY: KERRIGAN BAUSERMAN, STRASBURG, VA
698 5/2/2024 CLNS BARB 2431M
CRICKET A COLLINS, CHATTANOOGA, OK
CIERRA V COLLINS, CHATTANOOGA, OK
CLAIRE M COLLINS, CHATTANOOGA, OK
OWNED BY: ATLEY KLEINMAN, WENTWORTH, MO
OWNED BY: ELLA WELDON, PIEDMONT, OK
OWNED BY: AIDAN KNOBLOCH, BUCKINGHAM, IL
703 5/1/2024 4LEAF FIONA 24E 44584917 PURPLE TOBY 109F
OWNED BY: MAKENNA SMITH, HUBERTUS, WI
704 5/1/2024 WF 2150 POLLY 16G 86M
61 29 96 MIA WALSH- MURDOCK,
OWNED BY: MIA WALSH, MURDOCK, MN
OWNED BY: JASE BELTZ, CANTON, KS JOSIE BELTZ, CANTON, KS
OWNED BY: COOPER MILLER, NEWCASTLE, WY JORIE MILLER, NEWCASTLE, WY
OWNED BY:
OWNED BY: KENNEDY JEAN HOFFMAN, THEDFORD, NE
OWNED BY: ALISHA KLEMME, PLYMOUTH, WI
710
OWNED BY: KRAITON CARPENTER, LEEDEY, OK
711
OWNED BY: DELANEY FIGGE, ONAGA, KS TYREE E FIGGE, ONAGA, KS
712 4/24/2024 TFRKR
OWNED BY: KYA RHODES, ADA, OK
713 4/23/2024 JAF ACA FAITH 2441 44621324 MH PHILOSOPHER
C ALEXANDER- KOKOMO, IN
OWNED BY: ASHLEY C ALEXANDER, KOKOMO, IN
OWNED BY: EMMA LYNN, PURCELL, OK
OWNED BY: HARPER ROSE STARNES, FORT PAYNE, AL
717
OWNED BY: FALLON GOHR, MADRAS, OR GUNNAR GOHR, MADRAS, OR
4/21/2024
BY: CLAYTON MUSSER, OTTERBEIN, IN
CARLEE A MUSSER, OTTERBEIN, IN CATIE MUSSER, OTTERBEIN, IN
722
OWNED BY: HADLEY HARRISON, MONTAGUE, CA
HANNAH HARRISON, MONTAGUE, CA
OWNED BY: MORGAN RICHARDSON, CAPRON, IL
DANIEL RICHARDSON, CAPRON, IL
OWNED BY: BREMLEY DOIG, ST PAUL, IN
723 4/17/2024
OWNED BY: AIDAN KNOBLOCH, BUCKINGHAM, IL
724
4/16/2024 BR GKB
OWNED BY: BECKETT BARBER, AMARILLO, TX
HENLEY BARBER, AMARILLO, TX
725 4/16/2024
OWNED BY: MYA C BEVAN, PLATTEVILLE, WI
4/15/2024 CC RRG MS 2389 MARY ROSE 4415M 44577084
OWNED BY: RIGGIN ROSE GOINGS, ROYAL CENTER, IN
4/14/2024 2TK 208K MIS RIDGE 411M 44581116
BY: THOMAS KADE BOATMAN, ROCKFORD, IL TAYLOR KENDALL BOATMAN, ROCKFORD,
OWNED BY: AIDYN BARBER, CHANNING, TX
OWNED BY: JORJA EBERT, POLO, MO
OWNED BY: GUNNAR GOHR, MADRAS, OR
BY: ADDISON N STOLLARD, SULLIVAN, IL
OWNED BY: ELLA WELDON, PIEDMONT, OK
OWNED BY: COLTON DAVISSON, CALAMUS, IA EMMA DAVISSON, CALAMUS, IA
OWNED BY: MARLEE GRANNIS, FLEMINGSBURG, KY MADELYN GRANNIS, FLEMINGSBURG, KY
CANDY'S MONTGOMERY
TR PUTZ- OTLEY, IA BRED BY:
OWNED BY: TR PUTZ, OTLEY, IA
COLBY PUTZ, OTLEY, IA
DAX W PUTZ, OTLEY, IA
740
OWNED BY: ADALYNN GRACE BLANKENSHIP, WEST BURLINGTON, NY
742
OWNED BY: ELLA CRANE, LASALLE, IL
743 4/9/2024 PCC BRP
OWNED BY: BRENNA PERKINS, SULPHUR, KY
744 4/9/2024 SS JS 0109 MAGPIE
OWNED BY: JOSEPH SCHOHR, OROVILLE, CA
745 4/8/2024 2TK 005H DELIVERY LADY 409M
OWNED BY: THOMAS KADE BOATMAN, ROCKFORD, IL
TAYLOR KENDALL BOATMAN, ROCKFORD, IL
OWNED BY: CLAYTON MUSSER, OTTERBEIN, IN
CARLEE A MUSSER, OTTERBEIN, IN CATIE MUSSER, OTTERBEIN, IN
OWNED BY: LEVI WOMACK, PEMBROKE,
OWNED BY: THOMAS KADE BOATMAN, ROCKFORD, IL
TAYLOR KENDALL BOATMAN, ROCKFORD, IL
OWNED BY: AVA DOIG, ST PAUL, IN
OWNED BY: ADALYNN GRACE BLANKENSHIP, WEST BURLINGTON, NY
752 4/5/2024 NR SCF MISS T 331M
DEATH- INDIANOLA, IL
BY: LILY DEATH, INDIANOLA, IL
OWNED BY: HADLEY HARRISON, MONTAGUE, CA
HANNAH HARRISON, MONTAGUE, CA
754
OWNED BY: REAGAN KASPER, POPLAR GROVE, IL
755
756
757
OWNED BY: PAISLEE LORENZEN, CHRISMAN, IL
RWCC DIANA 4049M
4/4/2024
OWNED BY: WILLIAM MEINHARDT, ONAGA, KS
RYLIE MEINHARDT, ONAGA, KS
4/4/2024
OWNED BY: DAGAN MURRAY, AUBURN, KS
FBF HR SHANIA 4065
758 4/3/2024
44570246
OWNED BY: DELANEY FIGGE, ONAGA, KS
TYREE E FIGGE, ONAGA, KS
OWNED BY: COLTON PETERSON, ROANOKE, IL
762
OWNED BY: TORY J MILLER, LEBANON, MO TAYLOR MILLER, LEBANON, MO
763
OWNED BY: RYLEE STOCKDALE, DAYTON, PA
4/2/2024 YCC
OWNED BY: ADDISON ROSE YOUNG, LEXINGTON, IL
OWNED BY: AIDYN BARBER, CHANNING, TX
OWNED
OWNED BY: WYATT
MORTON, IL
OWNED BY: CRAIG STAHOSKI, NEWTON, NJ
771
OWNED BY: SAGE E LAWRENCE, AVILLA, IN
772 3/30/2024 L2 LCC 0183 MISS KIWI 50M 44595350 PCC
OWNED BY: NASH LOWDERMAN, MACOMB, IL
773 3/29/2024 DBLL 8923 SKITTLES 436 ET 44562048 ECR
OWNED BY: BRAXTON LOCKHART, CALDWELL, TX
774 3/28/2024 BR GKB MARIE M104 ET 44561975 T/R
BY: AIDYN BARBER, CHANNING, TX
OWNED BY: LAUREN JONES, DARLINGTON, WI
OWNED BY: CARLISLE BRAMAN, REFUGIO, TX
OWNED BY: CARLEE A MUSSER, OTTERBEIN, IN CATIE MUSSER, OTTERBEIN, IN
CLAYTON MUSSER, OTTERBEIN, IN
779 3/25/2024
OWNED BY: ADDISON DUIS, PETERSBURG, IL
OWNED BY: HANNAH KEITH, CAMPBELLSVILLE, KY
OWNED BY: ADDISON ROSE YOUNG, LEXINGTON, IL
782 3/24/2024
OWNED BY: BRAXTON CARPER, VEVAY, IN BARRETT CARPER, VEVAY, IN
783 3/24/2024
OWNED BY: SUTER CLARK, GRETNA, VA
784 3/24/2024 LAM RAMSEY RUBYS DOOBY
OWNED BY: LENA ANN MAY, GREENFIELD, IN 785 3/23/2024
QUEEN PADME 51H
BY:
LAYNA OTTMERS- FREDERICKSBURG, TX
OWNED BY: LAYNA OTTMERS, FREDERICKSBURG, TX
OWNED BY: ELAINA WALSH, GODFREY, IL
787 3/22/2024 ELLA
OWNED BY: ELLA WELDON, PIEDMONT, OK
788 3/21/2024 MURPH
OWNED BY: CAMI MILLER, EL DORADO, KS CALLY MILLER, EL DORADO, KS
790
OWNED BY: HUDSON CARTER, STRATFORD, OK
792 3/17/2024 CJB
OWNED BY: CHYLOH BILLMAN, BLACKFOOT, ID
793 3/17/2024 HL SKYFALL 2412 ET 44601964
OWNED BY: HADLEY HARRISON, MONTAGUE, CA
HANNAH HARRISON, MONTAGUE, CA
794 3/17/2024 HOFFMAN DEBBIE 4370 ET
OWNED BY: HAXTON HAROLD HOFFMAN, THEDFORD, NE
795 3/17/2024 PCC NEW MEXICO LADY4030 44584839
OWNED BY: PEYTON PEREZ, TEXLINE, TX LIBBY PEREZ, TEXLINE, TX
796 3/17/2024 WOMACK CLASSIC
BY: LEVI WOMACK, PEMBROKE, KY
BY: HALLIE HUGHES, KNOB LICK, KY
801
OWNED BY: BRENNA PERKINS, SULPHUR, KY
802 3/14/2024
OWNED BY: LANDON L DEATSMAN, LEESBURG, IN COLLIN DEATSMAN, LEESBURG, IN
803
OWNED BY: DUSTIN D DENTON, BLUE RAPIDS, KS
OWNED BY: NICHOLAS JONES, DARLINGTON, WI
BRADY JONES, DARLINGTON, WI
LAUREN JONES, DARLINGTON, WI
OWNED BY: CHESNEY PRINZ, WEST POINT, NE
WI
OWNED BY: BLAKE BRANCEL, ENDEAVOR, WI
KALEIGH MCNAUGHTON- GRAVENHURST, ON BRED BY:
OWNED BY: KALEIGH MCNAUGHTON, GRAVENHURST, ON COOPER MCNAUGHTON, GRAVENHURST, ON
OWNED BY: GUNNAR GOHR, MADRAS, OR FALLON GOHR, MADRAS, OR
OWNED BY: WILLIAM MEINHARDT, ONAGA, KS
RYLIE MEINHARDT, ONAGA, KS
810
811
OWNED BY: JD SEWARD, ROCKVILLE, IN
812 3/11/2024 NCC SAYLOR 4031 ET
OWNED BY: SAYLOR NORVELL, TUTTLE, OK
OWNED BY: JASE BELTZ, CANTON, KS JOSIE BELTZ, CANTON, KS
814
815
OWNED BY: CRICKET A COLLINS, CHATTANOOGA, OK
CIERRA V COLLINS, CHATTANOOGA, OK
CLAIRE M COLLINS, CHATTANOOGA, OK
OWNED BY: NASH LOWDERMAN, MACOMB, IL TUCK LOWDERMAN, MACOMB, IL
817
OWNED BY: BRONSON MARSTON, AGENDA, KS
TRIGG MARSTON, AGENDA, KS
BY:
OWNED BY: SAVANNAH RITENOUR, FORT VALLEY, VA
820
OWNED BY: BLAKE BRANCEL, ENDEAVOR, WI BRYCE BRANCEL, ENDEAVOR, WI
821
OWNED BY: MAX MCGUNEGILL, JASPER, MN
822
823
OWNED BY: LOGAN CADY, NEW WINDSOR, MD
3/6/2024 2TK
OWNED BY: TAYLOR KENDALL BOATMAN, ROCKFORD, IL THOMAS KADE BOATMAN, ROCKFORD, IL
OWNED BY: ELLA WELDON, PIEDMONT, OK
OWNED BY: WILL BECKLEY, IRVINE, KY
828
830
831
OWNED BY: KAYLEE REVIS, LEICESTER, NC
ADDISON REVIS, LEICESTER, NC
OWNED BY: RYAN GARNHART, GERMAN VALLEY, IL
832 3/4/2024
OWNED BY: ADDISON KOONTZ, THOMAS, OK JAELYN KOONTZ, THOMAS, OK
833
BY: RILEY GREGORY RHODES, CARLINVILLE, IL
BY: AIDYN BARBER, CHANNING, TX
OWNED BY: KASHLYN KREBS, GORDON, NE
KYNSLEIGH KREBS, GORDON, NE
3/3/2024 NELLA -26
ROLAND SANDBERG- AGENDA, KS BRED BY:
OWNED BY: RYNE SANDBERG, AGENDA, KS
ROLAND SANDBERG, AGENDA, KS
REESE SANDBERG, AGENDA, KS
OWNED BY: RYLEE STOCKDALE, DAYTON, PA
OWNED BY: TYLER COLE, ROBERTS, IL
TAYLOR COLE, ROBERTS, IL
840
CRUTCHER- MONTROSE, IL
OWNED BY: GABE CRUTCHER, MONTROSE, IL
TREVOR CRUTCHER, MONTROSE, IL
SHAWN CRUTCHER, MONTROSE, IL
OWEN CRUTCHER, MONTROSE, IL
OWNED BY: ASHLEE DEMOLLES, WEST BRIDGEWATER, MA
OWNED BY: MORGAN FIRLUS, WONEWOC, WI
OWNED BY: OLIVIA YOUNG, LEXINGTON, IL
ADDISON ROSE YOUNG, LEXINGTON, IL HATTIE YOUNG, LEXINGTON, IL
OWNED BY: HADLEY HARRISON, MONTAGUE, CA
HANNAH HARRISON, MONTAGUE, CA
845 3/1/2024
OWNED BY: ALEXANDER HUISHEERE, JANESVILLE, WI
846 3/1/2024 RPC 6123 8123 FIREWORK
OWNED BY: MILA PEREZ, CANYON, TX
847 2/28/2024 FCCH GENTRY PENNY 0228M 44620865
OWNED BY: ELYSE GARNHART, GERMAN VALLEY, IL
OWNED BY: KIAN MORRIS, WILBER, NE
OWNED BY: AVERY WAGNER, HULL, IA
ANNA WAGNER, HULL, IA
CAROLINE JEAN WAGNER, HULL, IA
OWNED BY: KIERA BREMER, FULLERTON, NE
KINSLEY BREMER, FULLERTON, NE
OWNED BY: COLE DIEBALL, LITTLE RIVER, KS
OWNED BY: JASE KLINK, GARDEN, MI
OWNED BY: CONNOR RHOADS, CHRISMAN, IL
855 2/25/2024 ACC CA 1443 HAILEY 408 44567028 H
OWNED BY: COOPER GENE ACHESON, WICHITA, KS EMMETT ACHESON, WICHITA, KS
856
OWNED BY: FOX LONEY, ADA, MI
857 2/24/2024 GOSS 0011 220K PETUNIA
OWNED BY: KAYSTON GOSS, VINTON, CA
858 2/24/2024 TMG SHADY LADY 4009 44591832 ECR 628 IVYS ADVANCE 8923 ET 5.5 64 31 113 BRONSON MARSTON- AGENDA, KS BRED BY:
OWNED BY: BRONSON MARSTON, AGENDA, KS TRIGG MARSTON, AGENDA, KS
859 2/24/2024 OTTM FRESHWATER PEARL 220K 44551941 WORR SKYWALKER 79B2 ET
LAYNA OTTMERS- FREDERICKSBURG, TX BRED BY:
PEARL 20F BELLE6026 ET OWNED BY: LAYNA OTTMERS, FREDERICKSBURG, TX
860
861
OWNED BY: LANEY STEPHENS, WEST SALEM, IL
862 2/23/2024 HOFFMAN DEBBIE
OWNED BY: HAXTON HAROLD HOFFMAN, THEDFORD, NE
863 2/23/2024 MF3C DAKOTA
OWNED BY: JORDAN MITCHEM, VALE, NC
864 2/23/2024 SWIGART 66H ANNABELLE 4330
OWNED BY: KADE SWIGART, FARMER CITY, IL
KORBIN SWIGART, FARMER CITY, IL
865
OWNED BY: KIERA BREMER, FULLERTON, NE
KINSLEY BREMER, FULLERTON, NE
CARSYN 4166 ET
866 2/21/2024
OWNED BY: LAUREN JONES, DARLINGTON, WI
OWNED BY: KASHLYN KREBS, GORDON, NE
OWNED BY: LANEY STEPHENS, WEST SALEM, IL
OWNED BY: SHAWN CRUTCHER, MONTROSE, IL
870
OWNED BY: SAGE E LAWRENCE, AVILLA, IN
872
OWNED BY: SARAH GRACE BIRDSALL, TORRINGTON, WY SAMUEL C BIRDSALL, TORRINGTON, WY
873
OWNED BY: ELLA ELIZABETH DEFORD, JARRETTSVILLE, MD
IN
OWNED BY: LANDON L DEATSMAN, LEESBURG, IN COLLIN DEATSMAN, LEESBURG, IN
OWNED BY: JAYDEN SIMPSON, ROACHDALE, IN
OWNED BY: BRAXTON CARPER, VEVAY, IN BARRETT CARPER, VEVAY, IN
OWNED BY: AARON SHRIVER, GRAFTON, WV
877
OWNED BY: COLTON PETERSON, ROANOKE, IL
BY: GUNNER WHITEHEAD, TOWNSEND, DE 879
2/9/2024 KK NORMA JEAN 209M
KARSYN KLEEMAN- BRAYMER, MO BRED BY:
CHURCHILL MAJESTIC 903G ET
WILDCAT PROPEL 2305 ET OWNED BY: KARSYN KLEEMAN, BRAYMER, MO KADE KLEEMAN, BRAYMER, MO
880
OWNED BY: BLAKE BRANCEL, ENDEAVOR, WI
OWNED BY: MADDIE JENKINS, ATHENS, TX
882
OWNED BY: AVERY WAGNER, HULL, IA
ANNA WAGNER, HULL, IA
CAROLINE JEAN WAGNER, HULL, IA
OWNED BY: JAYNA BLUME, PIERRE, SD RETT BLUME, PIERRE, SD
OWNED BY: MADDOX GUNN, GREENFIELD, IN
886
OWNED BY: ATLEY KLEINMAN, WENTWORTH, MO
2/5/2024
OWNED BY: ADALYNN GRACE BLANKENSHIP, WEST BURLINGTON, NY
888
OWNED BY: MAZIE BUNN, ZEBULON, NC MACK BUNN, ZEBULON, NC
2/5/2024
890
891
OWNED BY: ELLA WELDON, PIEDMONT, OK
892 2/1/2024
OWNED BY: WILL BECKLEY, IRVINE, KY
893 2/1/2024 CCF PROMINENCE 21G
OWNED BY: TAYLOR COLE, ROBERTS, IL
894 2/1/2024 MH 743 MISS PROPHET 4372
OWNED BY: TORY J MILLER, LEBANON, MO
895 1/31/2024
OWNED BY: LANDON L DEATSMAN, LEESBURG, IN COLLIN DEATSMAN, LEESBURG, IN
896 1/31/2024
OWNED BY: MADDOX GUNN, GREENFIELD, IN WYATT GUNN, GREENFIELD, IN
897 1/31/2024
OWNED BY: CALLIE F SCHMIDT, BLUE RAPIDS, KS
OWNED BY: KASHLYN KREBS, GORDON, NE KYNSLEIGH KREBS, GORDON, NE
902
OWNED BY: WILLIAM TACKETT, IOLA, TX
OWNED BY: KINSLEY JEAN GILLIG, BLUE RAPIDS, KS
BY:
OWNED BY: HARLEE WREN WATSON, FLEMINGSBURG, KY WYATT WATSON, FLEMINGSBURG, KY
903
OWNED BY: JACE MURPHREE, HAMILTON, TX
OWNED BY: AVA DOIG, ST PAUL, IN BREMLEY
OWNED BY: SAWYER HAKE, EDGERTON,
OWNED BY: TINLEY HARVIE,
OWNED
910
912
OWNED BY: JACK BEGOON, GROTTOES, VA
BY: GENTRY GUDEL, WILTON, CA
OWNED BY: JAELYN KOONTZ, THOMAS, OK
OWNED BY: CARLY WHEELER, TEMPLETON, CA
917 1/13/2024
OWNED BY: JAYNA BLUME, PIERRE, SD RETT BLUME, PIERRE, SD
918
BY: ELLA CRANE, LASALLE, IL
BY: RAY S DUNCAN, WINGATE, IN
OWNED BY: COLTON PETERSON, ROANOKE, IL
921
OWNED BY: SARAH BETH CALLICOTT, ONLY, TN
922
OWNED BY: SARAH BETH CALLICOTT, ONLY, TN
923 1/10/2024 BW
OWNED BY: GARRETT HICKEY, STAUNTON, VA SCOTT HICKEY, STAUNTON, VA
924
OWNED BY: SPENCER SCHMIDT, BLUE RADIDS, KS
925
OWNED BY: LEVI WOMACK, PEMBROKE, KY
926
OWNED BY: KINSLEY JEAN GILLIG, BLUE RAPIDS, KS
OWNED BY: PAIGE LEMENAGER, HUDSON, IL
928
OWNED BY: MADELYN BEAVER, GRANDVIEW, TX
929 1/4/2024
OWNED BY: HARRISON ROBERTS, WILLIAMSBURG, MA
930
932
933
934
935
OWNED BY: BAILEY PEARL, DUQUOIN, IL
SHELBY PEARL, DUQUOIN, IL
1/3/2024
OWNED BY: GABRIEL SWALLOW, GARLAND, TX
1/3/2024 BT
OWNED BY: BRAYLEN TAYLOR, ALEXANDRIA, KY
936 1/1/2024
OWNED BY: LAYTON REAMES, CULPEPER, VA
937
OWNED BY: JORDAN MITCHEM, VALE, NC
OWNED BY: FOSTER WINGLER, CHRISTIANA, TN
939 12/28/2023 SLEW 2F LORNA 312L
OWNED BY: MARY HANNAH GULLATT, SALEM, AL
940 12/20/2023 JB LAINEY 65L ET
OWNED BY: JASE BELTZ, CANTON, KS JOSIE BELTZ, CANTON, KS
OWNED BY: JACE MURPHREE, HAMILTON, TX
942
943
944
OWNED BY: HANNAH PEMBROOK, BEGGS, OK
LAUREN WINGLER- CHRISTIANA, TN
OWNED BY: LAUREN WINGLER, CHRISTIANA, TN
SCHOHR- OROVILLE, CA
OWNED BY: JOSEPH SCHOHR, OROVILLE, CA
945
OWNED BY: TENLEY STOLLARD, SULLIVAN, IL
946
OWNED BY: PAISLEE JANE YOUNG, SPRINGVILLE, TN
947 12/5/2023
OWNED BY: RHETT DAY, TELFORD, TN
BY: HARRISON ROBERTS, WILLIAMSBURG, MA
OWNED BY: AVA DOIG, ST PAUL, IN BREMLEY DOIG, ST PAUL, IN
953
OWNED BY: WESTYN ZEB MURPHREE, HAMILTON, TX
954
OWNED BY: NICHOLAS JONES, DARLINGTON, WI
LAUREN JONES, DARLINGTON, WI
BRADY JONES, DARLINGTON, WI
MORRILTON, AR BRED BY:
OWNED BY: LUKE DESALVO, MORRILTON, AR
956 11/15/2023
NAOMI SINNAMON- KOKOMO, IN BRED BY:
OWNED BY: NAOMI SINNAMON, KOKOMO, IN ELI SINNAMON, PERU, IN
BY:
OWNED BY: BAILEY PEARL, DUQUOIN, IL
OWNED
963
964
965
OWNED BY: OLIVIA JONES, BLUE MOUNDS, WI
BY:
966
TX
OWNED BY: JARRETT SHANE WORRELL, MASON, TX
OWNED BY: WILLIAM WEBERT, WARRENTON, VA BENJAMIN WEBERT, WARRENTON, VA
OWNED BY: LANDRY ALLAN, NOCONA, TX
OWNED BY: MARY GRACE WARDEN, HALFWAY, MO
OWNED BY: KYA RHODES, ADA,
OWNED BY: LANDRY ALLAN, NOCONA, TX
973
LUCY FLYNN- TANEYTOWN, MD BRED BY:
OWNED BY: LUCY FLYNN, TANEYTOWN, MD
974
OWNED BY: KYA RHODES, ADA, OK
976
OWNED BY: THOMAS KADE BOATMAN, ROCKFORD, IL
TAYLOR KENDALL BOATMAN, ROCKFORD, IL
OWNED BY: PEYTON PEREZ, TEXLINE, TX LIBBY PEREZ, TEXLINE, TX
OWNED BY: WILLIAM WEBERT, WARRENTON, VA
OWNED BY: COOPER HATTAN, VARNA, IL
OWNED BY: BRINLEY DAVIS, MAPLE HILL, KS
DANICA DAVIS, MAPLE HILL, KS
JALYN DAVIS, MAPLE HILL, KS
OWNED BY: WILLIAM SEXTEN, NICHOLASVILLE, KY LUCY KATE SEXTEN, NICHOLASVILLE, KY
OWNED BY: LUKE FISHER, BON AQUA, TN
983
OWNED BY: CLAIBORNE PERRY, MADISON, MS
984
985
986
OWNED BY: NICHOLAS JONES, DARLINGTON, WI
LAUREN JONES, DARLINGTON, WI
BRADY JONES, DARLINGTON, WI
9/4/2023
SAMANTHA LYNN CAMPBELL- EATON, CO BRED BY:
OWNED BY: SAMANTHA LYNN CAMPBELL, EATON, CO
9/4/2023
OWNED BY: EMMA HANCOCK, BOLIVAR, MO
987 9/3/2023 BANE FLORENCE 235 ET 44552405 ECR
OWNED BY: ELLA BANE, TOWANDA, IL
BY: LIBBY PEREZ, TEXLINE, TX PEYTON PEREZ, TEXLINE, TX
989
BY: TESSA EVERHART, MORRISTOWN, IN
Grand Champion Bred-and-Owned Female
Reserve Grand Champion Bred-and-Owned Female
Third Overall Bred-and-Owned Female
Fourth Overall Bred-and-Owned Female
Fifth Overall Bred-and-Owned Female
From classes: 005
BY: SEDONA SIFFORD, GOLDVEIN, VA
BY: KAYLEE KNAUS, ACME, WA
OWNED BY: PAISLEY MILLER, BELLVILLE, TX 993
TUCKER OSTGAARD, DAYTON, OH
OWNED BY: BRODY GREENWOOD, HAMILTON, KS
LAYNEE GREENWOOD, HAMILTON, KS
BRADYN GREENWOOD, HAMILTON, KS
OWNED BY: ADDISON KOONTZ, THOMAS, OK
JAELYN KOONTZ, THOMAS, OK
OWNED BY: KADE SWIGART, FARMER CITY, IL
KORBIN SWIGART, FARMER CITY, IL
OWNED BY: PAIGE DENNISTON, WEST, TX
BY: EVAN JACKSON, HOLLADAY, TN
OWNED BY: ADELYNN KUYKENDALL, GRAHAM, TX
1002
OWNED BY: CALLY MILLER, EL DORADO, KS CAMI MILLER, EL DORADO, KS
OWNED BY: SUTTON JOSEPH STELZER, OOLOGAH, OK
1003
OWNED BY: SAMUEL GOLDIZEN, PETERSBURG, WV
HOGUELAND WADE GOLDIZEN, PETERSBURG, WV
BY:
OWNED BY: KARLEIGH ALLISON, HORTON, AL
OWNED BY: KENNEDY JEAN HOFFMAN, THEDFORD, NE
OWNED BY: OLIVIA JONES,
OWNED BY: GRAHAM CAIN CREAMER, WAXAHACHIE, TX
OWNED BY: COLE DIEBALL,
OWNED BY: MICHAEL MEZRANO, COLUMBIANA, AL
ANTHONY MEZRANO, COLUMBIANA, AL
OWNED BY: TANNER MANTOOTH, DANIELSVILLE, GA
1013
OWNED BY: CLARK SMITH, GEORGETOWN, KY
SOPHIA SMITH, GEORGETOWN, KY
WARREN SMITH, GEORGETOWN, KY
BY:
OWNED BY: HANNAH PEMBROOK, BEGGS, OK
OWNED BY: COLE DIEBALL, LITTLE RIVER, KS
OWNED BY: AUBREY LOCKHART, SOMERVILLE, TX
1014
OWNED BY: OLIVIA YOUNG, LEXINGTON, IL
ADDISON ROSE YOUNG, LEXINGTON, IL
HATTIE YOUNG, LEXINGTON, IL
OWNED BY: HAILEY CORNETT, HILLSBORO, OH
OWNED BY: WILL FREKING, ALPHA, MN
OWNED BY: ELLA KNIGHT, NEWTON GROVE, NC
OWNED BY: LAUREN CRABTREE, LIBERAL, MO
OWNED BY: ATLEY KLEINMAN, WENTWORTH, MO
1020
OWNED BY: DAVIS WARD, OAK GROVE, MO
GANNON WARD, OAK GROVE, MO
CONNELLY WARD, OAK GROVE, MO
CANYON, TX
OWNED BY: MILA PEREZ, CANYON, TX
1022
OWNED BY: MILA PEREZ, CANYON, TX
OWNED BY: WYATT WEABER, WAMEGO, KS
MADELYN WEABER, WAMEGO, KS
COOPER BISHOP WEABER, WAMEGO, KS
OWNED BY: MILA PEREZ, CANYON, TX
OWNED BY: ELLA BROOKS, PROPHETSTOWN, IL
OWNED BY: AUBREY LANDRUM, HUNTINGTON, IN BAILEY LANDRUM, HUNTINGTON, IN
NOCONA,
OWNED BY: LANDRY ALLAN, NOCONA, TX
GABE CRUTCHER- MONTROSE,
OWNED BY: GABE CRUTCHER, MONTROSE, IL
TREVOR CRUTCHER, MONTROSE, IL
SHAWN CRUTCHER, MONTROSE, IL
OWEN CRUTCHER, MONTROSE, IL
OWNED BY: SCARLETT WARD, CORYDON, IN
OWNED BY: JOHN OWEN STARNES, FORT PAYNE, AL
1031
OWNED BY: SILAS GULLATT, SALEM, AL
1032 9/28/2024 HPH 2064 1006
OWNED BY: HAYDEN HELMS, HOLBROOK, NE
KYLAN HELMS, HOLBROOK, NE
OWNED BY: EMMA DAVISSON, CALAMUS, IA
COLTON DAVISSON, CALAMUS, IA
OWNED BY: EMMA LAWRENCE, KITE, GA
9/20/2024 DKE QUEEN CHANDLER 628 44642918 H
COMFREY, MN
BY: ANNA GORDON, WORTHINGTON, MN
OWNED BY: CARA CUMMINS, HOLLIS, OK CREW CUMMINS, HOLLIS, OK
9/18/2024
1039
OWNED BY: PIPER SEISS, THURMONT, MD 1040
CLAY LAWRENCE- KITE, GA BRED BY:
OWNED BY: CLAY LAWRENCE, KITE, GA
OWNED BY: NASH LOWDERMAN, MACOMB, IL TUCK LOWDERMAN, MACOMB, IL
OWNED BY: LANDON MANSFIELD, LIBERTY, TN
OWNED BY: LOGAN MANSFIELD, LIBERTY,
OWNED BY: TORY J
OWNED BY: ELIZABETH WRIGHT, CLINTON, ME
OWNED BY: MARLYN PECHA, MENO, OK
1047 9/2/2024
KINZLEY EVANS, FREDONIA, KS
OWNED BY: NICHOLAS JONES, DARLINGTON, WI
BRADY JONES, DARLINGTON, WI
LAUREN JONES, DARLINGTON, WI
OWNED BY: SAYLOR NORVELL, TUTTLE, OK MADILYN NORVELL, TUTTLE, OK
OWNED BY: KALLEN EVANS, FREDONIA, KS
OWNED BY: MCKENNA GATZ, FAIRVIEW, KS
LAUREN GATZ, FAIRVIEW, KS
OWNED BY: NANCY GAIL BING, SAVOY, TX
OWNED BY: SPENCER WRIGHT, LEBANON, TN REAGAN WRIGHT, LEBANON, TN
OWNED BY: KRAITON CARPENTER, LEEDEY, OK 1055
OTTM
8/6/2024
BY: LAYNA OTTMERS, FREDERICKSBURG, TX
BY: MADAILEIN BEARD, ALBANY, TX
OWNED BY: ANSLEY GEE, VALE, NC
OWNED BY: SAVANAH GRIMES, MURCHISON, TX
OWNED BY: NATALIE BROWN, GROVEPORT, OH
OWNED BY: AIDYN BARBER, CHANNING, TX
OWNED BY: LUKE BERGERON, BELCHERTOWN, MA
1062 6/28/2024 RCF 7 H921 MAKE ME HUSH M628 44622884 RAMSEY
OWNED BY: SALEM EMALINE SIFFORD, GOLDVEIN, VA SEDONA SIFFORD, GOLDVEIN, VA
OWNED BY: NANCY GAIL BING, SAVOY, TX
OWNED BY: AIDYN BARBER, CHANNING, TX
BY: LANDON L DEATSMAN, LEESBURG, IN COLLIN DEATSMAN, LEESBURG, IN
BY: LENA ANN MAY, GREENFIELD, IN
BY: SOPHIA TAYLOR, PARKTON, MD
1069
1070
OWNED BY: NICHOLAS JONES, DARLINGTON, WI
LAUREN JONES, DARLINGTON, WI
BRADY JONES, DARLINGTON, WI
BY:
1071
WV
OWNED BY: JEB PAINTER, GANDEEVILLE, WV
1072
OWNED BY: MADISON BAUER, BONFIELD, IL
6/11/2024
OWNED BY: EMMALEE MUELLER, PERRYVILLE, MO
PHILLIP MUELLER, PERRYVILLE, MO
OWNED BY: ALEXANDER HUISHEERE, JANESVILLE, WI
OWNED BY: BRODY SMITH, BONHAM, TX
OWNED BY: ELAINA WALSH, GODFREY, IL
OWNED BY: CORBIE GREEN, ELSIE, MI
OWNED BY: HAYDEN MARIE HOFFMAN, THEDFORD, NE
KENNEDY JEAN HOFFMAN, THEDFORD, NE
HAXTON HAROLD HOFFMAN, THEDFORD, NE
OWNED BY: KYNDAL SADLER, TRYON, OK
KYLEE SADLER, TRYON, OK
OWNED BY: AVERY WAGNER, HULL, IA
CAROLINE JEAN WAGNER, HULL, IA
ANNA WAGNER, HULL, IA
BY:
VEVAY,
OWNED BY: BRAXTON CARPER, VEVAY, IN
BARRETT CARPER, VEVAY, IN
OWNED BY: ASHLEY C ALEXANDER, KOKOMO, IN
OWNED BY: LILLY ANDERSON, MORTON, IL
ALLIE ANDERSON, MORTON, IL TY ANDERSON, MORTON, IL GRIFFIN ANDERSON, MORTON, IL
OWNED
OWNED BY: JD SEWARD, ROCKVILLE, IN
OWNED BY: LUKE KEITH, CAMPBELLSVILLE, KY
OWNED BY: HENLEY BARBER, AMARILLO, TX BECKETT BARBER, AMARILLO, TX
PEARL
OWNED BY: BROGAN KELTNER, PEARL CITY, IL
OWNED BY: BRENNA PERKINS, SULPHUR, KY
OWNED BY: BLAKE DAY, LOUP CITY, NE BROOKE DAY, LOUP CITY, NE
OWNED BY: MATTIE FLOHR, DANVILLE, IN
OWNED BY: BO TODD, MOUNT VERNON, KY
ELLEN TODD, MOUNT VERNON, KY
OWNED BY: JOHANNA STUDER, FRANKFORT, KS
JULIA STUDER, FRANKFORT, KS
JACQUELINE STUDER, FRANKFORT, KS
CAROLINE STUDER, FRANKFORT, KS
OWNED BY: DAVIS WARD, OAK GROVE, MO
CONNELLY WARD, OAK GROVE, MO
ADDISON WARD, OAK GROVE, MO
OWNED BY: NOLAN ORWIG, TOULON, IL
OWNED BY: CRICKET A COLLINS, CHATTANOOGA, OK
CIERRA V COLLINS, CHATTANOOGA, OK
CLAIRE M COLLINS, CHATTANOOGA, OK
OWNED BY: HUDSON NITSCHE, HOLT, MO GRIFFIN NITSCHE, HOLT, MO
OWNED BY: AVERY ROWLETT, WAVERLY, TN
OWNED BY: ELLA WELDON, PIEDMONT, OK
OWNED BY: CREW CUMMINS, HOLLIS, OK CARA CUMMINS, HOLLIS, OK
1103
OWNED BY: ANSLEY GEE, VALE, NC
OWNED BY: CRICKET A COLLINS, CHATTANOOGA, OK
OWNED BY: BENTON MCCLANAHAN, WAVERLY, TN BRADEN MCCLANAHAN, WAVERLY, TN
OWNED BY: PAYTON ZEPP, WEST MINSTER, MD
OWNED BY: SAMANTHA LYNN CAMPBELL, EATON, CO
OWNED BY: BLAKE DAY, LOUP CITY, NE BROOKE DAY, LOUP CITY, NE
OWNED BY: KYA RHODES, ADA, OK
OWNED BY: EMMIE WHITE, SPRINGFIELD, TN
OWNED BY: LUKE HAMLIN, WEATHERFORD, TX
OWNED BY: FALLON GOHR, MADRAS, OR GUNNAR GOHR, MADRAS, OR
OWNED BY: MORGAN RICHARDSON, CAPRON, IL
DANIEL RICHARDSON, CAPRON, IL
OWNED BY: MCKENNA ROGERS, SOLON, IA
MORGAN ROGERS, SOLON, IA
OWNED BY: MAKENNA SMITH, HUBERTUS, WI
OWNED BY: MAGGIE SHEPARD, ALTAMONT, IL
1120
OWNED BY: TRIPP EARLS, HOLLIS, OK
OWNED BY: KOBLE LEWIS, RYAN, OK KOVIN LEWIS, RYAN, OK
OWNED BY: LANDRY ALLAN, NOCONA, TX
OWNED BY: JAYNA BLUME, PIERRE, SD RETT BLUME, PIERRE, SD 1121
JORDAN JOHNSON- FORT DODGE, IA
BY: REEVE WAGNER, HAMPTON, IA
RAYNE WAGNER, HAMPTON, IA
OWNED BY: CORA BELLE CHAPMAN, SENECA, IL
OWNED BY: MADDIE JENKINS, ATHENS, TX
OWNED BY: NOLAN F LEE, WELLINGTON, IL
OWNED BY: MARY GRACE WARDEN, HALFWAY, MO
OWNED BY: TESSA BOOCO, HAYDEN, CO
OWNED BY: JACKSON MASSEY, PIKEVILLE, TN
1128
OWNED BY: REAGAN KASPER, POPLAR GROVE, IL
1129 4/4/2024 RWCC DIANA 4049M ET
OWNED BY: WILLIAM MEINHARDT, ONAGA, KS RYLIE MEINHARDT, ONAGA, KS
1130 4/3/2024 BK
OWNED BY: BLAIR HEATH, COOKSVILLE, MD
1131 4/3/2024 CH MS WILLOW 410 ET 44584060 BR GKB
OWNED BY: WYATT MCINTYRE, LEEDEY, OK
QUAID MCINTYRE, LEEDEY, OK
1132 4/2/2024 WF ROSE 4126
OWNED BY: MAREN KOLTERMAN, GARLAND, NE
CARLY KOLTERMAN, GARLAND, NE
MICHAEL KOLTERMAN, GARLAND, NE
OWNED BY: TORY J MILLER, LEBANON, MO
TAYLOR MILLER, LEBANON, MO
OWNED BY: JAELYN KOONTZ, THOMAS, OK
OWNED BY: LOGAN BRYANT RHOADS, CHRISMAN, IL
CONNOR RHOADS, CHRISMAN, IL
OWNED BY: ELLA CALLICOTT, ONLY, TN
1137
OWNED BY: AIDYN BARBER, CHANNING, TX
1138
OWNED BY: MADDIE JENKINS, ATHENS, TX
1139 3/28/2024 BR BROOKE M110
OWNED BY: MARY GRACE WARDEN, HALFWAY, MO
1140 3/26/2024 MC MISS MALLORY'S 2406
OWNED BY: CARLISLE BRAMAN, REFUGIO, TX
OWNED BY: JARRETT LANE DALIA, VANCOVER, WA
OWNED BY: HANNAH
OWNED BY: KYLEE
BY: SUTER CLARK, GRETNA, VA
OWNED BY: MARY CARTER SHIRLEY, SPARTA, TN
OWNED BY: MADELYN GRACE THOMPSON, AMITY, MO BRYNLEE ANN THOMPSON, AMITY, MO 1149
BRED BY:
LAYNA OTTMERS- FREDERICKSBURG, TX
OWNED BY: LAYNA OTTMERS, FREDERICKSBURG, TX
1150 3/23/2024 EW LIGHTNING JEWEL 04M 44612922 LCC
OWNED BY: ELAINA WALSH, GODFREY, IL
OWNED BY: DREW BALLARD, INMAN, KS
BALLARD, INMAN, KS
OWNED BY: MADDIE JENKINS, ATHENS, TX
OWNED BY: WESTYN ZEB MURPHREE, HAMILTON, TX
OWNED BY: JACQUELINE STUDER, FRANKFORT, KS
JOHANNA STUDER, FRANKFORT, KS
JULIA STUDER, FRANKFORT, KS
CAROLINE STUDER, FRANKFORT, KS
OWNED BY: GAGE CREAMER, WAXAHACHIE, TX
OWNED BY: JACKSON WRIGHT, EWING, NE
OWNED BY: HADLEY HARRISON, MONTAGUE, CA
HANNAH HARRISON, MONTAGUE, CA
1158
OWNED BY: IAN GARRETT FORBES, CHURCHVILLE, MD
1159
1160
OWNED BY: KENNEDY JEAN HOFFMAN, THEDFORD, NE
3/15/2024
OWNED BY: NICHOLAS BERNATOWICZ, TUNNELTON, WV NATHAN BERNATOWICZ, TUNNELTON, WV
1162
OWNED BY: TY PEZANOSKI, PERU, IL
3/15/2024
OWNED BY: NORA LEIGH WERK, MANHATTAN, KS
OWNED BY: GUNNAR GOHR, MADRAS, OR FALLON GOHR, MADRAS, OR
OWNED BY: WILLIAM MEINHARDT, ONAGA, KS
RYLIE MEINHARDT, ONAGA, KS
GRADY CARTER- STRATFORD, OK BRED BY:
OWNED BY: BLAYKLEE STELZER, OOLOGAH, OK
3/11/2024 H BL CARMEL M450 ET 44587232 H FRONT RUNNER 1495 ET 4.3 60 32 95
OWNED BY: BO TODD, MOUNT VERNON, KY
ELLEN TODD, MOUNT VERNON, KY
OWNED BY: RYLEE HARRIS, CANTON, TX
ET
1170
OWNED BY: CRUZ COLYER, BRUNEAU, ID
OLIVIA NEAL- OSGOOD, IN
BY: CAITLYN EDWARDS, SANTA FE, TX
OWNED BY: BROOKLYN PRICE, OPELIKA, AL
OWNED BY: ADDISON N STOLLARD, SULLIVAN, IL
OWNED BY: WILL BECKLEY, IRVINE, KY
OWNED BY: CARLISLE BRAMAN, REFUGIO, TX MADELINE BRAMAN, REFUGIO, TX
OWNED BY: TORY J
OWNED BY: ADDISON KOONTZ, THOMAS, OK JAELYN KOONTZ, THOMAS, OK
OWNED BY: CHESNEY PRINZ, WEST POINT, NE
1179
OWNED BY: KASHLYN KREBS, GORDON, NE
KYNSLEIGH KREBS, GORDON, NE
1180
OWNED BY: RYLEE STOCKDALE, DAYTON, PA
1181
OWNED BY: ELAINA WALSH, GODFREY, IL
3/2/2024
OWNED BY: BRANT ALTMAN, WORTHINGTON, MN
1182
3/2/2024 SIS GUAVA
OWNED BY: NATALIE PITSTICK, SOUTH SOLON, OH
OWNED BY: ELLA WELDON, PIEDMONT, OK
OWNED BY: OLIVIA YOUNG, LEXINGTON, IL
ADDISON ROSE YOUNG, LEXINGTON, IL
HATTIE YOUNG, LEXINGTON, IL
OWNED BY: ALEXANDER HUISHEERE, JANESVILLE, WI
3/1/2024
BRED BY:
TYLER KREBS- LAKE PARK, IA
OWNED BY: TOMMI RABEL, LAKE PARK, IA
1189 2/28/2024 NELLA -26 037H BELLA 527M
BRED BY:
NELLA RANCH- AGENDA, KS
OWNED BY: RYNE SANDBERG, AGENDA, KS
ROLAND SANDBERG, AGENDA, KS
REESE SANDBERG, AGENDA, KS
1190
2/27/2024
OWNED BY: MACY MACKE, LAKE CITY, IA
1191 2/26/2024 CHEZ MS MAYBELLINE
OWNED BY: KADEN CAMERLINCK, LEONARDVILLE, KS
1192 2/24/2024 GOSS 0011 220K PETUNIA 2403M
OWNED BY: KAYSTON GOSS, VINTON, CA
BY: LANEY STEPHENS, WEST SALEM, IL
OWNED BY: LUCY KATE SEXTEN, NICHOLASVILLE, KY
WILLIAM SEXTEN, NICHOLASVILLE, KY
OWNED BY: KIERA BREMER, FULLERTON, NE
KINSLEY BREMER, FULLERTON, NE
OWNED BY: MADILYN NORVELL, TUTTLE, OK
SAYLOR NORVELL, TUTTLE, OK
OWNED BY: ROSS SIEDLING, BROOKVILLE, IN
GARRISON SIEDLING, BROOKVILLE, IN ISAAC SIEDLING, BROOKVILLE, IN
OWNED BY: JACE STITHEM, FREDONIA, KS KOLTER STITHEM, FREDONIA, KS
OWNED BY: GRADY COLE CREAMER, WAXAHACHIE, TX
OWNED BY: ELLA ELIZABETH DEFORD, JARRETTSVILLE, MD
1204 2/17/2024 DEATSMAN MOLLY 6M ET 44564833
OWNED BY: LANDON L DEATSMAN, LEESBURG, IN COLLIN DEATSMAN, LEESBURG, IN
JESSILYN MILLER, LAKEVILLE, OH
BY: KENNEDY RIFE, COLUMBUS JUNCTION, IA
OWNED BY: MORGAN ROGERS, SOLON, IA
MCKENNA ROGERS, SOLON, IA
OWNED BY: ELLIE POARCH, LEWISBURG, TN
MAELEE POARCH, LEWISBURG, TN
OWNED BY: MAKENNA SMITH, HUBERTUS, WI TESSA SMITH, HUBERTUS, WI
OWNED BY: LANE CADY, NEW WINDSOR, MD LOGAN CADY, NEW WINDSOR, MD
OWNED BY: CREW CUMMINS, HOLLIS, OK CARA CUMMINS, HOLLIS, OK
OWNED BY: ALEXIS KOELLING, BOWLING GREEN, MO
COLTON
OWNED BY: THOMAS KADE BOATMAN, ROCKFORD, IL
TAYLOR KENDALL BOATMAN, ROCKFORD, IL
OWNED BY: MADDIE JENKINS, ATHENS, TX
1223
OWNED BY: AVERY WAGNER, HULL, IA
ANNA WAGNER, HULL, IA
CAROLINE JEAN WAGNER, HULL, IA
OWNED BY: MARLEE GRANNIS, FLEMINGSBURG, KY
MADELYN GRANNIS, FLEMINGSBURG, KY
OWNED BY: LUKE HAMLIN, WEATHERFORD, TX
OWNED BY: PARKER IRWIN, HARTSHORNE, OK
OWNED BY: MADDOX GUNN, GREENFIELD, IN WYATT GUNN, GREENFIELD, IN
OWNED BY: KASHLYN KREBS, GORDON, NE
KYNSLEIGH KREBS, GORDON, NE
OWNED BY: LAYTON HOPKINS, TRIBUNE, KS
OWNED BY: MADDIE JENKINS, ATHENS, TX
OWNED BY: JACE MURPHREE, HAMILTON, TX
1226
OWNED BY: ALEXSYS HAMMOND, KINMUNDY, IL
1227
OWNED BY: TIMBER HULA, CRESTON, NE
1228 1/16/2024
OWNED BY: HAYES DEVINE, CHICKASHA, OK
1229 1/16/2024
OWNED BY: BEAU ANN GRAVES, CHILLICOTHE, MO
1230 1/15/2024 BF DESPERATE 2M
OWNED BY: JACKSON MASSEY, PIKEVILLE, TN
OWNED BY: TAYLOR COLE, ROBERTS, IL TYLER COLE, ROBERTS, IL
OWNED BY: MIRANDA HANSEN, CHECOTAH, OK KRISTIN HANSEN, CHECOTAH, OK
1234
OWNED BY: CARLY WHEELER, TEMPLETON, CA
1/12/2024 WILDCAT
1236
OWNED BY: NATALIE PITSTICK, SOUTH SOLON, OH
1237
OWNED BY: LUKE BERGERON, BELCHERTOWN, MA
1238 1/8/2024
OWNED BY: LEVI WOMACK, PEMBROKE, KY
1239 1/4/2024 ATLAS 1K MS MAGIC
OWNED BY: MADELYN BEAVER, GRANDVIEW, TX
1240 1/3/2024 C PRH JOLENE 4231 ET 44559443 C CUDA BELLE
OWNED BY: CRUZ COLYER, BRUNEAU, ID
OWNED BY: BAILEY PEARL, DUQUOIN, IL SHELBY PEARL, DUQUOIN, IL
OWNED BY: KILEE GRACE LOVIN, LEXINGTON, GA
OWNED BY: MAGGIE SHEPARD, ALTAMONT, IL
BY: KARLEIGH ALLISON, HORTON, AL
1247
OWNED BY: MCKENZIE SLOAN BOYER, VINITA, OK
1248
OWNED BY: BAYLEE D SMITH, CHECOTAH, OK
1249
OWNED BY: HAYES DEVINE, CHICKASHA, OK
OWNED BY: AVA DOIG, ST PAUL, IN BREMLEY DOIG, ST PAUL, IN
OWNED BY: HAYDEN HELMS, HOLBROOK, NE KYLAN HELMS, HOLBROOK, NE
BY: COLTON DAVISSON, CALAMUS, IA EMMA DAVISSON, CALAMUS, IA
OWNED BY: BLAKELY STOREY, STOCKTON, IL STETSON STOREY, STOCKTON, IL
1257
OWNED BY: CHESNEY PRINZ, WEST POINT, NE
1258
OWNED BY: MADDIE JENKINS, ATHENS, TX
1259 11/15/2023
NAOMI SINNAMON- KOKOMO, IN BRED BY:
OWNED BY: NAOMI SINNAMON, KOKOMO, IN ELI SINNAMON, PERU, IN
1260
OWNED BY: GENTRY GUDEL, WILTON, CA
OWNED BY: ABIGAIL SNODDY, GRANDVIEW, TX
OWNED BY: KARSYN KLEEMAN, BRAYMER, MO KADE KLEEMAN, BRAYMER, MO
OWNED BY: PAISLEE LORENZEN, CHRISMAN, IL
1264
OWNED BY: ADALYNN GRACE BLANKENSHIP, WEST BURLINGTON, NY
OWNED BY: ANTHONY MEZRANO, COLUMBIANA, AL
OWNED BY: LANDRY ALLAN, NOCONA, TX
1267
1268
OWNED BY: OLIVIA JONES, BLUE MOUNDS, WI
BY:
OWNED BY: JARRETT SHANE WORRELL, MASON, TX
1269
OWNED BY: MADAILEIN BEARD, ALBANY, TX
1270
OWNED BY: KYA RHODES, ADA, OK
1271 10/20/2023 HAWK RUTH
OWNED BY: LACIE SELLERS, FULTS, IL
629 GEORGIA KAY 357 ET
1272 10/9/2023
OWNED BY: LANDRY ALLAN, NOCONA, TX
OWNED BY: HAYDEN MARIE HOFFMAN, THEDFORD, NE
OWNED BY: KYA
OWNED BY: ELLA WELDON, PIEDMONT, OK
OWNED BY: GRANT HELSINGER, GERMANTOWN, OH LINDIE HELSINGER, GERMANTOWN, OH
OWNED BY: KAITLYN KEITH, CAMPBELLSVILLE, KY
OWNED BY: MAKAYLA MASSEY, LONDON, KY
OWNED BY: BRINLEY DAVIS, MAPLE HILL, KS
DANICA DAVIS, MAPLE HILL, KS
JALYN DAVIS, MAPLE HILL, KS
OWNED BY: ELLA ELIZABETH DEFORD, JARRETTSVILLE, MD
9/9/2023
OWNED BY: FALLON GOHR, MADRAS, OR GUNNAR GOHR, MADRAS, OR
OWNED BY: CLAYTON MUSSER, OTTERBEIN, IN CARLEE A MUSSER, OTTERBEIN, IN CATIE MUSSER, OTTERBEIN, IN
OWNED BY: ELLA BANE, TOWANDA, IL
OWNED BY: CALLIE HARRIS, CANTON, TX
1285
OWNED BY: ELLIE LEHMAN, SULLIVAN, IL
RHETT LEHMAN, SULLIVAN, IL KENT LEHMAN, SULLIVAN, IL
OWNED BY: LIBBY PEREZ, TEXLINE, TX
PEYTON PEREZ, TEXLINE, TX
Grand Champion Owned Horned Female Reserve
BY: ALEXSYS HAMMOND, KINMUNDY, IL
OWNED BY: OLIVIA EUBANK, OBLONG, IL HADLEY EUBANK, OBLONG, IL
OWNED BY: CORBIN PERRY, TOWER HILL, IL CADEN PERRY, TOWER HILL, IL
OWNED BY: CONNER JAMES MCQUAIG, ILA, GA
BY: HARPER ROSE STARNES, FORT PAYNE, AL
BY: SHELBI RUSSELL, FRANKLINTON, LA
OWNED BY: CLAYTON HAYES, ADA, OK
OWNED BY: NATALIE PITSTICK, SOUTH SOLON, OH
1298 12/17/2024
OWNED BY: JILLIAN JOHNSON, NAVARRE, OH EVELYN JOHNSON, NAVARRE, OH
OWNED BY: MARY CARTER SHIRLEY, SPARTA, TN
OWNED BY: EMMA BALLINGER, MCKEE, KY
OWNED BY: ADDISON ACHESON, HOPE, KS
KINSEY ACHESON, HOPE, KS
OWNED BY: KINSLEY ATCHISON, MASON, TX
OWNED BY: NOLAN ATLAS BEAVER, GRANDVIEW, TX
1304 12/11/2024 OCC GO GO
TUCKER OSTGAARD- DAYTON, OH BRED BY:
OWNED BY: RILEY EVONIUK, XENIA, OH
1305
OCC SENSATION A757 ET
OWNED BY: ADALYNN GRACE BLANKENSHIP, WEST BURLINGTON, NY
GO DADDY GIRL A348
1308
OWNED BY: JASE LASBY, SHELBURNE, ON
OWNED BY: EDYNNE BOLTE, PIKEVILLE, TN
12/7/2024 CHRY GENERATION
OWNED BY: RYDER CHERRY, JESUP, IA
1309 12/7/2024 RGR DIANA 315 MAVANA 4117 44662044
OWNED BY: LYLA HARVIE, OLDS, AB TINLEY HARVIE, OLDS, AB
1310
12/5/2024 CHF BF JOYCELYN 4158
OWNED BY: GAGE CREAMER, WAXAHACHIE, TX
GRAHAM CAIN CREAMER, WAXAHACHIE, TX
1311
1313
12/5/2024
OWNED BY: NICHOLAS JONES, DARLINGTON, WI
LAUREN JONES, DARLINGTON, WI
BRADY JONES, DARLINGTON, WI
OWNED BY: ELLA CALLICOTT, ONLY, TN
12/2/2024
OWNED BY: MCKENZIE SLOAN BOYER, VINITA, OK
OWNED BY: JOSHUA KORZENIESKI, HAMLIN, NY
OWNED BY: LUKE BERGERON, BELCHERTOWN, MA
1316
OWNED BY: MACKENZIE PERKINS, NORTH STONINGTON, CT
1317
OWNED BY: WILLIE BOYETTE, ANGIE, LA
1318 11/25/2024 LF 1083 MS
OWNED BY: CHISM HARMS, CHRISMAN, IL
OWNED BY: GRANT HELSINGER, GERMANTOWN, OH LINDIE HELSINGER, GERMANTOWN, OH
1320
OWNED BY: BECKETT BARBER, AMARILLO, TX HENLEY BARBER, AMARILLO, TX
1321
BY: TANA HARVILLE, LEBANON,
TUTWILER, MOUNT SIDNEY, VA
/ Entry / Name
1326
OWNED BY: LANDRY ALLAN, NOCONA, TX
1327
OSTGAARD CATTLE COMPANY- DAYTON, OH BRED BY:
OWNED BY: TUCKER OSTGAARD, DAYTON, OH
OWNED BY: AMBER SHUTSKY, PINNACLE, NC ERICA SHUTSKY, PINNACLE, NC
1329
OWNED BY: ELLA BANE, TOWANDA, IL
OWNED BY: WYATT HOOKER, MOUNT AIRY, NC
CADY W PIEPER- ZURICH, KS
BY: CADY W PIEPER, ZURICH, KS
HALLIE HUGHES, KNOB LICK, KY
BY: MASON MULLINIX, MANHATTAN, KS KINSLEY MULLINIX, MANHATTAN, KS
1336
OWNED BY: JARRETT SHANE WORRELL, MASON, TX
1337
OWNED BY: RYLI HOLLIS, CLYDE, TX
1338 11/10/2024
OWNED BY: CONNELLY WARD, OAK GROVE, MO
ADDISON WARD, OAK GROVE, MO DAVIS WARD, OAK GROVE, MO
OWNED BY: TY PEZANOSKI, PERU, IL
1340
OWNED BY: HENLEY BARBER, AMARILLO, TX
BECKETT BARBER, AMARILLO, TX
OWNED BY: STETSON ROGERS, PATRICK SPINGS, VA
OWNED BY: HOUSTON FOWLER, CARNESVILLE, GA
BY: MICHAEL MEZRANO, COLUMBIANA, AL ANTHONY MEZRANO, COLUMBIANA, AL
OWNED BY: DANIEL RICHARDSON, CAPRON, IL MORGAN RICHARDSON, CAPRON, IL
OWNED BY: HARPER ROSE STARNES, FORT PAYNE, AL
1346
OWNED BY: ADDIE BOURGEOIS, OPELOUSAS, LA
1347
OWNED BY: BLAIR BUEHLER, FAIRBURY, NE
1348 11/4/2024 DAY BRECKYN C1857
OWNED BY: RHETT DAY, TELFORD, TN
1349 11/4/2024 MTM 225 101 MISS LANSING 413
OWNED BY: KADIE JO HURD, RANGER, GA KYLIE HURD, RANGER, GA
1350 11/4/2024 BOFAT HILL
OWNED BY: HARRISON ROBERTS, WILLIAMSBURG, MA
OWNED BY: TENLEY STOLLARD, SULLIVAN, IL
OWNED BY: AUSTIN JUSTUS, FREDERICK, MD
OWNED BY: LEVI MOBLEY, CAMPBELLSBURG, KY
1354 11/2/2024 ATLAS 119E MS MONEY 101H 180M 44662303
BY: PEYTON PEREZ, TEXLINE, TX LIBBY PEREZ, TEXLINE, TX
1356
1357
OWNED BY: WILLIAM SEXTEN, NICHOLASVILLE, KY
LUCY KATE SEXTEN, NICHOLASVILLE, KY
BY:
OWNED BY: MARY GRACE WARDEN, HALFWAY, MO
1358
OWNED BY: MARLEE GRANNIS, FLEMINGSBURG, KY
1359
OWNED BY: BEAU PHILLIP KNIGHT, COMER, GA
1360 10/30/2024
OWNED BY: STETSON ROGERS, PATRICK SPINGS, VA
1361 10/29/2024 MPF AMERICAN HALLIE 1024
BY: ANTHONY JORDAN HALL, HUSTONVILLE, KY
OWNED BY: MARY ELLIOTT MARTIN, AUBURN, AL
1364
OWNED BY: ADALYNN GRACE BLANKENSHIP, WEST BURLINGTON, NY
1365
OWNED BY: MILA PEREZ, CANYON, TX
10/28/2024
PEYTON PEREZ, TEXLINE, TX
BRED BY:
PAISLEE JANE YOUNG- SPRINGVILLE, TN
OWNED BY: KARSYN KLEEMAN, BRAYMER, MO
KADE KLEEMAN, BRAYMER, MO
1368 10/26/2024
NOCONA,
OWNED BY: KYNDAL SADLER, TRYON, OK
KYLEE SADLER, TRYON, OK
BLAINE SADLER, PERKINS, OK
612 HADLEY 461
OWNED BY: SAVANAH GRIMES, MURCHISON, TX
1370 10/25/2024
1371
BPK CES PENNIE LANE B09
OWNED BY: BEAU PHILLIP KNIGHT, COMER, GA
10/25/2024 BAG JOLENE 434 ET 44648564 H WMS THOMAS
OWNED BY: GABRIELA ROJAS, NEW BOSTON, MO
1376
HAWK ARYA 2409 ET 44644234
10/24/2024
OWNED BY: TYMBER BILLMAN, BLACKFOOT, ID
OWNED BY: AVA DOIG, ST PAUL, IN
DOIG, ST PAUL, IN
OWNED BY: WILLIAM FAUST, WASKOM, TX
OWNED BY: KAYTLYN HARFST, BATTLE CREEK, MI
OWNED BY: BENTON MCCLANAHAN, WAVERLY, TN BRYCE MCCLANAHAN, WAVERLY, TN
1378
OWNED BY: SARAH BETH CALLICOTT, ONLY, TN
1379
OWNED BY: KYNDAL SADLER, TRYON, OK
KYLEE SADLER, TRYON, OK BLAINE SADLER, PERKINS, OK
OWNED BY: MACK BUNN, ZEBULON, NC
MAZIE BUNN, ZEBULON, NC
OWNED BY: HADLEY EUBANK, OBLONG, IL
OWNED BY: AUSTIN JUSTUS, FREDERICK, MD
OWNED BY: ADDYSON SWEENEY, VINTON, IA
OWNED BY: KYLIE HURD, RANGER, GA KADIE JO HURD, RANGER, GA
OWNED BY: SAYLOR NORVELL, TUTTLE, OK
OWNED BY: HOLDEN ROEDER, SEGUIN, TX
1389 10/16/2024
OWNED BY: WILL BECKLEY, IRVINE, KY
1390 10/16/2024 BACC 629 GEORGIA KAY 457 ET
OWNED BY: ATLEY KLEINMAN, WENTWORTH, MO
1391 10/16/2024 TDF MISS MONICA M9 ET 44617677
OWNED BY: SALEM EMALINE SIFFORD, GOLDVEIN, VA
SEDONA SIFFORD, GOLDVEIN, VA
VALEDICTORIAN M22
1392 10/15/2024
OWNED BY: STETSON ROGERS, PATRICK SPINGS, VA
1393 10/15/2024 SCC LIONESS 236M 44654516 BR RARE
RYAN & ROBYN SAMSEL- CLOVERDALE, IN BRED BY:
OWNED BY: CALOB WHITE, GARDINER, ME
OWNED BY: LANE CADY, NEW WINDSOR, MD
LOGAN CADY, NEW WINDSOR, MD
10/14/2024 SG MISS BLUEPRINT M94 44634984
OWNED BY: ADDISON KOONTZ, THOMAS, OK JAELYN KOONTZ, THOMAS, OK
OWNED BY: JORDAN LAMB, WILSON, WI
OWNED BY: LUKE KEITH, CAMPBELLSVILLE, KY
KAITLYN KEITH, CAMPBELLSVILLE, KY
BRED BY:
NORA CAVE- ELKIN, NC
OWNED BY: LAUREL MITCHELL, TAYLORSVILLE, NC
OWNED BY: MAGGIE SHEPARD, ALTAMONT, IL
OWNED BY: TAOS HECK, FITZHUGH, OK BRAZOS HECK, FITZHUGH, OK
OWNED
OWNED BY: KRISTIN WATERS, NORBORNE, MO
OWNED BY: NORA LEIGH WERK, MANHATTAN, KS
OWNED BY: GRADY CARTER, STRATFORD, OK HUDSON CARTER, STRATFORD, OK
1407
OWNED BY: KYLIE HOLMAN, HEBRON, OH SADIE HOLMAN, HEBRON, OH
1408
1409
OWNED BY: GRADY COLE CREAMER, WAXAHACHIE, TX
10/9/2024
OWNED BY: EMMA HANCOCK, BOLIVAR, MO
1410 10/7/2024 BACC 629 GEORGIA KAY 456 ET
OWNED BY: LANDRY ALLAN, NOCONA, TX
1411 10/7/2024 KJ 771D HUNTRESS 739M
OWNED BY: TESSA BOOCO, HAYDEN, CO
OWNED BY: DAGAN MURRAY, AUBURN, KS
OWNED BY: BRODY GREENWOOD, HAMILTON, KS
LAYNEE GREENWOOD, HAMILTON, KS
BRADYN GREENWOOD, HAMILTON, KS
OWNED BY: BRAYSON MAYO, SCOTT CITY, KS
10/6/2024
OWNED BY: SADIE WYNNE, NEWCASTLE, OK
OWNED BY: MORGAN RILEY, COLLEGE GROVE, TN
1417
OWNED BY: SERENA ANDERSON, DUNBAR, PA
1418
OWNED BY: PARKER IRWIN, HARTSHORNE, OK
1419 10/4/2024 YB BAMBI 743 427 ET
CRR ABOUT TIME 743
PAISLEE JANE YOUNG- SPRINGVILLE, TN BRED BY:
BAMBI 67D 901 OWNED BY: LAUREN WINGLER, CHRISTIANA, TN
OWNED BY: LOGAN CADY, NEW WINDSOR, MD LANE CADY, NEW WINDSOR, MD
OWNED BY: CORA EVERHART, MORRISTOWN, IN
OWNED BY: BROOKLYN LEINENBACH, HOLLAND, IN
1423
OWNED BY: MEGAN MALLORY, MADISON, VA TRAVIS MALLORY, MADISON, VA
OWNED BY: EVERLY FOSTER, NILES, MI
1425 10/2/2024
1427
1428
OWNED BY: JACE SCHWIETERMAN, SYRACUSE, KS HEIDI SCHWIETERMAN, SYRACUSE, KS
TEXLINE,
OWNED BY: PEYTON PEREZ, TEXLINE, TX LIBBY PEREZ, TEXLINE, TX
OWNED BY: ASHLYN TINGLE, EMINENCE, KY
OWNED
OWNED BY: MARY HANNAH GULLATT, SALEM, AL SILAS GULLATT, SALEM, AL
OWNED BY: JOHN OWEN STARNES, FORT PAYNE, AL
OWNED BY: MAZIE BUNN, ZEBULON, NC MACK BUNN, ZEBULON, NC
OWNED BY: COLLIN DEATSMAN, LEESBURG, IN LANDON L DEATSMAN, LEESBURG, IN
1446
OWNED BY: MARLEE GRANNIS, FLEMINGSBURG, KY
MADELYN GRANNIS, FLEMINGSBURG, KY
BY:
OWNED BY: KEATON KUYKENDALL, GRAHAM, TX
OWNED BY: NORA LEIGH WERK, MANHATTAN, KS
OWNED BY: SAYLOR NORVELL, TUTTLE, OK
MADILYN NORVELL, TUTTLE, OK
OWNED BY: PAISLEE VAN HORN, MORGANTOWN, IN
OWNED BY: MARLEE GRANNIS, FLEMINGSBURG, KY
GRANNIS, FLEMINGSBURG, KY
OWNED BY: MARTINA ALLEY, DANIELSVILLE, GA
OWNED BY: FALLON GOHR, MADRAS, OR GUNNAR GOHR, MADRAS, OR
1447
OWNED BY: PAISLEY MILLER, BELLVILLE, TX
1448
OWNED BY: LEVI WOMACK, PEMBROKE, KY
1449 9/17/2024 BF D87 BAHAMA MAMA 4015 ET 44646036
OWNED BY: CHYLOH BILLMAN, BLACKFOOT, ID
CACHE BILLMAN, BLACKFOOT, ID
TYMBER BILLMAN, BLACKFOOT, ID
1450
OWNED BY: CLAYTON HAYES, ADA, OK
1451
OWNED BY: REID TUTWILER, MT SIDNEY, VA
ASHLEY TUTWILER, MOUNT SIDNEY, VA
OWNED BY: MCKENNA GATZ, FAIRVIEW, KS
LAUREN GATZ, FAIRVIEW, KS
OWNED BY: KENZIE HAWKINS, JANE LEW, WV KORA HAWKINS, JANE LEW, WV
OWNED BY: MEGAN MALLORY, MADISON, VA TRAVIS MALLORY, MADISON, VA
OWNED BY: SYDNEY BETES, MOSES LAKE, WA ADELINA BETES, MOSES LAKE, WA
1456
OWNED BY: NATALIE LISTON, SEVILLE, OH
1458 9/13/2024 KJ 532J COCO
OWNED BY: FOSTER WINGLER, CHRISTIANA, TN
1459 9/12/2024 MCCLAIN
OWNED BY: GARRETT HICKEY, STAUNTON, VA SCOTT HICKEY, STAUNTON, VA
1460
OWNED BY: LOGAN MANSFIELD, LIBERTY, TN
LANDON MANSFIELD, LIBERTY, TN
OWNED BY: SIMON SHEPARD, ALTAMONT, IL
OWNED BY: EMMETT ACHESON, WICHITA, KS
COOPER GENE ACHESON, WICHITA, KS
BY:
OWNED BY: NATE BRAMER, TAYLORSVILLE,
OWNED BY: ANNA TOWNS, DIXON SPRINGS, TN
1467
OWNED BY: GRADY CARTER, STRATFORD, OK HUDSON CARTER, STRATFORD, OK
1468
OWNED BY: LANDON HALL, BOLT, WV
1469
9/8/2024 WERK
OWNED BY: NORA LEIGH WERK, MANHATTAN, KS
OWNED BY: PAIGE DENNISTON, WEST, TX
OWNED BY: ADA MEREDITH, HODGENVILLE, KY
OWNED BY: MAKENNA SMITH, HUBERTUS, WI TESSA SMITH, HUBERTUS, WI
OWNED BY: WILL BECKLEY, IRVINE, KY
1474 9/5/2024 DHB 104 016 VENESSA 4111 ET 44667200 DHB
OWNED BY: SARAH GRACE BIRDSALL, TORRINGTON, WY
SAMUEL C BIRDSALL, TORRINGTON, WY
OWNED BY: CHARLEE ANN KLINK, GARDEN, MI
OWNED BY: ABRAM MEREDITH, HODGENVILLE, KY
OWNED BY: BREA MUSSER, PEARL CITY, IL
1478 9/4/2024
OWNED BY: NATALIE PITSTICK, SOUTH SOLON, OH
1479 9/4/2024
OWNED BY: ELAINA WALSH, GODFREY, IL 1480
BY: LAYNA OTTMERS, FREDERICKSBURG, TX
OWNED BY: BRAYLEN TAYLOR, ALEXANDRIA, KY
OWNED BY: LILY BEISSEL, HAMPTON, MN
OWNED BY: GRADY COLE CREAMER, WAXAHACHIE, TX GAGE CREAMER, WAXAHACHIE, TX
OWNED BY: ALEXANDER HUISHEERE, JANESVILLE, WI
BY: KYLER COOLEY, DRY CREEK, LA
1487
OWNED BY: GAGE CREAMER, WAXAHACHIE, TX
OWNED BY: KRISTIN WATERS, NORBORNE, MO
1489
OWNED BY: MACY MACKE, LAKE CITY, IA
1490 8/28/2024 BP CB MS
OWNED BY: PAISLEE VAN HORN, MORGANTOWN, IN
OWNED BY: HARPER ROSE STARNES, FORT PAYNE, AL
OWNED BY: EVELYN JOHNSON, NAVARRE, OH JILLIAN JOHNSON, NAVARRE, OH
OWNED BY: COLYER SCHAEFFER, HAGERSTOWN, IN
OWNED BY: AMBERLYN CHRISTENBURY, STARR, SC
OWNED BY: LUKE MARCUM, CAMPBELLSVILLE, KY
BY: CRUZ COLYER, BRUNEAU, ID
OWNED BY: MADELYNN WRIGHT, CLINTON, ME
OWNED BY: SALEM EMALINE SIFFORD, GOLDVEIN, VA
SEDONA SIFFORD, GOLDVEIN, VA
1500 8/12/2024
OWNED BY: MARYANN MOORE, HAMLIN, TX
1501 8/11/2024
OWNED BY: JILLIAN JOHNSON, NAVARRE, OH
EVELYN JOHNSON, NAVARRE, OH
1502
1503
1504
OWNED BY: REBECCA VANCAMP, MARION, NY
HAXTON HAROLD HOFFMAN- THEDFORD, NE BRED
OWNED BY: HAXTON HAROLD HOFFMAN, THEDFORD, NE
53
95 TURNER HEREFORD FARM- CLARINGTON, OH BRED BY:
OWNED BY: ELLA KNIGHT, NEWTON GROVE, NC
1505 8/2/2024
OWNED BY: GABRIEL SWALLOW, GARLAND, TX
1506
OWNED BY: CORBIN MICHAEL FINK, WAMEGO, KS CANAAN AUSTIN FINK, WAMEGO, KS
BY: NANCY GAIL BING, SAVOY, TX
OWNED BY: VIVIAN LOU THOMPSON, TROY, AL
OWNED BY: AVA DOIG, ST PAUL, IN
1510 7/22/2024 RFF D87 REMY 42M ET
OWNED BY: RYLI HOLLIS, CLYDE, TX
OWNED BY: GABRIELLE KEETS, BERLIN HEIGHTS, OH
OWNED BY: TENLEY STOLLARD, SULLIVAN, IL
OWNED BY: ELAYNA AUE, AUBURNDALE, WI BREANNA AUE, AUBURNDALE, WI
BY: ANNA TOWNS, DIXON SPRINGS, TN
PAIGE LEMENAGER, HUDSON, IL
BY: GRACIE SIMPSON, STARR, SC
1519
OWNED BY: LANDON HALL, BOLT, WV
1520
OWNED BY: MARY GRACE WARDEN, HALFWAY, MO
1521 7/5/2024 HR 6056 NORA
OWNED BY: ANTHONY MEZRANO, COLUMBIANA, AL
1522 7/5/2024 6B3 BRS BS5 505
OWNED BY: BELLA SMITH, BONHAM, TX
1523
OWNED BY: BRODY SMITH, BONHAM, TX
OWNED BY: SUTER CLARK, GRETNA, VA
OWNED BY: EVERLY FOSTER, NILES, MI
OWNED BY: CHASE HATTAN, VARNA, IL COOPER HATTAN, VARNA, IL
OWNED BY: KOVIN LEWIS, RYAN, OK KOBLE LEWIS, RYAN, OK
OWNED BY: JARRETT SHANE WORRELL, MASON, TX
1530
CADY W PIEPER- ZURICH, KS BRED BY:
OWNED BY: CADY W PIEPER, ZURICH, KS
MAKENNA SMITH- HUBERTUS, WI
OWNED BY: MAKENNA SMITH, HUBERTUS, WI
HISER- MILLEDGEVILLE, OH
OWNED BY: BRYCE GILBERT, MARKLE, IN
OWNED BY: TUCK LOWDERMAN, MACOMB, IL NASH LOWDERMAN, MACOMB, IL
OWNED BY: GENTRY GUDEL, WILTON, CA
OWNED BY: TALUAN HALL, ANGIE, LA
OWNED BY: HAXTON HAROLD HOFFMAN, THEDFORD, NE
HAYDEN MARIE HOFFMAN, THEDFORD, NE
KENNEDY JEAN HOFFMAN, THEDFORD, NE
BY: COLTON PETERSON, ROANOKE, IL
OWNED BY: ELLA WELDON, PIEDMONT, OK
1539
1540
OWNED BY: KENNADY RASMUSSEN, SPRING VALLEY, WI
1541 6/15/2024 6B3 BSS BS5
OWNED BY: BRODY SMITH, BONHAM, TX
1542 6/14/2024 HAWK KP MARLEE 50M ET 44607643 KLD RW MARKSMAN D87 ET 6.1
OWNED BY: BRAYLEN SCHAEFFER, HAGERSTOWN, IN COLYER SCHAEFFER, HAGERSTOWN, IN
OWNED BY: SAGE E LAWRENCE, AVILLA, IN
OWNED BY: RYAN OLESON, ARKDALE, WI
OWNED BY: CONNOR RHOADS, CHRISMAN, IL
OWNED BY: KYLAN HELMS, HOLBROOK, NE
OWNED BY: JANIE KAY, LIMESTONE, TN
CARLEE A MUSSER- OTTERBEIN, IN
OWNED BY: CLAYTON MUSSER, OTTERBEIN, IN
CARLEE A MUSSER, OTTERBEIN, IN CATIE MUSSER, OTTERBEIN, IN
1549
1550
1551
1552
59
OWNED BY: COLIN HUELSMANN, RALEIGH, IL
JUSTIN A REED- LOCKRIDGE, IA BRED BY:
OWNED BY: REED NAUGHTON, ATLANTA, IL
93 DANIEL RICHARDSON- CAPRON, IL
BY:
OWNED BY: DANIEL RICHARDSON, CAPRON, IL
MORGAN RICHARDSON, CAPRON, IL
BY:
DAWSON RAMSDELL- LIMINGTON, ME
OWNED BY: BENJAMIN TAMMARO, CAPE ELIZABETH, ME
OWNED BY: LAUREN GATZ, FAIRVIEW, KS
MCKENNA GATZ, FAIRVIEW, KS
OWNED BY: MAGGIE REED, GREEN RIDGE, MO
OWNED BY:
OWNED
OWNED BY: MAYZE MARSHALL, BEAVER, OK
1561 6/1/2024 MYO 0143 CHANDON 464
OWNED BY: BRAYSON MAYO, SCOTT CITY, KS
1567
OWNED BY: ADDISON WARD, OAK GROVE, MO
BY: WYATT GUNN, GREENFIELD, IN MADDOX GUNN, GREENFIELD, IN
CACHE BILLMAN, BLACKFOOT, ID
OWNED BY: ANNABELL F CRABTREE, LIBERAL, MO
BY: MACALIE FORREST, FOSTER, RI
OWNED BY: KINZLEY EVANS, FREDONIA, KS KALLEN EVANS, FREDONIA, KS
1569
1570
OWNED BY: MACKENZIE RAMSDELL, LIMINGTON, ME
1571
OWNED BY: LOGAN BRYANT RHOADS, CHRISMAN, IL
OWNED BY: GAVIN RHODE, STEWARTSVILLE, MO
OWNED BY: BLAIR SMITH, GOODWIN, NC
1574
1576
1577
OWNED BY: CHANTZ DEGROAT, WANTAGE, NJ
RHIANNON CONOVER, WANTAGE, NJ
KADEN CONOVER, WANTAGE, NJ GAGE DEGROAT, WANTAGE, NJ
OWNED BY: JACKSON MASSEY, PIKEVILLE, TN
5/16/2024
OWNED BY: NORA LEIGH WERK, MANHATTAN, KS
5/15/2024
1579
OWNED BY: JASE BELTZ, CANTON, KS JOSIE BELTZ, CANTON, KS
1580
BRED BY:
OWNED BY: MACY MICHELINI, PERU, IL
1581
OWNED BY: FALLON GOHR, MADRAS, OR GUNNAR GOHR, MADRAS, OR
OWNED BY: EMMA HACKBART, MILFORD, NE
TRIPP OSTGAARD, NEWARK, OH
BY: GRADY CARTER, STRATFORD, OK HUDSON
OWNED BY: CORA BELLE CHAPMAN, SENECA, IL
OWNED BY: SUTTER DANEKAS, WOODLAND, CA
OWNED BY: LANDON HALL, BOLT, WV
1590
OWNED BY: MIRANDA HANSEN, CHECOTAH, OK
KRISTIN HANSEN, CHECOTAH, OK
1591 5/11/2024
OWNED BY: ELLA WELDON, PIEDMONT, OK
1592
5/10/2024 HBCC KATRINA 42M
BRED BY:
RAEGAN HEAD- BLUE MOUND, IL
OWNED BY: RYLEE CHERRY, WINTHROP, IA
OWNED BY: JEB PAINTER, GANDEEVILLE, WV
CH HIGH ROLLER 756 ET
1594
OWNED BY: BAILEY PEARL, DUQUOIN, IL
SHELBY PEARL, DUQUOIN, IL
1595 5/10/2024
OWNED BY: KYA RHODES, ADA, OK
1596
DHB104 2056 LAURA 4055
5/9/2024
OWNED BY: SAMUEL C BIRDSALL, TORRINGTON, WY
SARAH GRACE BIRDSALL, TORRINGTON, WY
1597
OWNED BY: SHERIDAN ELIZABETH CHANEY, KEYMAR, MD RIANNA KATHRYN CHANEY, KEYMAR, MD
OWNED BY: KATIE COX, MCNAB BRAESIDE, ON
1599
OWNED BY: EMMA DAVISSON, CALAMUS, IA COLTON DAVISSON, CALAMUS, IA
1601
1602
OWNED BY: WESTYN ZEB MURPHREE, HAMILTON, TX
5/8/2024
OWNED BY: MAELEE POARCH, LEWISBURG, TN
ELLIE POARCH, LEWISBURG, TN
OWNED BY: ADDISON ROSE YOUNG, LEXINGTON, IL
HATTIE YOUNG, LEXINGTON, IL
OLIVIA YOUNG, LEXINGTON, IL
OWNED BY: CADENCE HARRIS, SALADO, TX
1604 5/6/2024 HSC NOLA 326M 44663363 BAR STAR FRESH PRINCE
OWNED BY: DREW MELENDREZ, DIXON, IL
OWNED BY: BLAKE DAY, LOUP CITY, NE BROOKE DAY, LOUP CITY, NE
OWNED BY: OLIVIA EUBANK, OBLONG, IL HADLEY EUBANK, OBLONG, IL
1607
OWNED BY: KINZLEY EVANS, FREDONIA, KS
KALLEN EVANS, FREDONIA, KS
1608
OWNED BY: RAE'KYN ROCHELL, DUNCAN, OK
1609
1610
OWNED BY: ADDISON ACHESON, HOPE, KS KINSEY ACHESON, HOPE, KS
BY:
CO
OWNED BY: SAMANTHA LYNN CAMPBELL, EATON, CO
OWNED BY: KILEE GRACE LOVIN, LEXINGTON, GA KATE RAE LOVIN, LEXINGTON, GA
1615
OWNED BY: KEELEY WARNKEN, SCHULENBURG, TX
OWNED BY: BECKETT BARBER, AMARILLO, TX
HENLEY BARBER, AMARILLO, TX
OWNED BY: TESSA BOOCO, HAYDEN, CO
5/3/2024
OWNED BY: ELLA CRANE, LASALLE, IL JOHN WILFRED CRANE, LA SALLE, IL
OWNED BY: MARLEE GRANNIS, FLEMINGSBURG, KY MADELYN GRANNIS, FLEMINGSBURG, KY
1617
1618
1619
OWNED BY: HAXTON HAROLD HOFFMAN, THEDFORD, NE
HAYDEN MARIE HOFFMAN, THEDFORD, NE
KENNEDY JEAN HOFFMAN, THEDFORD, NE
OWNED BY: BROGAN KELTNER, PEARL CITY, IL
BY:
OWNED BY: ATLEY KLEINMAN,
OWNED BY: WYATT MCINTYRE, LEEDEY, OK QUAID MCINTYRE, LEEDEY, OK
OWNED BY: CLAIBORNE PERRY, MADISON, MS
OWNED BY: DANIEL RICHARDSON, CAPRON, IL MORGAN RICHARDSON, CAPRON, IL
OWNED BY: PAISLEE VAN HORN, MORGANTOWN, IN
OWNED BY: KERRIGAN BAUSERMAN, STRASBURG, VA
OWNED BY: ADALYNN GRACE BLANKENSHIP, WEST BURLINGTON, NY
1626
OWNED BY: BRODY GREENWOOD, HAMILTON, KS
BRADYN GREENWOOD, HAMILTON, KS
LAYNEE GREENWOOD, HAMILTON, KS
1627
OWNED BY: LAYTON HOPKINS, TRIBUNE, KS LINCOLN HOPKINS, TRIBUNE, KS
1628
OWNED BY: EMMA STEPHENS, MORRISTOWN, IN
1629 5/1/2024
OWNED BY: TEAGEN HAMES, TUTTLE, OK
1630
OWNED BY: CALLIE HARRIS, CANTON, TX
1631
OWNED BY: PIPER SEISS, THURMONT, MD
OWNED BY: MAKENNA SMITH, HUBERTUS, WI
OWNED BY: JULIA STUDER, FRANKFORT, KS
JACQUELINE STUDER, FRANKFORT, KS
JOHANNA STUDER, FRANKFORT, KS CAROLINE STUDER, FRANKFORT, KS
OWNED BY: MIA WALSH, MURDOCK, MN
OWNED BY: KEATON KUYKENDALL, GRAHAM, TX
1636
OWNED BY: BENJAMIN WEBERT, WARRENTON, VA WILLIAM WEBERT, WARRENTON, VA
1640
OWNED BY: JASE BELTZ, CANTON, KS JOSIE BELTZ, CANTON, KS
BY:
OWNED BY: BRILEY FIX, SHELBYVILLE, IN LANDON FIX, SHELBYVILLE, IN
OK
OWNED BY: JARRETT SHANE WORRELL, MASON, TX
OWNED BY: CLAYTON HEINS, NEW SALEM, ND
1641
OWNED BY: ANNIE EVERHART, MORRISTOWN, IN
1642
OWNED BY: KENNEDY JEAN HOFFMAN, THEDFORD, NE
1643
OWNED BY: KOVIN LEWIS, RYAN, OK KOBLE LEWIS, RYAN, OK
OWNED BY: JESSILYN MILLER, LAKEVILLE, OH
PAISLEE VAN HORN- MORGANTOWN, IN BRED BY:
OWNED BY: MADISON BAUER, BONFIELD, IL
OWNED BY: ALISHA KLEMME, PLYMOUTH, WI
1647
OWNED BY: KRAITON CARPENTER, LEEDEY, OK
1648
OWNED BY: ASHLEE DEMOLLES, WEST BRIDGEWATER, MA
1649 4/24/2024 DF ACD
OWNED BY: ADDISON DUIS, PETERSBURG, IL
1650
OWNED BY: DELANEY FIGGE, ONAGA, KS TYREE E FIGGE, ONAGA, KS
1651
OWNED BY: KYNDAL SADLER, TRYON, OK KYLEE SADLER, TRYON, OK
OWNED BY: ANNA TOWNS, DIXON SPRINGS, TN
OWNED BY: ASHLEY
OWNED BY: EMMA HACKBART, MILFORD,
1657
OWNED BY: NOLAN ORWIG, TOULON, IL
1658
OWNED BY: HARPER ROSE STARNES, FORT PAYNE, AL
1659 4/22/2024 SCC 286W SADIE 2437 ET 44604871
OWNED BY: MADDIE JENKINS, ATHENS, TX
1660 4/22/2024 AUBREYS STAR CAPRI 4054 2M 44570466 INNISFAIL
OWNED BY: SADIE ZAENGER, MCCUTHENVILLE, OH
1661 4/21/2024 RGR KELLY MISS G 1004 ET
OWNED BY: WESTON LAMPE, PETERSBURG, IL
OWNED BY: CLAYTON MUSSER, OTTERBEIN, IN CARLEE A MUSSER, OTTERBEIN, IN CATIE MUSSER, OTTERBEIN, IN
OWNED BY: NOLAN ORWIG, TOULON, IL
OWNED BY: SHELBY SIEMER, SIGEL, IL
OWNED BY: HADLEY HARRISON, MONTAGUE, CA HANNAH HARRISON, MONTAGUE, CA
OWNED BY: CHYLOH BILLMAN, BLACKFOOT, ID CACHE BILLMAN, BLACKFOOT, ID TYMBER BILLMAN, BLACKFOOT, ID
1667
OWNED BY: RHETT DAY, TELFORD, TN
1668
OWNED BY: BECKETT BARBER, AMARILLO, TX HENLEY BARBER, AMARILLO, TX
1669
1670
1671
OWNED BY: JORJA EBERT, POLO, MO
4/16/2024 HR 704E
OWNED BY: ELLIE POARCH, LEWISBURG, TN
MAELEE POARCH, LEWISBURG, TN
OWNED BY: BRYCE LEWIS, RYAN, OK
1672
OWNED BY: CHESNEY PRINZ, WEST POINT, NE
1673 4/13/2024 RW 5K SHELBY 413M 44671009 PCL 183F KASHMIR 5K
DOUBLE H CATTLE COMPANY- MCNAB BRAESIDE, ON BRED BY:
OWNED BY: CONNOR MCNAUGHTON, GRAVENHURST, ON
1674
OWNED BY: ELLA WALSH, DEGRAFF, MN
1675
4/12/2024 KLM
1677
1678
OWNED BY: EMILY TROYER, PYLESVILLE, MD
OWNED BY: AIDYN BARBER, CHANNING, TX
OWNED BY: ELLA ELIZABETH DEFORD, JARRETTSVILLE, MD
OWNED BY: JORJA EBERT, POLO, MO
OWNED BY: MACY MICHELINI, PERU, IL
OWNED BY: ELLA WELDON, PIEDMONT, OK
OWNED BY: OLIVIA EUBANK, OBLONG, IL HADLEY EUBANK, OBLONG, IL
OWNED BY: KYLIE GILLESPIE, TOULON, IL
MARLEE GRANNIS- FLEMINGSBURG, KY
OWNED BY: MARLEE GRANNIS, FLEMINGSBURG, KY
MADELYN GRANNIS, FLEMINGSBURG, KY
1687
1688
1689
OWNED BY: KYLIE HOLMAN, HEBRON, OH
SADIE HOLMAN, HEBRON, OH
OWNED BY: DEVON ELIZABETH LOCKHART, CALDWELL, TX
TR PUTZ- OTLEY, IA BRED
OWNED BY: TR PUTZ, OTLEY, IA
COLBY PUTZ, OTLEY, IA
DAX PUTZ, OTLEY, IA
1690 4/10/2024 CHF 132E VICKI 4074 44587622 NJW 76C
OWNED BY: HANNAH TAYLOR, PETERSBURG, WV
OWNED BY: DANIELLE SARAH ZILBERSTEIN, NEVADA, TX
OWNED BY: KENDALL DEVINE, CHICKASHA, OK HAYES DEVINE, CHICKASHA, OK
BY: JOSEPH SCHOHR, OROVILLE, CA
OWNED BY: PAISLEY MILLER, HOPKINS, MI
1697
OWNED BY: CONNOR RHOADS, CHRISMAN, IL
1698
OWNED BY: ELLA WELDON, PIEDMONT, OK
1699
OWNED BY: AVA DOIG, ST PAUL, IN BREMLEY DOIG, ST PAUL, IN
OWNED BY: LEVI WOMACK, PEMBROKE, KY
OWNED BY: AMBERLYN CHRISTENBURY, STARR, SC
OWNED BY: GRAHAM CAIN CREAMER, WAXAHACHIE, TX 1703
INDIANOLA, IL
BY: LILY DEATH, INDIANOLA, IL
OWNED BY: BRYAR FLEISHER, KNOXVILLE, IL EMERSYN FLEISHER, KNOXVILLE, IL
BY: HADLEY HARRISON, MONTAGUE, CA HANNAH HARRISON, MONTAGUE, CA
1709
OWNED BY: ADDISON WARD, OAK GROVE, MO
CONNELLY WARD, OAK GROVE, MO
DAVIS WARD, OAK GROVE, MO
CATTLE COMPANY- GLENCOE, OK BRED BY:
OWNED BY: DELANEY CHESTER, OREGONIA, OH
JONES- DARLINGTON, WI
OWNED BY: BROGAN KELTNER, PEARL CITY, IL
1710
OWNED BY: PAISLEE LORENZEN, CHRISMAN, IL
1711
OWNED BY: MILA PEREZ, CANYON, TX
1712 4/4/2024 ROCKIN' C
OWNED BY: MADISON PERKINS, NORTH STONINGTON, CT
1714
OWNED BY: ADALYNN GRACE BLANKENSHIP, WEST BURLINGTON, NY
4/3/2024 RWCC BREATHLESS 439M ET
44588079
OWNED BY: CORBIN MICHAEL FINK, WAMEGO, KS CANAAN AUSTIN FINK, WAMEGO, KS
OWNED BY: EVAN JACKSON, HOLLADAY, TN
OWNED BY: BRYCE LEWIS, RYAN, OK
1717
OWNED BY: BRAYSON MAYO, SCOTT CITY, KS
1718
OWNED BY: MARLYN PECHA, MENO, OK
1719
4/3/2024 JLC 266H
OWNED BY: MADELYN GRACE THOMPSON, AMITY, MO BRYNLEE ANN THOMPSON, AMITY, MO
1720
OWNED BY: REBECCA VANCAMP, MARION, NY
1721 4/2/2024 ROOKER SJ MERRY ELLEN 2419
OWNED BY: DOROTHY MARIE DEFORD, JARRETTSVILLE, MD
OWNED BY: MACALIE FORREST, FOSTER, RI
OWNED BY: ISABELLA HEWITT, BRANCHVILLE, NJ
BY: BROOKLYN LEINENBACH, HOLLAND, IN
OWNED BY: ELIZABETH SCHAUB, THOSBY, AB
OWNED BY: RYLEE STOCKDALE, DAYTON, PA
1727
OWNED BY: CAROLINE STUDER, FRANKFORT, KS
JULIA STUDER, FRANKFORT, KS
JACQUELINE STUDER, FRANKFORT, KS
JOHANNA STUDER, FRANKFORT, KS
1728 4/2/2024
ADDISON ROSE YOUNG- LEXINGTON, IL BRED BY:
OWNED BY: ADDISON ROSE YOUNG, LEXINGTON, IL
1729
OWNED BY: COOPER GENE ACHESON, WICHITA, KS EMMETT ACHESON, WICHITA, KS
OWNED BY: AIDYN BARBER, CHANNING, TX
OWNED BY: BARRETT CARPER, VEVAY, IN
1732 4/1/2024
722K JENNY 41M 44561707
OWNED BY: AVERY EVERHART, MORRISTOWN, IN
OWNED BY: WYATT MCINTYRE, LEEDEY, OK QUAID MCINTYRE, LEEDEY, OK
BY: MICHAEL MEZRANO, COLUMBIANA, AL
OWNED BY: TY ANDERSON, MORTON, IL
OWNED BY: DOROTHY MARIE DEFORD, JARRETTSVILLE, MD
1737
1738
OWNED BY: KERRIGAN BAUSERMAN, STRASBURG, VA
OWNED BY: SAGE E LAWRENCE, AVILLA, IN
OWNED BY: LOGAN BRYANT RHOADS, CHRISMAN, IL
OWNED BY: COLTON DAVISSON, CALAMUS, IA EMMA DAVISSON, CALAMUS, IA
OWNED BY: BRAXTON LOCKHART, CALDWELL, TX
OWNED BY: MADELINE SCHOHR, OROVILLE, CA
JOSEPH SCHOHR, OROVILLE, CA
3/28/2024
C 651 BREEZE 474 ET 44602049 BACC 286W
OWNED BY: ADDISON ACHESON, HOPE, KS
KINSEY ACHESON, HOPE, KS
OWNED BY: MASON MULLINIX, MANHATTAN, KS
KINSLEY MULLINIX, MANHATTAN, KS
1748
OWNED BY: LILLY ANDERSON, MORTON, IL
ALLIE ANDERSON, MORTON, IL
TY ANDERSON, MORTON, IL
GRIFFIN ANDERSON, MORTON, IL
IL
OWNED BY: ELLA BROOKS, PROPHETSTOWN, IL
OWNED BY: ELLA ELIZABETH DEFORD, JARRETTSVILLE, MD
1749
OWNED BY: RILEIGH MEARS, CLEVELAND, AL
1751
1752
OWNED BY: JESSICA MEZRANO, COLUMBIANA, AL
3/26/2024
OWNED BY: MATTHEW H ELZEMEYER, RICHMOND, IN
3/26/2024
OWNED BY: KYNSLEIGH KREBS, GORDON, NE
OWNED BY: KENNEDY RIFE, COLUMBUS JUNCTION, IA
BY: COLIN HUELSMANN, RALEIGH, IL
1756
OWNED BY: JACE KENADY, PLAINVILLE, IL
OWNED BY: ADDISON ROSE YOUNG, LEXINGTON, IL
1758 3/24/2024
OWNED BY: BRAXTON CARPER, VEVAY, IN BARRETT CARPER, VEVAY, IN
1759 3/24/2024
OWNED BY: AIDAN KNOBLOCH, BUCKINGHAM, IL
OWNED BY: LENA ANN MAY, GREENFIELD, IN
3/24/2024
GEORGETTA M24 ET 44590846 PURPLE COBAIN 30D ET
JAKE THOMPSON- MAPLE PARK, IL
OWNED BY: RYAN TAMMARO, CAPE ELIZABETH, ME
OWNED BY: ELLA BROOKS, PROPHETSTOWN, IL
1763 3/23/2024 MOHICAN VACA 65M ET 44558389
OWNED BY: CREIGHTON SMITH, GEORGETOWN, KY
WARREN SMITH, GEORGETOWN, KY
SOPHIA SMITH, GEORGETOWN, KY
CLARK SMITH, GEORGETOWN, KY
OWNED BY: CRUZ COLYER, BRUNEAU, ID
OWNED BY: CONNOR RHOADS, CHRISMAN, IL
1766
OWNED BY: ELLA WELDON, PIEDMONT, OK
OWNED BY: KOVIN LEWIS, RYAN, OK
1768 3/20/2024 GSF TAYLOR
GEM STONE FARM- TANEYTOWN, MD
BY: LUCY FLYNN, TANEYTOWN, MD
OWNED BY: GRANT HELSINGER, GERMANTOWN, OH
OWNED BY: CAMI MILLER, EL DORADO, KS CALLY MILLER, EL DORADO, KS
OWNED BY: PHILLIP MUELLER, PERRYVILLE, MO
EMMALEE MUELLER, PERRYVILLE, MO
OWNED BY: MADYSON RASMUSSEN, SPRING VALLEY, WI
OWNED BY: BRAYLEN TAYLOR, ALEXANDRIA, KY
OWNED BY: JACKSON MASSEY, PIKEVILLE, TN
1778 3/18/2024 SLDK CREEKS MISS MIRELA M08 ET 44601002
OWNED BY: MORGAN ROGERS, SOLON, IA
MCKENNA ROGERS, SOLON, IA
1779
3/18/2024 MAV COTTONS ANNIE 430M ET 44620023
OWNED BY: ADDISON WARD, OAK GROVE, MO
CONNELLY WARD, OAK GROVE, MO
DAVIS WARD, OAK GROVE, MO
OWNED BY: JACKSON WRIGHT, EWING, NE
OWNED BY: MADDISON BEISSEL, HAMPTON, MN
LILY BEISSEL, HAMPTON, MN
OWNED BY: LUKE BERGERON, BELCHERTOWN, MA
1783
OWNED BY: ELLA FRITZ, WESTMINSTER, MD
1784 3/17/2024 HOFFMAN
OWNED BY: HAXTON HAROLD HOFFMAN, THEDFORD, NE
OWNED BY: PEYTON PEREZ, TEXLINE, TX LIBBY PEREZ, TEXLINE, TX
OWNED BY: ADDIE BOURGEOIS, OPELOUSAS, LA
OWNED BY: ALISON GEORGE, MONDOVI, WI
OWNED BY: HALLIE HUGHES, KNOB LICK, KY
OWNED BY: TIMBER HULA, CRESTON, NE
OWNED BY: CALEIGH ALLISON, NEVADA, TX
OWNED BY: CRICKET A COLLINS, CHATTANOOGA, OK
CIERRA V COLLINS, CHATTANOOGA, OK
CLAIRE M COLLINS, CHATTANOOGA, OK
OWNED BY: DOROTHY MARIE DEFORD, JARRETTSVILLE, MD
BY: JACKSON MASSEY, PIKEVILLE, TN
OWNED BY: ELLA BROOKS, PROPHETSTOWN, IL
OWNED BY: CAITLYN CLAPPER, MAGNOLIA, TX
1798 3/14/2024
OWNED BY: PAXTON HOVLEY, PAYETTE, ID
1799 3/14/2024 WILDCAT VIOLIN 4939 ET 44589456
OWNED BY: NICHOLAS JONES, DARLINGTON, WI
BRADY JONES, DARLINGTON, WI
LAUREN JONES, DARLINGTON, WI
1800 3/14/2024
OWNED BY: JAMES SLADEK, IOWA CITY, IA
1801
3/13/2024
OWNED BY: ATLEY KLEINMAN, WENTWORTH, MO
1802 3/13/2024
KALEIGH MCNAUGHTON- GRAVENHURST, ON BRED BY:
OWNED BY: KALEIGH MCNAUGHTON, GRAVENHURST, ON COOPER MCNAUGHTON, GRAVENHURST, ON
DONNA
OWNED BY: ANTHONY MEZRANO, COLUMBIANA, AL
1804 3/13/2024
MIRAGE 410 ET
KLD RW MARKSMAN D87 ET 5.5 55 27 92
OWNED BY: HOLDEN ROEDER, SEGUIN, TX
1805 3/13/2024
OWNED BY: AINSLEY WILLIAMS, VAN ALSTYNE, TX
1806
OWNED BY: COLE DIEBALL, LITTLE RIVER, KS
1807
OWNED BY: LYLA HARVIE, OLDS, AB TINLEY HARVIE, OLDS, AB
1808
OWNED BY: JEB PAINTER, GANDEEVILLE, WV
OWNED BY: CASE PRESSNALL, RANDOLPH, MN
OWNED BY: LOGAN BRYANT RHOADS, CHRISMAN, IL
OWNED BY: ALYSSA SATKOWSKI, COLUMBIA, CT
OWNED BY: HEIDI SCHWIETERMAN, SYRACUSE, KS JACE SCHWIETERMAN, SYRACUSE, KS
OWNED BY: DELANEY TRUEBENBACH, KNIGHTSTOWN, IN
OWNED BY: MARY GRACE WARDEN, HALFWAY, MO
1815 3/11/2024
OWNED BY: BROOKE AUE, AUBURNDALE, WI
1816
OWNED BY: DANICA DAVIS, MAPLE HILL, KS
1817
OWNED BY: JASE BELTZ, CANTON, KS
JOSIE BELTZ, CANTON, KS
1818 3/10/2024 BK MIGHTY SWEET
OWNED BY: MACALIE FORREST, FOSTER, RI
1819
3/10/2024 L2 LCC 2278 ADELINE 2441
44560254 ECR
OWNED BY: NASH LOWDERMAN, MACOMB, IL TUCK LOWDERMAN, MACOMB, IL
1820
PAINTED ROSE
3/10/2024
OWNED BY: BRONSON MARSTON, AGENDA, KS
TRIGG MARSTON, AGENDA, KS
1821
OWNED BY: SAVANNAH RITENOUR, FORT VALLEY, VA
1822 3/10/2024 GGSC KAYLOR 14M ET 44587378
OWNED BY: MORGAN RILEY, COLLEGE GROVE, TN
1823 3/10/2024 KJ F31 PERFECT MISS 567M
OWNED BY: MASON ROEDER, SEGUIN, TX
1824 3/10/2024 GREEN LGL 007K
OWNED BY: BO TODD, MOUNT VERNON, KY
ELLEN TODD, MOUNT VERNON, KY
OWNED BY: BO TODD, MOUNT VERNON, KY
ELLEN TODD, MOUNT VERNON, KY
1826
OWNED BY: BRYCE BRANCEL, ENDEAVOR, WI
1827
OWNED BY: EMMA LYNN, PURCELL, OK
1828 3/8/2024 JRR PONCHO TIME 424M 44583330
OWNED BY: MADDISON BEISSEL, HAMPTON, MN LILY BEISSEL, HAMPTON, MN
1829 3/8/2024
OWNED BY: BLAKE BRANCEL, ENDEAVOR, WI BRYCE BRANCEL, ENDEAVOR, WI
OWNED BY: TINLEY HARVIE, OLDS, AB LYLA HARVIE, OLDS, AB
OWNED BY: CALEB PRONSCHINSKE, COCHRANE, WI
1833
OWNED BY: CHLOE ROGERS, IOWA CITY, IA
RANCH- AGENDA, KS
OWNED BY: ROLAND SANDBERG, AGENDA, KS
REESE SANDBERG, AGENDA, KS
RYNE SANDBERG, AGENDA, KS
OWNED BY: MADELYN WEABER, WAMEGO, KS
COOPER BISHOP WEABER, WAMEGO, KS
WYATT WEABER, WAMEGO, KS
1835
OWNED BY: LOGAN CADY, NEW WINDSOR, MD
1836
OWNED BY: SUTER CLARK, GRETNA, VA
1837 3/7/2024
OWNED BY: BELLA PRESSNALL, RANDOLPH, MN
1838 3/7/2024
OWNED BY: MCKENNA ROGERS, SOLON, IA MORGAN ROGERS, SOLON, IA
OWNED BY: KEELEY WARNKEN, SCHULENBURG, TX
OWNED BY: REESE ANDERSON, ALPHA, MN
OWNED BY: TAYLOR KENDALL BOATMAN, ROCKFORD, IL THOMAS KADE BOATMAN, ROCKFORD, IL
OWNED BY: ALISON GEORGE, MONDOVI, WI
1843
BY: KENZIE HAWKINS, JANE LEW, WV
1845
OWNED BY: LIBBY PEREZ, TEXLINE, TX
1846
OWNED BY: ELLA WELDON, PIEDMONT, OK
1847 3/5/2024 FF SSS FANCY 2483
OWNED BY: EMILY FRITZ, WESTMINSTER, MD
1848
OWNED BY: JORDAN MITCHEM, VALE, NC
1852
OWNED BY: KAYLEE REVIS, LEICESTER, NC ADDISON REVIS, LEICESTER, NC
1853
OWNED BY: GRACIE SIMPSON, STARR, SC
1854
OWNED BY: FAITH BENEDICT, DEWEY, IL
3/4/2024
OWNED BY: LAUREL CORNELL, BERLIN, PA
3/4/2024 MCF 2204
OWNED BY: RYAN GARNHART, GERMAN VALLEY, IL
3/4/2024 SLC 30F CALLY 8M
44583712 NST GAT H 54B RAY 30F ET 5.1 65 35 106 CORY STUMPF- COLUMBIA, IL BRED BY:
OWNED BY: RHETT LEHMAN, SULLIVAN, IL
KENT LEHMAN, SULLIVAN, IL
ELLIE LEHMAN, SULLIVAN, IL
of 6/23/2025 Judges will receive the
1855
OWNED BY: BRAYSON MAYO, SCOTT CITY, KS
1856
OWNED BY: HANNAH OLESON, ARKDALE, WI
1857 3/4/2024 OCC TWO KAMILLA A772
TUCKER OSTGAARD- DAYTON, OH BRED BY:
OWNED BY: TUCKER OSTGAARD, DAYTON, OH
OCC GEMSTONE A727
1858
OWNED BY: RILEY GREGORY RHODES, CARLINVILLE, IL
OWNED BY: LANDRY ALLAN, NOCONA, TX
OWNED BY: AIDYN BARBER, CHANNING, TX
OWNED BY: FALLON GOHR, MADRAS, OR GUNNAR GOHR, MADRAS, OR
1862 3/3/2024 SH/DD KL NALA
OWNED BY: BRADYN GREENWOOD, HAMILTON, KS
LAYNEE GREENWOOD, HAMILTON, KS
BRODY GREENWOOD, HAMILTON, KS
OWNED BY: AUSTIN JUSTUS, FREDERICK, MD
AGENDA, KS
OWNED BY: RYNE SANDBERG, AGENDA, KS
ROLAND SANDBERG, AGENDA, KS
REESE SANDBERG, AGENDA, KS
1866
1867
1868
OWNED BY: CRAYTON CHAPMAN, SENECA, IL
CORA BELLE CHAPMAN, SENECA, IL
OWNED BY: GABE CRUTCHER, MONTROSE, IL
TREVOR CRUTCHER, MONTROSE, IL
SHAWN CRUTCHER, MONTROSE, IL
OWEN CRUTCHER, MONTROSE, IL
OWNED BY: MACALIE FORREST, FOSTER, RI
OWNED BY: OLIVIA MCARTHUR, PITTSFORD, MI
OWNED BY: HADLEY HARRISON, MONTAGUE, CA HANNAH HARRISON, MONTAGUE, CA
BY: ELAYNA HAWKINS, FREEPORT, MI
BRED BY:
RIDGEVIEW FARM- ALTO, MI
OWNED BY: ELAYNA HAWKINS, FREEPORT, MI
OWNED BY: CALLIE F SCHMIDT, BLUE RAPIDS, KS
SPENCER SCHMIDT, BLUE RADIDS, KS
LEXI SCHMIDT, BLUE RAPIDS, KS
1874
OWNED BY: PIPER TUCKER, ADA, OK
1875
OWNED BY: DREW BALLARD, INMAN, KS
MARLEE BALLARD, INMAN, KS
1876
2/29/2024 EF
OWNED BY: ELIZA EVERHART, MORRISTOWN, IN
1877
2/28/2024 GS KELLEE
OWNED BY: ELLA ELIZABETH DEFORD, JARRETTSVILLE, MD
OWNED BY: KIAN MORRIS, WILBER, NE
OWNED BY: AVERY WAGNER, HULL, IA
WAGNER, HULL, IA
JEAN WAGNER, HULL, IA
OWNED BY: KIERA BREMER, FULLERTON, NE KINSLEY BREMER, FULLERTON, NE
BY: COLE DIEBALL, LITTLE RIVER, KS
BY: MADELYN RAMSDELL, LIMINGTON, ME
OWNED BY: WHITTEN ALEC SCARPINATO, MASON, TX
OWNED BY: CHARLEIGH BIRDSELL, ENNICE, NC
OWNED BY: JASE KLINK, GARDEN, MI
OWNED BY: PAIGE LEMENAGER, HUDSON, IL
BY: CONNOR RHOADS, CHRISMAN, IL
NELLA RANCH- AGENDA, KS BRED BY:
OWNED BY: ROLAND SANDBERG, AGENDA, KS
REESE SANDBERG, AGENDA, KS
RYNE SANDBERG, AGENDA, KS
OWNED BY: MARY GRACE WARDEN, HALFWAY, MO
1891 2/25/2024
OWNED BY: COOPER GENE ACHESON, WICHITA, KS
EMMETT ACHESON,
OWNED BY: SUTER CLARK, GRETNA, VA
OWNED BY: FALLON GOHR, MADRAS, OR GUNNAR GOHR, MADRAS, OR
OWNED BY: KYLIE HOLMAN, HEBRON, OH SADIE HOLMAN, HEBRON, OH
OWNED BY: FOX LONEY, ADA, MI
OWNED BY: PHILLIP MUELLER, PERRYVILLE, MO EMMALEE MUELLER, PERRYVILLE, MO
OWNED BY: BAYLEE D SMITH, CHECOTAH, OK
612 HADLEY 417 ET
1898 2/24/2024
OWNED BY: DELANEY CHESTER, OREGONIA, OH
SR DOMINATE 308F ET 6.3
OWNED BY: SUTTER DANEKAS, WOODLAND, CA
ET LAYNA OTTMERS- FREDERICKSBURG, TX BRED BY:
OWNED BY: LAYNA OTTMERS, FREDERICKSBURG, TX
OWNED BY: CREIGHTON SMITH, GEORGETOWN, KY
WARREN SMITH, GEORGETOWN, KY
SOPHIA SMITH, GEORGETOWN, KY
CLARK SMITH, GEORGETOWN, KY
BY: RYLAN HINES, MAGNOLIA, KY
OWNED BY: KADE SWIGART, FARMER CITY, IL
KORBIN SWIGART, FARMER CITY, IL
NORA CAVE- ELKIN, NC BRED BY:
OWNED BY: CODY LYON, ENNICE, NC
1906
1907
OWNED BY: NATALIE PITSTICK, SOUTH SOLON, OH
EMMA PITSTICK, SOUTH SOLON, OH
OWNED BY: MCKENNA ROGERS, SOLON, IA MORGAN ROGERS, SOLON, IA
OWNED BY: ELAINA WALSH, GODFREY, IL
OWNED BY: CRUZ COLYER, BRUNEAU, ID
OWNED BY: CORBIN MICHAEL FINK, WAMEGO, KS CANAAN AUSTIN FINK, WAMEGO, KS
OWNED BY: THOMAS KADE BOATMAN, ROCKFORD, IL
TAYLOR KENDALL BOATMAN, ROCKFORD, IL
OWNED BY: TESSA BOOCO, HAYDEN, CO
OWNED BY: KASHLYN KREBS, GORDON, NE
KYNSLEIGH KREBS, GORDON, NE
OWNED BY: JACE MURPHREE, HAMILTON, TX
OWNED BY: LANEY STEPHENS, WEST SALEM, IL
1916 2/20/2024 EXR BAILEES MCKEE 4215
OWNED BY: VIVIAN LOU THOMPSON, TROY, AL
1917 2/19/2024 CRUTCHERS VICKY 4106 ET
OWNED BY: SHAWN CRUTCHER, MONTROSE, IL
1918 2/19/2024 H BL CARMEL M376 ET 44587229 HL STIMULUS
OWNED BY: GIANNA MARINO, CLARENCE CENTER, NY
1919 2/19/2024
OWNED BY: JACKSON MASSEY, PIKEVILLE, TN
OWNED BY: JORDAN MITCHEM, VALE, NC
OWNED BY: MAKENNA SMITH, HUBERTUS, WI TESSA SMITH, HUBERTUS, WI
1922 2/19/2024
OWNED BY: NORA LEIGH WERK, MANHATTAN, KS
OWNED BY: FAITH BENEDICT, DEWEY, IL
OWNED BY: SARAH GRACE BIRDSALL, TORRINGTON, WY
SAMUEL C BIRDSALL, TORRINGTON, WY
SD BRED BY:
OWNED BY: MORGAN FIRLUS, WONEWOC, WI
OWNED BY: BRODY GREENWOOD, HAMILTON, KS
1927 2/18/2024
OWNED BY: MAKAYLA MASSEY, LONDON, KY
1928 2/17/2024 WILDCAT PHYLLIS 4012
OWNED BY: TESSA EVERHART, MORRISTOWN, IN
OWNED BY: OLIVIA ULLOM, PROSPERITY, PA
BY: DOROTHY MARIE DEFORD, JARRETTSVILLE, MD
OWNED BY: MACY MICHELINI, PERU, IL
OWNED BY: SAYLOR NORVELL, TUTTLE, OK MADILYN NORVELL, TUTTLE, OK
1935
OWNED BY: MADYSON RASMUSSEN, SPRING VALLEY, WI
KENNADY RASMUSSEN, SPRING VALLEY, WI
JACK RASMUSSEN, SPRING VALLEY, WI
JAYDEN SIMPSON- ROACHDALE, IN BRED BY:
OWNED BY: JAYDEN SIMPSON, ROACHDALE, IN
1936 2/16/2024 WF 9444 MISS ACHIEVA 124E 19M
RV VALOR 9444G ET 0.5 56 21 83 MIA WALSH- MURDOCK, MN BRED BY:
OWNED BY: ADELYN WALSH, DEGRAFF, MN
1937 2/15/2024
MEAD FARMS- BARNETT, MO BRED BY:
OWNED BY: JACOB BALL, ORO-MEDONTE, ON
1938 2/15/2024
OWNED BY: CREW CUMMINS, HOLLIS, OK CARA CUMMINS, HOLLIS, OK
1939
OWNED BY: CORBIE GREEN, ELSIE, MI
OWNED BY: ELLA KNIGHT, NEWTON GROVE, NC
OWNED BY: SHELBY SIEMER, SIGEL, IL
OWNED BY: MADISON BAUER, BONFIELD, IL
OWNED BY: BRAXTON CARPER, VEVAY, IN
OWNED BY: EMMA DAVISSON, CALAMUS, IA
OWNED BY: MADDIE JENKINS, ATHENS, TX
1946 2/14/2024 KJ 889H CHER 473M 44576968 UPS HARVESTER
OWNED BY: LUTE JUDY, OTTUMWA, IA
1947 2/14/2024 BK MAKIN JAM 4301M 44580790 BK RED RIVER H18
OWNED BY: MATTIE MELENDREZ, DIXON, IL
1948 2/13/2024 GKB 229G MIRAGE M108 ET
OWNED BY: REESE ANDERSON, ALPHA, MN
OWNED BY: BRAXTON CARPER, VEVAY, IN BARRETT CARPER, VEVAY, IN
GREEN JCS MAKERS MARK 229G
BY: KYLER COOLEY, DRY CREEK, LA
OWNED BY: DANICA RHOADS, CHRISMAN, IL
BY: SADIE ZAENGER,
ELLA ELIZABETH DEFORD, JARRETTSVILLE, MD
BY: LUKE HAMLIN, WEATHERFORD, TX
OWNED BY: NOLAN F LEE, WELLINGTON, IL
OWNED BY: GUNNER WHITEHEAD, TOWNSEND, DE
1957 2/9/2024 JBC 2317 88X LORELAI 429
OWNED BY: CORA BELLE CHAPMAN, SENECA, IL
1958 2/9/2024 SHR 2078 BROOKLYN 4081 44586068 LAND SHR
OWNED BY: CRUZ COLYER, BRUNEAU, ID
1959 2/9/2024 GGSC CAROLINE 6M ET
KLD RW
OWNED BY: DOROTHY MARIE DEFORD, JARRETTSVILLE, MD
1963
OWNED BY: LOGAN CADY, NEW WINDSOR, MD
OWNED BY: LAUREN JONES, DARLINGTON, WI NICOLAS JONES, DARLINGTON, WI
BRADY JONES, DARLINGTON, WI
BY: JACKSON MASSEY, PIKEVILLE, TN
OWNED BY: JAYNA BLUME, PIERRE, SD
PIERRE, SD
OWNED BY: ALEXSYS HAMMOND, KINMUNDY, IL
1967
OWNED BY: ATLEY KLEINMAN, WENTWORTH, MO
OWNED BY: BIANCA BEVAN, PLATTEVILLE, WI MYA C BEVAN, PLATTEVILLE, WI
1968
OWNED BY: LANE CADY, NEW WINDSOR, MD LOGAN CADY, NEW WINDSOR, MD
1969
OWNED BY: MATILDA GERVAIS, SUTTON, MA
KEVIN D JENSEN- COURTLAND, KS
OWNED BY: SCOTT HICKEY, STAUNTON, VA
GARRETT HICKEY, STAUNTON, VA
TODD- KIM & KASEY HERMAN, LIMA BRED BY:
OWNED BY: PIPER SEISS, THURMONT, MD
OWNED BY: MAX MCGUNEGILL, JASPER, MN
OWNED BY: KAEGAN O'LEARY, WEATHERFORD, TX
OWNED BY: HESS FOWLER, CARNESVILLE, GA
OWNED BY: DIANA KATE GILLOOLY, WADLEY, GA
OWNED BY: ELLA KNIGHT, NEWTON GROVE, NC
OWNED BY: RHETT LEHMAN, SULLIVAN, IL
KENT LEHMAN, SULLIVAN, IL ELLIE LEHMAN, SULLIVAN, IL
OWNED BY: HARPER ROSE STARNES, FORT PAYNE, AL
OWNED BY: AVERY STITZLEIN, GLENMONT, OH
1982 2/2/2024
BY: JULIE TROYER, PYLESVILLE, MD
OWNED BY: HUCK GRAY, KNIGHTSTOWN, IN
OWNED BY: ALLYSON HAMILTON, ATLANTA, TX
1987 2/1/2024 QM KASHS
OWNED BY: WYATT MCINTYRE, LEEDEY, OK
QUAID MCINTYRE, LEEDEY, OK
OWNED BY: EMERSON WALSH, DEGRAFF, MN OLIVIA WALSH, DEGRAFF, MN
OWNED BY: BRAYSON MAYO, SCOTT CITY, KS
OWNED BY: CALLIE F SCHMIDT, BLUE RAPIDS, KS
OWNED BY: JD SEWARD, ROCKVILLE, IN
OWNED BY: ADALYNN GRACE BLANKENSHIP, WEST BURLINGTON, NY
1993 1/29/2024 K7 234 LASS 2412 44548943
OWNED
MCKENNA GATZ, FAIRVIEW, KS LAUREN GATZ, FAIRVIEW, KS
OWNED BY: MADDIE JENKINS, ATHENS, TX
OWNED BY: GARRISON SIEDLING, BROOKVILLE, IN ISAAC SIEDLING, BROOKVILLE, IN ROSS SIEDLING, BROOKVILLE, IN
BRAYLEN TAYLOR- ALEXANDRIA, KY BRED BY:
BY: BRAYLEN TAYLOR, ALEXANDRIA, KY
IOLA,
OWNED BY: WILLIAM TACKETT, IOLA, TX
OWNED BY: KINSLEY JEAN GILLIG, BLUE RAPIDS, KS
OWNED BY: CALLY MILLER, EL DORADO, KS CAMI MILLER, EL DORADO, KS
2000 1/26/2024 GKB K102 LADY HAWK 4044
OWNED BY: CARA CUMMINS, HOLLIS, OK CREW CUMMINS, HOLLIS, OK
2001 1/26/2024 HWW WCW MARILYN 1M
GKB
OWNED BY: HARLEE WREN WATSON, FLEMINGSBURG, KY WYATT WATSON, FLEMINGSBURG, KY
OWNED BY: CLAY LAWRENCE, KITE, GA
BY: CONNER JAMES MCQUAIG, ILA, GA
OWNED BY: LOYD PERKS, SAN ANGELO, TX
OWNED BY: PAYTON ZEPP, WEST MINSTER, MD
OWNED BY: AVA DOIG, ST PAUL, IN BREMLEY DOIG, ST PAUL, IN
2007 1/23/2024 GREEN VALLEY
OWNED BY: RYLAN HINES, MAGNOLIA, KY
2008 1/22/2024 KPH CHIQUITA 1M
OWNED BY: SAWYER HAKE, EDGERTON, OH
OWNED BY: TINLEY HARVIE, OLDS, AB
LYLA HARVIE, OLDS, AB
2010 1/22/2024
COCOA 4794 ET 44562760 FTZS
OWNED BY: ALISHA KLEMME, PLYMOUTH, WI
DANICA KLEMME, PLYMOUTH, WI
2011 1/22/2024 MPH 15H BARBARA 203H 10M
OWNED BY: EMMALEE MUELLER, PERRYVILLE, MO
PHILLIP MUELLER, PERRYVILLE, MO
2012 1/21/2024 BMF YELLOWSTONES HAZEL 01M
OWNED BY: WESTYN ZEB MURPHREE, HAMILTON, TX
OWNED BY: ERICA SHUTSKY, PINNACLE, NC
OWNED BY: RYNE ALLEN, QUINCY, IL
WY
OWNED BY: HAYDEN MARIE HOFFMAN, THEDFORD, NE
BY:
OWNED BY: FORD HOWARD, DORA, MO
OWNED BY: SAYLOR NORVELL, TUTTLE, OK
OWNED BY: KATIE COX, MCNAB
OWNED BY: COLTON PETERSON, ROANOKE, IL
MOUNTAIN GROVE, MO
OWNED BY: STETSON STOREY, STOCKTON, IL
BY: JACK BEGOON, GROTTOES, VA
BY: LUKE DESALVO, MORRILTON, AR
TUCKER LAWSON, MUNFORDVILLE, KY
BY: WYATT RUSSEL, JACKSON, MO
2026
2027
2028
OWNED BY: CARTER SCHROEDER, PELLA, IA LOGAN SCHROEDER, PELLA, IA
BY:
OWNED BY: MAKENNA SMITH, HUBERTUS, WI TESSA SMITH, HUBERTUS, WI
2.5 60 31 100 ABLE ACRES- WINGATE, IN BRED BY:
OWNED BY: RAY S DUNCAN, WINGATE, IN
2029 1/13/2024
OWNED BY: JAYNA BLUME, PIERRE, SD RETT BLUME, PIERRE, SD
OWNED BY: ELLA CRANE, LASALLE, IL
2031 1/12/2024
FRIEDA BELLE 4M ET 44581021
OWNED BY: LANDON MANSFIELD, LIBERTY, TN LOGAN MANSFIELD, LIBERTY, TN
2032 1/12/2024 RW 137J MS FIREFLY ET 11M
BY: JACOB MCNAUGHTON, GRAVENHURST, ON
OWNED BY: AVERY SWEENEY, VINTON, IA
2034 1/12/2024 CW BONNIE 4002
OWNED BY: MADELYN GRACE THOMPSON, AMITY, MO BRYNLEE ANN THOMPSON, AMITY, MO
OWNED BY: MACALIE FORREST, FOSTER, RI
2036
BRED BY:
JAKE THOMPSON- MAPLE PARK, IL
OWNED BY: RYAN TAMMARO, CAPE ELIZABETH, ME
2037
OWNED BY: GARRETT HICKEY, STAUNTON, VA SCOTT HICKEY, STAUNTON, VA
2038 1/8/2024
OWNED BY: SPENCER SCHMIDT, BLUE RADIDS, KS
2039
OWNED BY: ISABELLA HEWITT, BRANCHVILLE, NJ
OWNED BY: TIMBER HULA, CRESTON, NE
OWNED BY: CONNER JAMES MCQUAIG, ILA, GA
OWNED BY: TR PUTZ, OTLEY, IA
COLBY PUTZ, OTLEY, IA DAX PUTZ, OTLEY, IA
OWNED BY: BELLA PRESSNALL, RANDOLPH, MN
OWNED BY: HARRISON ROBERTS, WILLIAMSBURG, MA
OWNED BY: KAYLIE NICOLE SHELTON, LEROY, IL
OWNED BY: MYA C BEVAN, PLATTEVILLE, WI BIANCA BEVAN, PLATTEVILLE, WI
2048 1/3/2024
OWNED BY: BRAXTON CARPER, VEVAY, IN
2049 1/3/2024 DJF WAVERLYS WHITEY 3M
OWNED BY: ALLYSON HAMILTON, ATLANTA, TX MALLORY HAMILTON, ATLANTA, TX
JR LADY
OWNED BY: CODY KNAUS, ACME, WA
2051 1/3/2024 BACC 953
OWNED BY: QUINTON RAY, BROOKSVILLE, KY
HARPER RAY, BROOKSVILLE, KY
ANDREW RAY, BROOKSVILLE, KY
OWNED BY: GABRIEL SWALLOW, GARLAND, TX
OWNED BY: BRAYLEN TAYLOR, ALEXANDRIA,
BY: ELAINA WALSH, GODFREY, IL
BY: KALEIGH MCNAUGHTON, GRAVENHURST, ON
MEDONTE HIGHLANDS PLD HFDS- MISSISSAUGA, ON BRED BY:
OWNED BY: GARTH MCINTYRE, GRAVEHURST, ON
2057
OWNED BY: HUCK GRAY, KNIGHTSTOWN, IN
OWNED BY: NATALIE PITSTICK, SOUTH SOLON, OH
OWNED BY: LAYTON REAMES, CULPEPER, VA
BY: CONNER JAMES MCQUAIG, ILA, GA
OWNED BY: JASE BELTZ, CANTON, KS JOSIE BELTZ, CANTON, KS
OWNED BY: JACE MURPHREE, HAMILTON, TX
OWNED BY: JACOB FISCUS, OBLONG, IL
OWNED BY: JOSEPH SCHOHR, OROVILLE, CA
2065 12/12/2023 THM CHAP 4207
NJW 11B AUTHORIZE 79G ET 1.7 64 19 106
H MEAD JR- MIDVILLE, GA
OWNED BY: BRAYLEN TAYLOR, ALEXANDRIA, KY ROWAN TAYLOR, ALEXANDRIA, KY
2066
2067
OWNED BY: BROOKE AUE, AUBURNDALE, WI
ELAYNA AUE, AUBURNDALE, WI
BREANNA AUE, AUBURNDALE, WI
JANE YOUNG- SPRINGVILLE, TN BRED BY:
OWNED BY: PAISLEE JANE YOUNG, SPRINGVILLE, TN
OWNED BY: RHETT
OWNED BY: MATTIE BROOKE HOLT, MANTACHIE, MS
JALEN NICHOLE HOLT, MANTACHIE, MS
OWNED BY: SCOTT HICKEY, STAUNTON, VA
GARRETT HICKEY, STAUNTON, VA
OWNED BY: SAYLOR NORVELL, TUTTLE, OK
OWNED BY: MARY ELLIOTT MARTIN, AUBURN, AL
OWNED BY: ELLIE POARCH, LEWISBURG, TN
MAELEE POARCH, LEWISBURG, TN
OWNED BY: EVAN JACKSON, HOLLADAY, TN
OWNED BY: RIANNA KATHRYN CHANEY, KEYMAR, MD
SHERIDAN ELIZABETH CHANEY, KEYMAR, MD
2076
OWNED BY: SAMANTHA LYNN CAMPBELL, EATON, CO
2077
OWNED BY: KOLTER STITHEM, FREDONIA, KS JACE STITHEM, FREDONIA, KS
2078
OWNED BY: DREW BALLARD, INMAN, KS MARLEE BALLARD, INMAN, KS
2079
OWNED BY: LUKE DESALVO, MORRILTON, AR
OWNED BY: ABIGAIL SMITH, STROUDSBURG,
OWNED BY: MARLEE GRANNIS, FLEMINGSBURG, KY
OWNED BY: KYLEE SADLER, TRYON, OK KYNDAL SADLER, TRYON, OK
2084 11/14/2023 DF ACD LAINEY
OWNED BY: ADDISON DUIS, PETERSBURG, IL
OWNED BY: HAYDEN HELMS, HOLBROOK, NE KYLAN HELMS, HOLBROOK, NE
2086
OWNED BY: LINDIE HELSINGER, GERMANTOWN, OH GRANT HELSINGER, GERMANTOWN, OH
2087
OWNED BY: AMBERLYN CHRISTENBURY, STARR, SC
2088
OWNED BY: TILLMAN STALEY, PETERSBURG, TN
2089
OWNED BY: HALLIE HUGHES, KNOB LICK, KY
2090 11/4/2023
OWNED BY: KYLER COOLEY, DRY CREEK, LA
OWNED BY: JACKSON MASSEY, PIKEVILLE, TN
2092
OWNED BY: MARISSA PERKINS, NORTH STONINGTON, CT
MOLLY PERKINS, NORTH STONINGTON, CT
OWNED BY: WILLIE BOYETTE, ANGIE, LA
2094
BY: CONNER JAMES MCQUAIG, ILA, GA
BY: BEAU PHILLIP KNIGHT, COMER, GA
2096
OWNED BY: LINDIE HELSINGER, GERMANTOWN, OH GRANT HELSINGER, GERMANTOWN, OH
2098
OWNED BY: TANA HARVILLE, LEBANON, TN
10/29/2023
OWNED BY: ELLIE POARCH, LEWISBURG, TN
MAELEE POARCH, LEWISBURG, TN
OWNED BY: LANDON FIX, SHELBYVILLE, IN BRILEY FIX, SHELBYVILLE, IN
OWNED BY: WILLIAM MEINHARDT, ONAGA, KS
RYLIE MEINHARDT, ONAGA, KS
OWNED BY: CORBIN PERRY, TOWER HILL, IL
CADEN PERRY, TOWER HILL, IL
OWNED BY: LUKE FISHER, BON AQUA, TN
2104
OWNED BY: GRANT WATERS, NORBORNE, MO
KRISTIN WATERS, NORBORNE, MO
OWNED BY: HAYDEN HELMS, HOLBROOK, NE
KYLAN HELMS, HOLBROOK, NE
2105
OWNED BY: LANDRY ALLAN, NOCONA, TX
2106
SKEET'S FARM LLC- BOGALUSA, LA
OWNED BY: WILLIE BOYETTE, ANGIE, LA
2107
OWNED BY: GAVIN RHODE, STEWARTSVILLE, MO ISAAC RHODE, STEWARTSVILLE, MO
2108
OWNED BY: CLAYTON HAYES, ADA, OK
2109
OWNED BY: LEXA JUKES, SWAINSBORO, GA
2110
OWNED BY: LEXA JUKES, SWAINSBORO, GA
OWNED BY: AARON SHRIVER, GRAFTON, WV
2112 10/8/2023
OWNED BY: JACKSON MASSEY, PIKEVILLE, TN
2113
BY: ASHLEY TUTWILER, MOUNT SIDNEY, VA
OWNED BY: HARPER ROSE STARNES, FORT PAYNE, AL
2115
OWNED BY: LEVI WOMACK, PEMBROKE, KY
2116
2117
OWNED BY: EMILEA GREATHOUSE, GANDEEVILLE, WV
2118 10/5/2023 RER Z75 ENDURES LADY 344L
OWNED BY: QUAID MCINTYRE, LEEDEY, OK WYATT MCINTYRE, LEEDEY, OK
2119
10/5/2023
OWNED BY: CADEN PERRY, TOWER HILL, IL CORBIN PERRY, TOWER HILL, IL
2120
2121
OWNED BY: EMMA PITSTICK, SOUTH SOLON, OH
NATALIE PITSTICK, SOUTH SOLON, OH
OWNED BY: WILLIAM TACKETT, IOLA, TX
OWNED BY: CHARLEIGH BIRDSELL,
OWNED BY: ELLA BROOKS, PROPHETSTOWN, IL
2126
2127
OWNED BY: ELLA ELIZABETH DEFORD, JARRETTSVILLE, MD
2128
OWNED BY: EVERLY FOSTER, NILES, MI
2129 9/28/2023
OWNED BY: HOYT LAWRENCE, KITE, GA
OWNED BY: HAYES DEVINE, CHICKASHA, OK KENDALL DEVINE, CHICKASHA, OK
OWNED BY: MONTANA KENADY, PLAINVILLE, IL
2132 9/24/2023
OWNED BY: WYATT RUSSEL, JACKSON, MO
2133 9/23/2023 SIS BAMBI 260A
BY: CAITLYN EDWARDS, SANTA FE, TX
2134
OWNED BY: JESSICA MEZRANO, COLUMBIANA, AL
2135
OWNED BY: CALLIE HARRIS, CANTON, TX
2136
OWNED BY: PEYTON PEREZ, TEXLINE, TX LIBBY PEREZ, TEXLINE, TX
2137
2138
HARR- JEROMESVILLE, OH BRED BY:
OWNED BY: NATALIE LISTON, SEVILLE, OH
NATHAN LISTON, SEVILLE, OH
OWNED BY: SALEM EMALINE SIFFORD, GOLDVEIN, VA
SEDONA SIFFORD, GOLDVEIN, VA
OWNED BY: NATALIE PITSTICK, SOUTH SOLON, OH EMMA PITSTICK, SOUTH SOLON, OH
2140 9/15/2023
OWNED BY: NOLAN ATLAS BEAVER, GRANDVIEW, TX
2142
OWNED BY: CARLY KOLTERMAN, GARLAND, NE
MICHAEL KOLTERMAN, GARLAND, NE
MAREN KOLTERMAN, GARLAND, NE
OWNED BY: DIANA KATE GILLOOLY, WADLEY, GA
2143
OWNED BY: JALEN NICHOLE HOLT, MANTACHIE, MS
BY: LAYTON REAMES, CULPEPER, VA
OWNED BY: MORGAN RILEY, COLLEGE GROVE, TN
2146
OWNED BY: ADDIE BOURGEOIS, OPELOUSAS, LA
2147
2148
OWNED BY: SYDNEY BETES, MOSES LAKE, WA
ADELINA BETES, MOSES LAKE, WA
OWNED BY: LUKE FISHER, BON AQUA, TN
2149
OWNED BY: SEDONA SIFFORD, GOLDVEIN, VA
SALEM EMALINE SIFFORD, GOLDVEIN, VA
OWNED BY: VIVIAN LOU THOMPSON, TROY, AL
OWNED BY: BO TODD, MOUNT VERNON, KY
ELLEN TODD, MOUNT VERNON, KY
OWNED BY: GRADY CARTER, STRATFORD, OK HUDSON CARTER, STRATFORD, OK
OWNED BY: PARKER IRWIN, HARTSHORNE, OK
OWNED BY: GARRETT HICKEY, STAUNTON, VA SCOTT HICKEY, STAUNTON, VA
OWNED BY: CLAIBORNE PERRY, MADISON, MS
2156
OWNED BY: DIANA KATE GILLOOLY, WADLEY, GA
2157
OWNED BY: MARY HANNAH GULLATT, SALEM, AL
2158
OWNED BY: SAMANTHA LYNN CAMPBELL, EATON, CO
2159
OWNED BY: EMMA HANCOCK, BOLIVAR, MO
2160 9/4/2023 KJ 746D COCO
OWNED BY: PAIGE LEMENAGER, HUDSON, IL
2161 9/4/2023
OWNED BY: ANNAGAIL SALLEE, LAWRENCEBURG, KY
2162
OWNED BY: AUGUSTIN BURWELL, ZANESVILLE, OH
EVALYNN BURWELL, ZANESVILLE, OH
2163
OWNED BY: BENTON MCCLANAHAN, WAVERLY, TN BRADEN MCCLANAHAN, WAVERLY, TN
JENSEN- COURTLAND, KS BRED BY:
OWNED BY: MAKENNA SMITH, HUBERTUS, WI TESSA SMITH, HUBERTUS, WI
2165 9/1/2023 GREEN 6033 RITA 026L ET 44558431 BR CHARLES HUTTON 6033 3.6 66 26 106
GE_EPDs STEVEN W GREEN- MUNFORDVILLE, KY BRED BY:
OWNED BY: BO TODD, MOUNT VERNON, KY ELLEN TODD, MOUNT VERNON, KY
2166
OWNED BY: EMMIE WHITE, SPRINGFIELD, TN
2167
OWNED BY: ADDISON ACHESON, HOPE, KS KINSEY ACHESON, HOPE, KS
2168 8/28/2023 DCF
OWNED BY: MICHAEL MEZRANO, COLUMBIANA, AL
2169 8/25/2023 HOFFMAN
OWNED BY: HAXTON HAROLD HOFFMAN, THEDFORD, NE HAYDEN MARIE HOFFMAN, THEDFORD, NE KENNEDY JEAN HOFFMAN, THEDFORD, NE
OWNED BY: MASON ROEDER, SEGUIN, TX
OWNED BY: GRADY CARTER, STRATFORD, OK
HUDSON CARTER, STRATFORD, OK
OWNED BY: AUBREY LANDRUM, HUNTINGTON, IN BAILEY LANDRUM, HUNTINGTON, IN
OWNED
BY: VIVIAN LOU THOMPSON, TROY, AL
Placing / Entry / Name
2176
OWNED BY: JULIA STUDER, FRANKFORT, KS
JACQUELINE STUDER, FRANKFORT, KS
JOHANNA STUDER, FRANKFORT, KS
CAROLINE STUDER, FRANKFORT, KS
Grand Champion Owned Polled Female
Reserve Grand Champion Owned Polled Female
From classes: 007


















Cow-Calf Pair Show











Champion Bred-and-Owned Cow-Calf Pair _________________________________________________________________________
Reserve Champion Bred-and-Owned Cow-Calf Pair __________________________________________________________________
Champion Owned Cow-Calf Pair __________________________________________________________________________________
Reserve Champion Owned Cow-Calf Pair ___________________________________________________________________________ Steer Show
Division 1 Champion Steer
Division 1 Reserve Champion Steer ________________________________________________________________________________
Division 2 Champion Steer



Division 2 Reserve Champion Steer ________________________________________________________________________________
Division 3 Champion Steer
Division 3 Reserve Champion Steer ________________________________________________________________________________
Division 1 Champion Bred-and-Owned Steer ________________________________________________________________________
Division 1 Reserve Champion Bred-and-Owned Steer _________________________________________________________________
Division 2 Champion Bred-and-Owned Steer ________________________________________________________________________
Division 2 Reserve Champion Bred-and-Owned Steer ________________________________________________________________
Division 3 Champion Bred-and-Owned Steer ________________________________________________________________________
Division 3 Reserve Champion Bred-and-Owned Steer ________________________________________________________________ Bred-and-Owned Bull Show
Division 1 Champion Bred-and-Owned Bull _________________________________________________________________________
Division 1 Reserve Champion Bred-and-Owned Bull __________________________________________________________________
Division 2 Champion Bred-and-Owned Bull _________________________________________________________________________
Division 2 Reserve Champion Bred-and-Owned Bull __________________________________________________________________
Division 3 Champion Bred-and-Owned Bull _________________________________________________________________________
Division 3 Reserve Champion Bred-and-Owned Bull __________________________________________________________________



Division 4 Champion Bred-and-Owned Bull _________________________________________________________________________
Division 4 Reserve Champion Bred-and-Owned Bull __________________________________________________________________
Division 5 Champion Bred-and-Owned Bull _________________________________________________________________________
Division 5 Reserve Champion Bred-and-Owned Bull __________________________________________________________________ Bred-and-Owned Female Show
Division 1 Champion Bred-and-Owned Female ______________________________________________________________________
Division 1 Reserve Champion Bred-and-Owned Female _______________________________________________________________
Division 2 Champion Bred-and-Owned Female ______________________________________________________________________
Division 2 Reserve Champion Bred-and-Owned Female _______________________________________________________________
Division 3 Champion Bred-and-Owned Female ______________________________________________________________________
Division 3 Reserve Champion Bred-and-Owned Female _______________________________________________________________
Division 4 Champion Bred-and-Owned Female ______________________________________________________________________
Division 4 Reserve Champion Bred-and-Owned Female _______________________________________________________________
Division 5 Champion Bred-and-Owned Female ______________________________________________________________________
Division 5 Reserve Champion Bred-and-Owned Female _______________________________________________________________
Division 6 Champion Bred-and-Owned Female ______________________________________________________________________
Division 6 Reserve Champion Bred-and-Owned Female _______________________________________________________________



Division 7 Champion Bred-and-Owned Female ______________________________________________________________________
Division 7 Reserve Champion Bred-and-Owned Female _______________________________________________________________
Division 8 Champion Bred-and-Owned Female ______________________________________________________________________
Division 8 Reserve Champion Bred-and-Owned Female _______________________________________________________________
Division 9 Champion Bred-and-Owned Female ______________________________________________________________________
Division 9 Reserve Champion Bred-and-Owned Female _______________________________________________________________
Division 10 Champion Bred-and-Owned Female _____________________________________________________________________
Division 10 Reserve Champion Bred-and-Owned Female ______________________________________________________________





















Horned Female Show










Division 1 Champion Horned Female _______________________________________________________________________________
Division 1 Reserve Champion Horned Female ________________________________________________________________________
Division 2 Champion Horned Female _______________________________________________________________________________
Division 2 Reserve Champion Horned Female _______________________________________________________________________
Division 3 Champion Horned Female ______________________________________________________________________________
Division 3 Reserve Champion Horned Female _______________________________________________________________________
Division 4 Champion Horned Female ______________________________________________________________________________



Division 4 Reserve Champion Horned Female _______________________________________________________________________
Division 5 Champion Horned Female ______________________________________________________________________________
Division 5 Reserve Champion Horned Female _______________________________________________________________________
Division 6 Champion Horned Female ______________________________________________________________________________
Division 6 Reserve Champion Horned Female _______________________________________________________________________
Division 7 Champion Horned Female _______________________________________________________________________________
Division 7 Reserve Champion Horned Female _______________________________________________________________________
Division 8 Champion Horned Female ______________________________________________________________________________
Division 8 Reserve Champion Horned Female _______________________________________________________________________
Polled Female Show
Division 1 Champion Polled Female ________________________________________________________________________________
Division 1 Reserve Champion Polled Female _________________________________________________________________________
Division 2 Champion Polled Female ________________________________________________________________________________
Division 2 Reserve Champion Polled Female ________________________________________________________________________
Division 3 Champion Polled Female ________________________________________________________________________________
Division 3 Reserve Champion Polled Female ________________________________________________________________________



Division 4 Champion Polled Female ________________________________________________________________________________
Division 4 Reserve Champion Polled Female ________________________________________________________________________
Division 5 Champion Polled Female ________________________________________________________________________________
Division 5 Reserve Champion Polled Female ________________________________________________________________________
Division 6 Champion Polled Female ________________________________________________________________________________
Division 6 Reserve Champion Polled Female ________________________________________________________________________
Division 7 Champion Polled Female ________________________________________________________________________________
Division 7 Reserve Champion Polled Female ________________________________________________________________________
Division 8 Champion Polled Female ________________________________________________________________________________
Division 8 Reserve Champion Polled Female ________________________________________________________________________
Division 9 Champion Polled Female ________________________________________________________________________________
Division 9 Reserve Champion Polled Female ________________________________________________________________________
Division 10 Champion Polled Female _______________________________________________________________________________
Division 10 Reserve Champion Polled Female
Division 11 Champion Polled Female _______________________________________________________________________________
Division 11 Reserve Champion Polled Female ________________________________________________________________________
Division 12 Champion Polled Female



Division 12 Reserve Champion Polled Female ________________________________________________________________________
Division 13 Champion Polled Female _______________________________________________________________________________
Division 13 Reserve Champion Polled Female ________________________________________________________________________
Division 14 Champion Polled Female _______________________________________________________________________________
Division 14 Reserve Champion Polled Female ________________________________________________________________________
Division 15 Champion Polled Female
Division 15 Reserve Champion Polled Female ________________________________________________________________________














